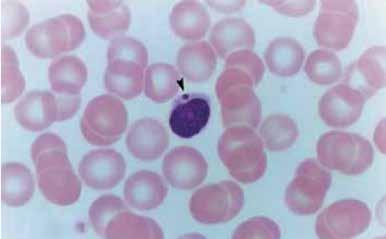

ISSN 1318-1777


ISSN 1318-1777

Rastlinska hrana bistveno poveča raznovrstnost mikrobov
Kip naj bi se premikal tudi pred slovensko osamosvojitveno vojno
Molekularni vodik pride kamorkoli v telo in uravnava zdravje
Stik z delfini prinese notranji mir, srečo, ljubezen, radost življenja, samoozdravitve



POTI DO ZDRAVJA
Knjiga zajema sto resničnih zgodb Slovencev, ki so v iskanju izgubljenega zdravja in ravnovesja našli rešitev v različnih oblikah alternativne medicine, samozdravljenja in v klasični ortodoksni medicini. 29,90 €
10 %

PRIROČNIK ZA BOGOVE
Avtor, ki je že leta 2019 vedel za načrt o koroni, piše, da se svetovni mogočneži bojijo, da ne bi odkrili njihovih mahinacij; svojo moč pa bodo izgubili, ko bomo odkrili veliko moč v nas. 29,90 €
popusta imajo naročniki na revijo
Misteriji na vse izdelke, ki so naprodaj prek revije ali spletne trgovine.


NE UMIRATE, LE PREBUJATE SE
Morda ste nezadovoljni z življenjem, imate občutek, da del vas umira ... Ne umirate. Le prebujate se. Knjiga je opomnik vaše duše, kako močni ste. Stopite višje, zaživite na polno.. 24,90 €

LJUBEZEN DUŠE
Knjiga proučuje načrtovanje izzivov, povezanih s partnerskimi odnosi oziroma ljubezenskimi razmerji. Razkriva mogočno modrost in ljubezen iz onstranstva ter pojasnjuje, zakaj pred rojstvom načrtujemo takšne izkušnje. 24,90 €

100 VPRAŠANJ IN ODGOVOROV O SRČNEM POPUŠČANJU
Srčno popuščanje, ki že postaja epidemija, je resno stanje, vendar lahko za obvladanje te bolezni ali vsaj omilitev njenih učinkov veliko storimo sami. 19,90 €

KAKO UPOČASNIMO STARANJE S HRANO (1. DEL) V celicah našega telesa obstaja enajst poti staranja in vsako lahko prekinemo. Knjiga ponuja znanstvene dokaze o upočasnitvi učinkov staranja ter praktične strategije za doseganje vrhunske dolgoživosti. 24,90 €

POZDRAVITE SI RAKA
Knjiga ponuja življenjski slog brez rakavih bolezni. Metoda sedmih korakov nam pomaga prekrmariti raka in vse njegove vzroke; z njo lahko pospešimo okrevanje na načine, ki jim zlahka sledimo. 19,90 €

KAKO LAHKO DOBRO ŽIVIMO S SRČNIM POPUŠČANJEM Medicinska novinarka je po ozdravljenem srčnem popuščanju napisala knjigo, da množici obolelih pojasni, kaj je srčno popuščanje, kako naj skrbijo zase in kako naj jim pomagajo domači. 24,90 €

KAKO UPOČASNIMO STARANJE S HRANO (2. DEL)
Drugi del te knjige razlaga, kako lahko ohranimo svoje kosti, prebavila, krvni obtok, lase, sluh, sklepe, mišice, kožo, zobe, vid, razum in nazadnje dostojanstvo ob smrti. 29,90 €

SVETLOBA – ZDRAVILO PRIHODNOSTI
Zdravniki že začenjajo ceniti zdravilno moč svetlobe. S pravilno izbrano svetlobo lahko omilimo žalost, zmanjšamo stres, preženemo spolne motnje, podaljšamo življenje … 24,90 €

LEPO UMIRANJE
Večini je važnejša kakovost življenja in tudi smrti; da ne bi preobremenjevali svojcev, da bi umrli doma, da bi se duhovno umirili. Knjiga je praktični vodnik za lep zaključek življenja. 24,90 € 18,67 €

100 VPRAŠANJ IN ODGOVOROV O LIMONAH
Limone imajo številne spoštovanja vredne hranilne in zdravilne lastnosti, so pa tudi odličen dodatek za nego telesa in dóma. Dodanih je tudi veliko receptov z limonami. 21,90 €

KAJ ZDRAVIMO Z MEDOM Skozi 110 vprašanj in odgovorov izvemo, kdaj je med lahko tudi strupen, kako si lahko pomagajo z medom sladkorni bolniki, pa rakavi bolniki, kako med pomaga pri izpadanju zob, nespečnosti ... 14,90 €

POGOVARJANJE Z DUHOVI Knjiga nas poleg dobrih zgodb pouči, kako razvijemo lastno prakso povezovanja z duhovi: različne vrste duhov, kako jih prepoznamo, kako se sporazumevamo z njimi in pri tem ostanemo varni. 24,90 €
OPRAVIČILO Glede na 5. člen Zakona o enotni ceni knjige vas obveščamo, da so popusti, ki so veljali za nakup knjig naše ARA založbe (pa tudi drugih založnikov) tri desetletja izdajanja revije Misteriji, omejeni. Novi zakon nam prepoveduje kakršno koli znižanje cene knjige prvih šest mesecev po izidu. Ko je knjiga stara šest mesecev, o njej spet odločamo mi in ne država. Uredništvo
32 - ŠT. 376 november 2024
napoveduje vojne
Kip naj bi se premikal tudi pred slovensko osamosvojitveno vojno
Molekularni vodik pride

porodne babice
Stik z delfini prinese notranji mir, srečo, ljubezen, radost življenja, samoozdravitve







11
Zdravje se začne v črevesju
Rastlinska hrana bistveno poveča raznovrstnost mikrobov
37
Blagodejni stiki s pokojnimi
Ko se javijo umrli (2): Raziskave sporočil iz duhovnega sveta
39
Vplivi planetarnih sprememb
Mundana astrologija (2): Umetno ustvarjeni družbeni programi nas vodijo v trpljenje
Ilustrirana mesečna revija na robu medicine in drugih znanosti
Naslov uredništva: Revija Misteriji, Cigaletova 5, 1000 Ljubljana
Tel.: 01/231 93 60
E-naslov: info@misteriji.si
Izdaja: ARA založba d.o.o., Cigaletova 5, Ljubljana
Odgovorni urednik: Jože Vetrovec joze@misteriji.si
Likovni in tehnični urednik: Janko Blagojević, janko@ararevija.si
Redaktor: Andrej Kikelj andrej@misteriji.si
Tajništvo, naročnine in oglasno trženje: Sanela Ajkić
Tel.: 01/231 93 60; 031/662 092 sanela@misteriji.si
Vodja spletne trgovine: Miha Mekinda info@misteriji.si
Prodaja po pošti:
Tel.: 01/549 17 92; 051/307 777 info@misteriji.si
Tisk: SCHWARZ PRINT d.o.o., Ljubljana
Naklada: 6100 izvodov
V tej številki Misterijev so sodelovali: Jože Vetrovec, Aleksej Metelko, Amedeja Ličen, Tatjana
Svete, Janja Kikelj, Andreja Paljevec, Dejan Vodovnik, Taja Vetrovec, Stane Padežnik
Naslovnica foto Nik Erik Neubauer
Simbol, natisnjen v levem gornjem vogalu notranje strani platnice, je zaščiten na Patentnem uradu RS.
Distribucija: EKDIS d.o.o., Vevška cesta 52, 1260 Ljubljana-Polje Cena izvoda v maloprodaji: 5,90 €
Letna naročnina s popustom: 68,00 € Polletna naročnina s popustom: 35,00 €
Poslovni račun: 02083-0011412222
Pisma bralcev
Vesela sem, da sem naročila Longy, saj je razlika v okusu vode očitna. Upam, da se bodo celice hitreje obnovile, saj imam že nekaj mesecev vnetje ob nohtih. Prosim pa vas, da pripišete odgovor na spodnja vprašanja: Ali naj vodo iz pipe natočim v kozarec tedaj, ko jo želim piti, ali naj jo pustim v njem nekaj časa, da se ogreje na sobno temperaturo in morda
Izmed novih naročnikov na revijo Misteriji bomo tudi ta mesec izžrebali srečneža, ki bo dobil za nagrado mali Polarix. Ta mesec nagrada pripada Olgici Koren Pogačar iz Lendave. Vsem novim naročnikom ta mesec podarjamo knjigo Prehrana 21. stoletja za moške.
tudi sprejme več informacij?
Mesto, kjer naj bi bil kozarec, je 170 centime-


trov oddaljeno od indukcijske plošče, 150 centimetrov od pomivalnega stroja in samo 10 centimetrov od aparata za peko kruha. Ali je mesto ustrezno?

Barbara Černe, ki je bila naša avtorica meseca v oktobru, je raziskovalna novinarka, avtorica ducata knjig o zdravju in terapevtka. Podnevi izvaja terapije in raziskuje, ponoči piše knjige. Knjige, ki so nastale pod njenim peresom, niso le odraz večletnega raziskovanja, ampak je v njih precejšen del nje same oziroma njenih življenjskih izkušenj. Te ne izliva le na papir, ampak jih že več kot deset let izvaja tudi v praksi. Svetuje mladim in starim, predvsem pa pomaga vsem, ki si želijo uravnovesiti um, telo in duha. Ukvarja se z Access bars terapijami, terapijami z Bachovimi kapljicami, njena ponudba pa obsega tudi klasične in terapevtske masaže, masaže z zelišči in masaže z medom ter druge energijske terapije. Za naročilo na terapijo ji lahko pišete na kreativa.cerne@gmail.com. Za naročnike revije Misteriji in upokojence vam bo rade volje dala tudi desetodstotni popust.

Ali naj informirano vodo pijem po požirkih, na primer po pol decilitra, ali lahko spijem poln kozarec naenkrat?
Slišala sem, da je treba občasno kozarec poslati na informiranje – kdaj in kam?
M. J., Tolmin
Voda sprejme informacije v trenutku, a je dobro, da vas čaka že natočena v kozarec.
Oddaljenost samo 10 centimetrov od aparata za peko kruha ni dobra, sevanje doseže kozarec. Postavite ga bolj stran od nje. Vodo lahko spijete iz kozarca naenkrat. Kozarca ni treba pošiljati nikamor; najbolje je, da ga po kakem letu zamenjate z novim.


založba d.o .o., Cigaletova 5, 1000 Ljubljana
založba d.o .o., Cigaletova 5, 1000 Ljubljana
: 01/23-19-360, e-pošta: info@misteriji.si
: 01/23-19-360, e-pošta: info@misteriji.si
Za zvestobo reviji Misteriji je žreb tokrat naklonil kozarec
Longy Maksu Felserju iz Radeč.
V naslednjem mesecu bomo izmed naših zvestih naročnikov izžrebali enega, ki bo za nagrado prejel informirani kozarec
Longy

Kozarec Longy
Ozdravljeni poročajo, kako so ozdraveli. Strokovnjaki predstavijo dokumentirane ozdravitve. Predavatelji posredujejo znanje Bruna Gröninga, da lahko vsakdo doživi njegovo izjavo »Neozdravljivo ne obstaja!«
Informativna predavanja, na katerih bo zdravnica E. Doggendorf iz Kroga prijateljev Bruna Gröninga predstavila njegova učenja, bodo potekala:
22. novembra ob 18. uri v Mestni občini v Novi Gorici
23. novembra ob 10. uri v gledališču Koper
23. novembra ob 15. uri v Hotelu Kras v Postojni
Vstop je prost; za več informacij pokličite na 041/777
128 ali obiščite spletišča Bruno-Groening.org/sl



SIMBOL ZA DUHOVNO MOČ – Simbol »Vodnik v zgornji svet« na zgornjem levem vogalu druge strani Misterijev vam pomaga dvigniti duhovno moč. Ustvarja duhovno polje, ki se iz revije širi v okolni prostor. Ko pa revijo prebirate, to še bolj vpliva na vas. (Simbol je avtorsko delo Franca Šturma.)
MARUČINI KRISTALI SVETUJEJO! Imate problem – rešimo ga skupaj. 040/600 487. Za naročnike Misterijev 20 % popusta.


Hypnosis studio Alen: HIPNOTERAPIJA in doseganje zunajtelesnega stanja. Odpravljanje najrazličnejših težav; pogled v preteklost, sedanjost in prihodnost. www.hypnosisstudioalen.si; 070/208 890. Za naročnike Misterijev vse 10 % ceneje.
PREGLED ŽILJA z najsodobnejšo napravo in svetovanje za odpravo težav v Novem valu. Pregled lahko tudi podarite. In imate 10 % popusta. Novi val v Ljubljani: 01/320 77 56.

Hematološke, biokemijske in imunološke PRE

ISKAVE KRVI, URINA IN BLATA v Ljubljani, Mariboru, Celju in Kopru –Adria lab, 01/436 67 71, laboratorij@adrialab.si. Naslovi odvzemnih mest: na Synlab.si. Popust: 10 % na preiskave, opravljene v Adria labu (popust ne velja na pakete).
DIAGNOSTIKA Z MINERALOGRAMOM – Ali vam manjkajo vitamini, minerali, aminokisline? Imate preveč strupov, težkih kovin, bakterij, parazitov …? Kateri so vaši najšibkejši organi? Izvid ima 37 strani, razlaga 35, nutricist pa vam vse pojasni in naredi načrt v uri in pol. Vi imate pri tem 10 % popusta. 041/328 218; klinika@futuristiclife.si.

BIOTERAPEVT ROBERT ZUPANČIČ – 10 % popusta za 1) Energijski pregled s slikanjem avre z GDV kamero, 2) Uravnovešanje čaker z elektroakupunkturo po dr. Vollu in 3) Quantec psihoenergijsko terapijo na daljavo.
Info: Robertzupancic.si




Victor Miller, kandidat za župana mesta Cheyenne v ameriški državi Wyoming, predlaga revolucionarno idejo: vodenje mesta bi lahko prevzela umetna inteligenca VIC ali »Virtualni integrirani državljan«. VIC, razvit s pomočjo ChatGPT-ja, bi hitro analiziral mestne odloke, odločal o proračunih in načrtoval infrastrukturo. Miller verjame, da bi UI lahko zmanjšal človeške napake in izboljšal učinkovitost delovanja mestne uprave. Kljub skepsi nekaterih strokovnjakov Miller vztraja, da bi VIC prinesel prihodnost pametnega vodenja mest.
VBoliviji, blizu glavnega mesta Sucre, obstaja edinstvena apnenčasta stena Cal Orck’o, ki skriva eno največjih zbirk dinozavrovih stopinj na svetu. Na steni je ohra-

njenih več kot pet tisoč odtisov, ki pripadajo vsaj osmim različnim vrstam dinozavrov – vključno z mesojedimi teropodi in velikanskimi rastlinojedimi zavropodi. Več kot 66 milijonov let stari odtisi iz obdobja pozne krede so se ohranili zaradi tektonskih premikov, ki so nekdanjo ravno pokrajino dvignili in spremenili v skoraj navpično steno.

»KANJONI« NA VINILNI PLOŠČI
Ste se kdaj vprašali, kako dejansko izgleda vinilna plošča od blizu? Pod tisočkratno povečavo se razkrije osupljiv mikroskopski svet analognega zvoka. Utori, ki omogočajo predvajanje glasbe, so videti kot sistem ogromnih kanjonov. Prav ti kanali so odgovorni za zapis zvoka na vinil, pri čemer ena stran plošče običajno vsebuje okoli dvaindvajset minut glasbe. Bi znali uganiti, kaj so v resnici temne »skale« na povečavi? Gre za drobne delce prahu.
VTurčiji so arheologi našli kameno igračo, staro kar 7500 let. Še bolj zanimivo pa je, da bi igrača lahko bila najstarejši dokaz o uporabi kolesa. Ta modelček voza s štirimi kolesi, ki so ga odkrili v okrožju Kiziltepe v turški provinci Mardin, kaže na to, da so ljudje v tem obdobju že poznali osnovne principe prevoza. In ker uradni izum kolesa sega v leto 3500 pred našim štetjem, bi to odkritje lahko spremenilo naše razumevanje o razvoju civilizacij.


JZANIMIVA DEJSTVA O ZDA (1)
• Stavba Pentagona velja za največjo stavbo na svetu.
• Aljasko so ZDA kupile od Rusije za nekaj centov za hektar.
• Ameriški muzej letalstva in vesolja »Smithsonian National Air and Space Museum« v Washingtonu je najbolj obiskan muzej v Združenih državah.

• Američani vsak dan pojedo okoli sto hektarjev pice.
• Kip svobode je bilo darilo države Francije.
• Skoraj ena tretjina Američanov je predebelih.
• Da bi preživeli noč v vseh hotelskih sobah v Las Vegasu, bi potrebovali več kot štiristo let.
• Kansas vsako leto proizvede toliko pšenice, da bi lahko dva tedna nahranil celotno svetovno prebivalstvo.
aponci imajo dolgo tradicijo časti in njihovi znanstveniki jo zopet obujajo. Zadnje opozorilo iz njihovih vrst prihaja na račun multipraktika Gatesa, kateremu očitajo, da v svoja cepiva meša snovi, ki povzročajo splav. Japonska vladna delovna skupina za kovid pa je odkrila številne dokaze še o drugih škodljivostih cepiv, kar je sramežljivo pricurljalo tudi v naše medije.
Svetovno znani strokovnjaki, kot je onkolog dr. Masanori Fukushima, pozivajo mednarodne tožilce, da Billa privedejo pred sodnike, saj škoda, ki jo ljudem povzročajo njegove človekoljubne zdravstvene organizacije, še zdaleč ni dokončna. Fukushima želi, da se po odkritju škodljivosti s tržišča umaknejo mRNA cepiva za kovid v vseh variantah. Ta cepiva imenuje »zla« in dodaja, da je njihova implementacija med človeštvo masovni poboj. S prstom kaže na Trumpovo administracijo, ki je pospešila njihovo široko uporabo z Operacijo Warp Speed, in na tiranske ukrepe, ki smo jih bili deležni med pandemijo.
Leta 2020 je striček Bill v nekem intervjuju na vprašanje, kaj misli o Trumpovi nameri o vladnih raziskavah mRNA cepiv, navrgel: »Krožijo govori-

ce, da se nekaj pripravlja v tej smeri, a morda ga bomo jaz in drugi prepričali, da se to ne izplača.«
Pohvalil se je tudi, da je v imenu Fundacije Gates lobiral pri Trumpu za takojšnje cepljenje. Priporočal mu je, naj ustavi vse raziskave o potencialni nevarnosti mRNA cepiv za kovid. Na obeh sestankih z bivšim ameriškim predsednikom je ta podvomil v neoporečnost cepiv in izrazil potrebo po dodatnih raziskavah, a je Gates rekel: »Ne, to je slepa ulica, bilo bi slabo, ne delaj tega.«
Čudna izjava za nekoga, ki je neprestano zagotavljal, kako so mRNA cepiva varna.
Kljub temu, da je Trump razmišljal o posebni komisiji, ki bi raziskala negativne učinke cepiv, in da mu je Robert Kennedy mlajši svetoval previdnost, se je zgodil Warp Speed.
Vrnimo se k Japoncem. Dr. Peter McCullough iz The Wellness Company je za Infowars povedal, da so Japonci naredili študijo, v kateri so ugotovili, da je bilo rutinsko testiranje popolnoma lažno in da so zaradi vidnih poškodb morali proizvajalcem vrniti za več kot 240 milijonov odmerkov cepiv.
Za tiste s posledicami so rezultati prepozni, a resnica se mora slišati.
Znanost in politika sta na različnih bregovih. Nova japonska vlada ne odobrava početja dr. Fukushime in kolegov ter ignorira masovne proteste; še več, že načrtuje novo »samorazmnoževalno« mRNA cepivo za kovid.
Amedeja Foto splet
Psi lajajo, karavana gre naprej.

Nasveti
dr. Michaela Gregerja (znanstveno preverjeni)
Napenjanje pri odvajanju majhnega, čvrstega blata lahko pri zaprtju povzroči nelagodje. A poleg bolečine trdo blato prispeva tudi k zdravstvenim težavam. Denimo hiatusni kili, stanju, pri katerem del želodca zdrsne navzgor in skozi prepono v prsni koš. Za tem trpi več kot eden od petih Američanov. Pri ljudeh, ki uživajo prehrano na rastlinski osnovi, pa so hiatusne kile redke. Zakaj tako velika razlika?
Ljudje, ki se prehranjujejo z rastlinsko hrano, ponavadi gladko odvajajo obilno in mehko blato. Če se med iztrebljanjem redno napenjate, lahko povečan pritisk za iztiskanje blata sčasoma dejansko potisne del želodca navzgor in ven iz trebuha. To pa povzroči refluks ali izliv kisline proti grlu in simptome, kot je zgaga. Pritiskanje na stranišču iz dneva v dan lahko povzroči tudi druge težave, vključno s hemoroidi in krčnimi žilami. Pa tudi analno razpoko in druga boleča stanja.
Pri zaprtju pa utegne pomagati položaj čepenja pri kakanju. V nekaterih delih Azije in Afrike je čepenje še vedno tradicionalni položaj, zahodnjaki pa smo se navadili sedeti na straniščnih školjkah. Toda če sedimo vzravnano, se naš »anorektalni kot« ne zravna dovolj. Ta pentlja na koncu danke nam pomaga, da se ne ponečedimo v hlače. V sedečem položaju na stranišču mora blato narediti zavoj za skoraj devetdeset stopinj, to pa izniči namen te genialne zasnove. Poskus odvajanja blata v sedečem položaju je podoben poskusu vožnje avtomobila, ne da bi sprostili ročno zavoro. Anorektalni kot pa spremenimo, ko čepimo ali se sklonimo naprej, da lažje odvedemo nenaravno trdo blato. Toda zakaj ne bi raje odpravili vzroka in jedli dovolj polnovredne rastlinske hrane, ki vsebuje vlaknine? Te pa ustvarijo veliko in mehko blato, ki gre skozi brez napora in pod kakršnim koli kotom, predlaga ameriški zdravnik dr. Michael Greger v novi knjigi Kako upočasnimo staranje s hrano – 2. del (Misteriji.si; 29,90 €).
Celodnevni post najlažje izvedemo na mlaj, 1. novembra, in na polno luno, 15. novembra, ter že dan prej in/ali še en dan pozneje. Kratke, a učinkovite predahe od hrane pa priporočamo na spodnje astrološke termine. Lahko se postimo, jemo manj in lažje prebavljivo hrano ter pijemo več čiste vode.
Opozorimo še na retrogradni Merkur, ki bo trajal od 26. novembra do 15. decembra. Pozor na zavestni nadzor nad izbiro in količino hrane, ki jo bomo zaužili – zlasti nekaj dni pred začetkom tega obdobja ter nekaj dni na koncu in še po koncu tega obdobja, saj so najzahtevnejši obrati energije. Ključno je, da vsak dan spijemo dovolj vode, še posebej če, denimo, trpimo zaradi artritisa.
»Nobeno tkivo, organ ali žleza ne more pravilno delovati brez dovolj vode. Ko zaradi dehidracije vsebnost vode v tkivih pade na določeno stopnjo, dvoslojna membrana, ki obdaja celice, naredi oviro, ki preprečuje nadaljnje izgube vode. To ovira prost pretok molekul, presnova in izločanje sta omejena. Počasna presnova in izločanje vodita do tega, da se v krvi začnejo nabirati strupi. To se pokaže v obliki glavobolov, fibromialgije in vnetij, povezanih z artritisom,« v knjigi Zdravljenje artritisa (Misteriji.si; 29,90 €) opozarja Barbara Černe.
1. november: MLAJ – ves dan
3. november: 5.52 do 6.21
5. november: 11.25 do 16.18
10. november: 1.25 do 5.01
12. november: 7.14 do 7.27
15. november: POLNA
LUNA – ves dan
18. november: 5.10 do 9.51
20. november: 12.21 do 14.52
22.–23. november: 14.16 do 0.02
25. november: 6.36 do 12.21
27.–28. november: 10.15 do 1.22
30. november: 7.20 do 12.54
Vse knjige, ki jih izdaja ARA založba, lahko kupite tudi v knjigarnah DZS po vsej Sloveniji.
založba d.o .o., Cigaletova 5, 1000 Ljubljana
založba d.o .o., Cigaletova 5, 1000 Ljubljana
: 01/23-19-360, e-pošta: info@misteriji.si
: 01/23-19-360, e-pošta: info@misteriji.si
Medical center Rogaška v sodelovanju z ICANNA – Mednarodnim inštitutom za kanabinoide od 22. do 23. novembra organizira dvodnevni kongres o uporabi konoplje in kanabinoidov v medicini. Primarno je namenjen zdravnikom in zdravstvenim delavcem. Poučili se bodo o pridelavi konoplje za medicinske namene, delovanju kanabinoidov, vplivu endokanabinoidnega sistema na zdravje in potek bolezni, indikacijah in predpisovanju kanabinoidov. Nastopili bodo ugledni domači in tuji zdravniki ter strokovnjaki, ki že desetletja uporabljajo kanabinoide v klinični praksi.
»Letos smo na posvetovalnem referendumu prepričljivo podprli rabo konoplje v medicinske namene, a se za bolnike še ni nič spremenilo. Še vedno so prepuščeni črnemu trgu tako glede nasvetov o uporabi konoplje za medicinske namene kot tudi za nakup konopljinih izdelkov. Želijo si informacij in napotkov od zdravnikov in medicinskega osebja. Trenutno jim
Vabimo bralce, da nam pošiljajo nenavadne fotografije, ko se narava poigra in izoblikuje zanimive stvaritve. Avtorji objavljene fotografije bodo prejeli knjižno nagrado. Fotografije z opisom pošljite na: andrej@misteriji.si.

V parku se usedem na klopico in se zazrem v drevo pred sabo. Kdo me gleda? Hudiček. Le kaj mi je želel povedati? Lep pozdrav! Cirila iz Borovnice

niti ne upajo povedati, da se zanimajo za konopljo ali da že kaj jemljejo. Konoplje se drži stigma, ki je posledica prepovedi med strokovnjaki in zdravniki, manj med bolniki. Od ust do ust pa medtem krožijo informacije, da lajša stranske učinke kemoterapij, bolečine in vnetja, pomaga do krepčilnega spanca, da pomaga v stresnih obdobjih, ko recimo čakamo izvide in podobno,« pravi doc. dr. Tanja Bagar, direktorica ICANNE. Večjo oviro za smotrno in znanstveno podprto rabo konoplje in kanabinoidov v medicini vidi v neiinformiranosti zdravnikov in zdravstvenega osebja. Le leta 2016 je bilo izvedeno eno izobraževanje zanje.
»Če smo optimistični in polagamo upanje v pozitivne spremembe zakonodaje, ki bodo odpravile ovire glede uporabe konoplje v medicini in omogočile bolnikom dostop do kakovostnih izdelkov, nam to še vedno ne pomaga veliko, če nimamo zdravnikov, ki jih znajo predpisati in ustrezno uskladiti z že vpeljano terapijo. Zato v novembru organiziramo dvodnevni kongres,« dodaja.
Pomembno: Zdravniška zbornica Slovenije udeležencem prizna osem kreditnih točk, Zbornica zdravstvene in babiške nege pa pasivnim udeležencem deset licenčnih točk. Prijave na rb.gy/3jtifb. T. S.

rheologi so v arheološkem najdišču El Perú v Gvatemali odkrili redko 1500 let staro keramično majevsko figurico. Morda se na prvi pogled ne zdi nič tako zelo posebnega, toda podroben pregled pokaže, da artefakt, najden v kraljevi grobnici, prikazuje osebo, ki na glavi nosi nekakšno odstranljivo čelado. Kaj naj bi figura točno predstavljala, še ni jasno, še najbolj pa spominja na nekakšnega starodavnega »astronavta«. V grobnici je bilo najdenih še triindvajset drugih keramičnih figur, vključno z bojevniki, plesalci in šamani, kar ponuja nov vpogled v majevske pogrebne običaje iz tega obdobja.
Sumerci, več kot 5500 let stara civilizacija, so zelo očitno vedeli veliko več o našem osončju, kot bi »morali«. Poleg poznavanja planetov, kot sta Jupiter in Mars, so Sumerci opisovali tudi vesoljske dogodke, kot je nastanek asteroidnega pasu. Verjeli so, da je bil ob vesoljskem trku uničen planet Tiamat, kar je presenetljivo podobno sodobnim hipotezam o izvoru asteroidnega pasu. Nekateri raziskovalci ugibajo, da je njihovo znanje morda izviralo iz naprednih, danes pozabljenih tehnologij, ali celo iz zunanjih vplivov (nezemeljske inteligence), kar še vedno vzbuja številne teorije med strokovnjaki.

11. lunarni dan – OGNJENI MEČ
V vedskem lunarnem mesecu, ki ima 30 dni, vsak dan nosi svojo zgodbo. Če se ravnamo po lunarnih dnevih, se nam usoda in zdravje izboljšata in postanemo zelo učinkoviti. (Več o lunarnih dnevih v 364. in 365. številki Misterijev.)
Enajsti lunarni dan, imenovan »Ognjeni meč«, naj bi bil energijsko najmočnejši v celem lunarnem mesecu! Vse, kar smo začeli, je potrebno pripeljati do uspešne dovršitve. Vse, česar se lotimo na 11. dan, se takoj priključi na ocean vesoljne pomoči. Prekinitev, tudi samo za krajši čas, pa Vesolje razume kot odpoved od energijske pomoči, projekt se »ohromi«, iz njega »odteka življenje« in na koncu »umre«. Če pa zaupamo v pozitiven rezultat, dobimo od Vesolja vso podporo in potrebno energijo za popoln uspeh.
Če na ta dan padajo noži in vilice – bodite previdni!
Sanje na dan Ognjenega meča se lahko uresničijo. Vzemite jih resno, lahko vam povedo o vaši prihodnosti.
Ljudje, rojeni na ta dan, imajo veliko energije ter nenavadne sposobnosti in talente. Pomembno je, da jih prepoznajo in se jih naučijo uporabljati.
11. lunarni dan je v tem mesecu od 11. novembra ob 14.27 do 12. novembra ob 14.46.
Koledar lunarnih dnevov za vsak dan v letu 2024 vsebuje brošura 30 LUNARNIH DNEVOV (25 €); naročite jo na e-naslov marjetica. vedezevanje@gmail.com ali 040/271 835 (Darja Gaja). V njej so še bolj podrobni opisi vseh tridesetih lunarnih dnevov.

V tej reviji boste na njenih straneh našli izbrane citate iz knjige Enciklopedija misli iz poglavja »Spolnost« –za mesečni duševni odmerek modrih, vzpodbudnih in pozitivnih misli.
(Knjiga v treh delih je na voljo na Misteriji.si)
Ljudje mikrobiom najbolj povezujemo s črevesjem, vendar je povezan z vsem telesom. Dobro počutje in zdravje se zato začneta v črevesju! Naš sogovornik, molekularni mikrobiolog prof. dr. Aleš Lapanje, nam je osvetlil, kakšno življenje se dogaja tam spodaj v »ceveh«, ki so dolge več metrov, in kako lahko vplivamo nanj. Raziskovalno deluje v okviru Instituta Jožef Stefan, kjer vodi Laboratorij za koloidno biologijo. Je tudi lastnik Inštituta za metagenomiko in mikrobne tehnologije, v okviru katerega deluje raziskovalni laboratorij iBIOM.
V iBIOM-u analizirajo, svetujejo in pomagajo pri reševanju težav, nastalih zaradi porušenega ravnovesja v črevesnem mikrobiomu. Raziščejo to bakterijsko združbo, prek majhnega vzorca našega blata, in nam na podlagi ugotovitev pomagajo upravljati z našimi bakterijami. Uspešno so pomagali že več kot petstotim ljudem pri težavah, kot so napihnjenost, zaprtje, driska in bolečine v trebuhu, pa tudi težavam, ki na prvi pogled niso povezane z našim črevesjem, kot so debelost, tesnobnost, depresija, demenca, alergije, sladkorna bolezen, vnetja in avtizem.
iBiom je edini na svetu, kjer vam je uspelo pripraviti unikatno raziskavo po meri vsakega posameznika. V čem je ta unikatnost, prednost vaše raziskave pred raziskavami drugih laboratorijev?
Prvi steber naše raziskave je, da je analiza povsem individualna. Vsak človek ima namreč svojstven mikro-
Mikrobiom nam da odgovor, kje je težava in kako naj ga upravljamo, da preprečimo ali pa diagnosticiramo bolezen in si povrnemo zdravje.

biom. Drugi laboratoriji to delajo na industrijski način. Drugi steber je celostna obravnava človeka, to pomeni, da upoštevamo vse njegove dotedanje zdravstvene izvide. Vsak izpolni vprašalnik o zdravstvenih težavah. Mikrobiom nato pogledamo v detajle. Tretji steber je, da v mikrobiomu gledamo prisotnost in odsotnost določenih mikrobov, povezave med njimi, njihov metabolizem, ki je specifičen za vsak mikrob ter povezuje mikrobe med seboj in mikrobe s cikli znotraj našega telesa. Vse te podatke nato povežemo s težavami, ki jih ima ta oseba. Vidimo, kaj je v mikrobiomu, denimo, katere hrane oseba preveč zaužije in katere premalo. Pravzaprav vidimo celo njeno zgodovino, kajti v mikrobiomu se kopiči vse, zato lahko iz njega razberemo vse, kar nas zanima, da lahko osebi pomagamo. Preiskava mikrobioma je kot rentgen. In četrti steber je, da stalno sledimo izsledkom najnovejših raziskav s tega področja in te takoj upoštevamo v praksi. Denimo, nedavno je izšel članek v znanstveni reviji, da so pri Alzheimerjevi bolezni našli povezavo z nekim mikrobom, ki je bil prej neznan. To spoznanje takoj vključimo v našo analizo in rezultat. V vsakega posameznika vložimo ogromno truda, tako da je vsaka analiza neke vrste znanstvenoraziskovalno delo, kar mu na koncu omogoča, da pride do svojega zdravja. Zato tudi raziskava traja dlje časa, kake tri mesece. Do zdaj smo obravnavali kakih petsto ljudi. Laboratoriji v svetu, ki te raziskave
Zdravje se Začne v črevesju
delajo industrijsko, toliko obravnav naredijo v nekaj dneh.
Ali osebi potem nudite tudi oporo pri spreminjanju prehrane in mikrobioma?
Da, vsakogar obravnavamo posebej, unikatno, in ga potem tudi dolgoročno spremljamo. To je pa peti steber – da osebo poučimo, kako naj spremeni prehrano, dostikrat kar cel življenjski slog, kako naj te spremembe vpelje v vsakdanjik. In v primeru težav lahko vedno stopi v stik z nami in mu pomagamo. Denimo, na jedilniku Slovencev zelo manjka fermentirane hrane. Ko oseba to začne dodajati v svojo prehrano, ima na začetku težave, na primer napenjanje, saj se začne
Gradbenik, 57 let: »Pred tremi meseci sem spremenil prehrano po priporočilih vaše preiskave. Načina prehranjevanja sem se držal približno osemdeset odstotkov zaradi narave dela. Je pa razlika glede na prej očitna. Blato je zdaj skoraj vedno konsistentno, ne prihaja več do drisk po obrokih, prav tako je odvajanje postalo normalno. Holesterol je spet v mejah normale. Telesna teža se je zmanjšala za osem kilogramov. Počutje je odlično in mesa sploh ne pogrešam. Ugotavljam, katera hrana mi dela težave.«
Upokojenka, 62 let: »Sem že v programu. Izboljšala se mi je prebava, saj sem imela pred tem štiri mesece diarejo, pred njo pa zastajanje blata, mazljivo blato, kot da se črevesje ne more do konca izprazniti. Izboljšavo čutim v redni prebavi, manj imam mišičnih krčev, prej sem imela nenehno ›muskelfiber‹. Neprestano sem imela gnojne čepe na mandljih, ki so bili popolnoma pordeli. Sedaj so lepo rožnati in le če pride do kake okužbe, se pojavi še kak čep.«
podirati fino usklajeno delovanje mikrobioma v povezavi s telesom, ki je bil prej v nekem ravnovesju, čeprav je to peljalo v težave. Takrat marsikdo rabi pomoč, nasvete, kako naj te spremembe vpelje počasi, zmerno. Pomagamo prilagoditi celoten življenjski slog.
Kako vidite iz mikrobioma, ali je nekdo zdrav ali bolan? Se to vidi iz vrst bakterij, njihovega števila …?
Iz vsega. Tako kot celostno obravnavamo osebo, celostno obravnavamo tudi mikrobiom, spet v povezavi z njenimi težavami. Če je pestrost bakterij nizka, je to prvi znak, po katerem vidimo, da se nekaj dogaja. Drug problem je, če je pestrost bakterij prevelika, pa oseba ni vegan. Ko potekajo določeni vnetni procesi, imamo lahko nagnjenost k večji razrasti različnih vrst bakterij. Lahko gre za veliko pestrost slabih bakterij. Tudi tu pride v ospredje prednost individualne obravnave, ker lahko preverimo, v kakšnem okolju oseba živi in kaj se z njo dogaja. Na primer, gospa je imela zelo povečano razrast bakterij, ki so odporne na živo srebro. Poklicali smo jo in povedala je, da uživa veliko določenih rib. Nekatere ribe lahko kopičijo ogromne količine živega srebra. Po analizi jih je opustila in spremenila jedilnik. V zadnjem času velikokrat opazimo razrast bakterij, odpornih na antibiotike. V mikrobiomu se pravzaprav vidi celotna zgodovina za več let nazaj, kakšno hrano je oseba jedla in kaj je bilo v njej, tudi denimo pesticidi.
Ali z raziskavo blata prepoznate oziroma predvidite bolezni, ki bi se lahko razvile v prihodnosti?
Imamo določene skupine bakterij, na katere smo posebej pozorni. Če jih zaznamo, skušamo osebo napotiti na druge medicinske preiskave. Prek mikrobioma vidimo indice, da se v telesu nekaj dogaja. Pri bolnikih, ki so preboleli raka ali pa imajo potencial, da bi se pri njih razvilo kaj takega, ne samo na
Ko vzamemo
širokospektralen antibiotik, naredimo velik genocid med mikrobi v našem črevesju.
črevesju ampak tudi drugje, je dostikrat profil bakterijske združbe tak, da je sicer raznolik, ampak je vrstna zastopanost razporejena izredno enakomerno. Pri zdravih ljudeh je mikrobiom tak, da imajo neko bakterijo v večjem številu, okoli nje pa se zgradi združba, ki je zaradi metabolizma in metaboličnih povezav v manjšem številu. Če pa je vsepovsod isto, je to znak, da je nekaj zelo narobe. Zato je zelo pomembno, da vemo, kaj človeka tare, kakšne težave zaznava, da nam da zdravniške izvide. Iz vseh teh podatkov skušamo nato ugotoviti več različic, kaj bi lahko bil problem. Mikrobiom pa nam da odgovor, v kateri smeri je težava in kako naj z njim upravljamo, da bodisi preprečimo nastanek bolezni ali pa diagnosticiramo težave in si povrnemo zdravje.
S čim ga potem upravljate?
S hrano, gibanjem, obvladovanjem stresa. Tako kot imamo črevesno – možgansko os, ko črevesje vpliva na možgane, tako imamo možgansko – črevesno os, ko stres vpliva na mikrobiom. Velikokrat dodatno vprašamo, kako je kaj s stresom.
Verjetno poteka glavna interakcija med nami in mikrobiomom prek telesnih tekočin. Kako pomembna je voda, ki jo pijemo? Kako nanj vplivajo produkti naših žlez z notranjim izločanjem (slina, želodčni sokovi, žolč, sokovi trebušne slinavke, dvanajstnika)?
Za mikrobiom je voda izredno pomembna, enako kot za naše celice. Tudi produkti žlez so zelo pomembni, saj če že v prebavnih sokovih ni dovolj encimov oziroma ti ne delujejo, gre več nepresnovljene hrane v debelo črevo. V
debelem črevesu pa je največ bakterij, pri čemer določene skupine spodbudimo k razrastu. Mikrobi živijo v nekem prostoru. Ta naš prostor, črevesje, je povezan z njimi z vsem, kar jim nudi. Ali je to dvig temperature, prebavni sokovi, prisotnost ali odsotnost žolča, vse to spreminja njihove pogoje. Eni se razrastejo, drugi se ne. Vse je povezano eno z drugim. Eni izničujejo druge, eni izločajo snovi, ki drugim omogočajo ali onemogočajo rast … to je zelo zapleten računalnik.
Slišali smo o pomembnosti slepiča kot skladišča »dobrih« bakterij. So morda za ponovno raznolikost našega mikrobioma po jemanju antibiotikov odgovorne tudi bakterijske spore, ki omogočajo ponovno vzpostavitev ravnovesja in so odporne na antibiotike?
Bi rekel, da ne. Mikrobi so po celem našem črevesju. Ko vzamemo širokospektralen antibiotik, jih ne uničimo, naredimo pa velik genocid. Zdrav mikrobiom je treba na novo vzpostaviti.
Ali se to samo vzpostavi ali je treba pomagati s probiotiki in prebiotiki?
Probiotiki ne bodo kaj veliko pomagali. To so laboratorijski sevi, prilagojeni na laboratorijske pogoje. V laboratoriju so lahko popolnoma dokazljivi rezultati njihovega delovanja, da na primer zavirajo rast nečesa, izločajo neke koristne snovi ali onemogočajo razrast patogenov. Ampak nato pridejo v okolje, v naše črevesje, na katerega niso prilagojeni. Že ko se v mikrobiomu soočijo z drugačnim pH, z drugačnimi količinami do-
Če želimo spet ustrezno kolonizirati naše črevesje z mikrobi za zdrav mikrobiom, je najbolj ustrezno uživati fermentirano hrano.

Prof. dr. Aleš Lapanje pri aparatu, ki ga uporablja pri analizi vzorčkov blata.
stopne vode in vsem drugim, od njih kaj veliko ne ostane. Zato jih je treba pogosto jemati.
Kaj pa je potem alternativa antibiotikom?
Določeni probiotiki lahko zelo dobro delujejo za akutne težave, kot so driske, jemanje antibiotikov in drugo, ampak če želimo ustrezno kolonizirati naše črevesje z mikrobi, pa je najbolj ustrezno uživati fermentirano hrano. Denimo kislo zelje, kislo repo, fermentirane kumare, kombučo, vodni ali mlečni kefir. Mikrobno združbo, ki je bila spremenjena ali celo
uničena, je treba zgraditi nazaj. Ne bo se vzpostavila kar sama od sebe. In ti mikrobi morajo imeti tudi ustrezna hranila. Zelo dobro je, da kak mesec po jemanju antibiotikov pogledamo stanje mikrobiote in pripravimo načrt, kako povrniti zdravo ravnovesje. Ozkospektralni antibiotiki, denimo za glivice na koži, ne naredijo velikega problema. Težava pa so širokospektralni, sistemski antibiotiki. Pravkar smo naredili metodo, da lahko »poskeniramo« vse mikrobe v mikrobioti oziroma poskušamo dobiti vse združbe mikrobov, ki so v črevesju, in potem
Zdravje se Začne v črevesju
osebi nudimo hranjenje tega za čas, ko bo to potrebovala, denimo po antibiotični kuri. To je najnovejše, kar smo razvili.
To se pravi, da iz vzorčka blata naredite človeku lastne probiotike, njemu najbolj naravne?
Da, kdor je šel skozi naš program in smo mu pomagali, ima tudi zdravo mikrobioto. Razvili smo metodo, ki temelji na mikrofiltrskih sistemih in agregaciji. Razvijali smo jo kar nekaj let, da smo dobili združbo mikrobiotičnih bakterij, ki med seboj dobro funkcionirajo same zase. Oseba pa se odloči, koliko od te bogatosti želi, da shranimo.
Bolje jih je zajeti čim več?
Seveda. V mikrobiomu imamo poglavitne skupine bakterij, ob katerih

Knjiga o moči črevesnih mikrobov za zdravje vaših možganov (26,90 €) je na voljo na Misteriji.si ali po telefonu 051/307 777.
se zgradi to jedro, imamo pa potem vse stranske skupine, ki omogočajo preživetje tem poglavitnim. To je zelo povezano. Čim širši del tega zajamemo, lažje se potem to vse skupaj vzpostavi nazaj. Je pa seveda pomembno, da je mikrobiom osebe zdrav.
Koliko dolgo to hranite za človeka? Kolikor dolgo želi.
Ali imajo mikroorganizmi vpliv tudi na naše mišljenje, čustvovanje, delovanje?
Na nas vplivajo z več vidikov. Najlažje to vidimo, ko imamo na primer drisko ali nas boli trebuh, saj ne moremo nič delati. To je primer neposredne povezave z mikrobioto. Posredne povezave pa so, da veliko mikrobov v črevesju izdeluje ali presnavlja živčne prenašalce. Bakterije v črevesju tvorijo več kot osemdeset odstotkov serotonina. Ustvarjajo tudi snovi, kot so dopamin, gaba, adrenalin, noradrenalin. A to, kar se tvori v črevesju, vključno z živčnimi prenašalci, težko preide možgansko-krvno pregrado. Ampak v določenih stanjih, na primer pri avtistih, vnetnih spremembah, prisotnosti vnetnih mediatorjev ali pri ljudeh, ki so imeli infarkt, pa ta možgansko-krvna pregrada postane bolj prepustna. Črevesje ima vpliv tudi prek vagusnega živca, ki ga velikokrat stimulirajo mikrobi ali pa lokalni živčni prenašalci. Oživčuje vse organe in ima v črevesju več kot osemdeset odstotkov senzorskih končičev. In karkoli se v črevesju dogaja, je neposredno povezavo z našimi možgani. Avtocesta neposredno do nas.
Ali pri svetovanju upoštevate tudi zdravje ustne votline osebe? Ali lahko škodljivi produkti bakterij, strupov v ustni votlini iz mrtvih zob, kavitacij, vnetij v ustih, ki se izpirajo v slino in nato potujejo po celem prebavnem traktu, škodujejo tudi mikrobiomu?
Zagotovo mu lahko škodujejo. V mikrobiomu vidimo določene mikrobe, ki
»Osebi lahko poskeniramo vse mikrobe v njeni mikrobioti in ji potem nudimo hranjenje tega, ko bo to potrebovala, denimo po antibiotični kuri.«
pridejo iz ustne votline oziroma so povezani z zdravjem v ustni votlini. Dostikrat ljudem svetujemo, naj pazijo na ustno higieno, naj gredo k zobozdravniku in uredijo težave. Še večji problem pa je, da je to, kar se dogaja v ustih, neposredno vezano na kri in gre v naš krvni sistem. V ustih imamo ogromno biofilmov in ko pride to v krvni sistem in ker so ti mikrobi načeloma povezani z nami, je problem, da jih naš imunski sistem ne odstranjuje oziroma jih ne prepozna kot nek patogen organizem. Velikokrat se pri ljudeh, ki imajo težave v ustni votlini, poškodbo zoba, dlesni, nek vnetni proces ali parodontozo, začne razraščati določena bakterija na srčnih zaklopkah. To povzroči lokalno vnetje, srčna zaklopka neha delovati, začno so težave z delovanjem srca.
Kdaj pride v poštev fekalna transplantacija?
Zavedati se je treba, da je fekalna transplantacija le – transplantacija. Tako kot vsak ne presadi ledvic ali srca, če ima kake težave z njimi, si tudi ne bo vsak presadil črevesnega mikrobioma. Presaditev je zelo tvegana stvar, mikrobiote še bolj, ker o tem še premalo vemo. Pri presaditvi organa vemo, s kakšnimi zdravili moramo vzdrževati imunski sistem, da ga ne zavrne. Fekalna transplantacija je zato priporočljiva le za bolnike, ki so obsojeni na smrt, ko jim črevo, po domače rečeno, razpada. To je skrajni primer antibiotičnih terapij, ko se določena bakterija toliko razmnoži, da povzroča luknje na črevesju. Takrat pa je edina rešitev tran-
splantacija črevesja, ki temu bolniku reši življenje.
Ali kakšen zdravnik že pošlje svojega bolnika k vam na raziskavo blata in potem upošteva izsledke?
Seveda, imamo bolnike, ki jih k nam pošljejo zdravniki, saj to ni izključujoče z medicino. Je pa res, da so zdravniki premalo seznanjeni s to možnostjo preiskave, nekaterim pa se zdi to še znanstvena fantastika, ne znanost. Pokažejo pa veliko zanimanje za to raziskavo zdravniki, ki so jim izsledke pokazale naše stranke, katerim oni sami niso mogli pomagati, s pomočjo te analize pa so rešili težave. Ti zdravniki nato pošiljajo ljudi k nam, navadno so to gastroenterologi, ginekologi in splošni zdravniki, predvsem iz javnih zdravstvenih zavodov.
Kaj bi na koncu priporočili vsem za zdravo in uravnoteženo mikrobioto?
Ne potrebujemo uživati toliko mesa. Ni potrebe, da bi bilo meso pri vsakem obroku ali sploh vsak dan. Rastlinska hrana bistveno poveča raznovrstnost mikrobov. Drugo je uravnoteženost hrane. Ljudje praktično vsak dan jedo enako, imajo enake jedilnike. Hrana naj se ne ponavlja, jedilnik mora biti pester. Ni dobro, da pretiravamo z ogljikovimi hidrati, recimo testeninami, krompirjem, močnatimi jedmi. Če že, jih jemo ohlajene. Preveč ogljikovih hidratov povzroči preveč enterobakterij v črevesju. Enterobakterije se razrastejo zaradi sladkorja
Velikokrat se pri ljudeh, ki imajo v ustni votlini poškodbo zoba, dlesni, nek vnetni proces ali parodontozo, začne razraščati določena bakterija na srčnih zaklopkah.
Domov dobite malo posodico. V njej pa drobno zajemalkico, v katero bi lahko dali dve, tri glavice vžigalic. Vi pa z njo zajamete majčken košček vašega blata, jo vrnete v posodico in pošljete na Inštitut za metagenomiko in mikrobne tehnologije v Ljubljani, kjer v okviru preiskave iBIOM natančno analizirajo vaš mikrobiom. Na inštitutu z najsodobnejšimi laboratorijskimi preiskavami ugotovijo, kakšno je življenje v vašem blatu, kakšen je vaš mikrobom: katere bakterije imate v črevesju, koliko jih je, kakšna so razmerja med njimi in kakšen je njihov tip presnove. In kako delujejo in kakšne možne bolezni lahko povzročajo. Ali medsebojno sodelujejo ali tekmujejo.
Rezultate preiskave strnejo v osebni priročnik na trideset do štirideset straneh, da si lahko sami in s pomočjo mikrobioma vzpostavite svoje zdravje. V njem so vse potrebne informacije in napotki, katera hranila vam priporočajo ali odsvetujejo, skratka, kako si lahko prek mikrobov v vašem črevesju pomagate pri zdravju. Poleg tega pa vas strokovnjaki spremljajo ob vsakem koraku pri doseganju vašega zdravja. Več o preiskavah na Ibiom.eu, po telefonu 041/825 182 ali e-naslovu info@ibiom.eu.


v kombinaciji z maščobo. To težavo ima približno tretjina Slovencev. Enterobakterije pogosto povzročijo, da se imunski sistem prehitro odzove, kar lahko privede do težav, kot so artritis, alergije, slabo počutje, depresija, izpadanje las in razna vnetja.
Bolje je, da jemo po majhnih obrokih in da hrano razdelimo v več kot pet obrokov na dan. Ni potrebno, da je kosilo velik obrok, lahko ga razdelimo na več obrokov. Jejmo veliko zelenjave, surove, kuhane in fermentirane. Če ne delamo veliko fizičnega, nismo športniki, ne potrebujemo veliko beljakovin.
Vsak dan potrebujemo gibanje, vsaj dvajset minut na dan, da se nam dvigne pulz do 100, 120. Enkrat do dvakrat na teden pa si je treba privoščiti nek daljši šport, za uro, dve, tri oziroma po zmogljivosti. Telo deluje podobno kot energetska črpalka. Če ta samo stoji, zarjavi. Pri telesu je enako. Mora se povečati prekrvitev, razširiti žile v vseh organskih sistemih, ne samo centralni sistem okrog centralnih organov, ampak tudi drugje. Izogibajmo se tudi preveč pečeni in zažgani hrani, ki povzroča, da se naše celice hitreje starajo.
Tatjana Svete
Kip naj bi se premikal tudi pred slovensko osamosvojitveno vojno
ZMarijino kapelico z Županjih njiv, vasi v občini Kamnik, je povezanih veliko nenavadnih in navdihujočih zgodb. K njej so se v osemdesetih letih prejšnjega stoletja zgrinjale množice ljudi, saj se je razširil glas o premikanju Marijinega kipa in čudežnih ozdravljenjih. V kronikah iz devetnajstega stoletja je zabeleženo, da se je kip premaknil malo pred velikim potresom v Ljubljani, pa pred izbruhoma obeh svetovnih vojn leta 1914 in pred letom 1941. Marijin kip naj bi se premikal tudi pred slovensko osamosvojitveno vojno. Lani, ko so katastrofalne poplave razdejale vas, je ostala kapelica nedotaknjena. K njej še vedno romajo ljudje s prošnjami; da se mnogim tudi uresničijo, nam je na Marijin praznik 15. avgusta zaupala štiriinosemdesetletna Mara Mlakar, ki že več kot štirideset let skrbi za urejenost kapelice.
Kraj s kapelico je zaslovel, ko je leta 1988 mlad vaščan opazil premikanje Marijinega kipa. Vest se je razširila kot blisk in ljudje, ki so prihajali iz vse Slovenije, pa tudi tujine, so se gnetli pred kapelico, da bi videli premikanje kipa. Marija naj bi oznanjala slovensko osamosvojitveno vojno, ki je sledila tri leta zatem.
»Ko se je tole začelo, je bilo hudo, ker je majhen kraj, množice pa je bilo veliko. To je bilo 1988. leta in še kar nekaj časa po tem. Sama sem tak človek, da ne morem drugemu odreči. So prihajali tudi obiskovalci iz Avstrije, sem jih povabila notri v hišo. Enkrat jih je bilo kakih dvajset … Zadnji dve leti pa jih ne morem več gostiti,« pove Mara.
Marijin kip v Županjih njivah se je premaknil malo pred velikim potresom v Ljubljani, pa pred izbruhoma obeh svetovnih vojn.

Med epidemijo je dobila kovidno pljučnico, zaradi katere je morala na zdravljenje v bolnišnico. Tam je preživela devetindvajset hudih dni, dve bolnici zraven nje sta umrli, v duhu se je tudi sama že poslavljala od življenja in rekla svoji pokojni sestri, ki je umrla pred letom dni, da se ji bo kmalu pridružila. Kot že velikokrat v življenju, se je tudi tokrat obrnila na Marijo in jo prosila za ozdravitev. Pri tem se je zaobljubila, da bo na svoje stroške prebelila Marijino kapelico. Tako se je tudi zgodilo. Ko se je vrnila domov, so ji pomagali njeni otroci:
»Lahko rečem, da imam zlate otroke. Jemala sem tudi tablete, še kak mesec sem potrebovala za okrevanje. Odkar mi je mož umrl, otroci pravijo, da ob nedeljah ne bom sama, in grem vedno k enemu na kosilo. Če si ti dober do svojih otrok, ti to pokažejo. Imam šest vnukov in devet pravnukov. Ko imam rojstni dan, jih je toliko, da jih povabim v gostilno, da se še tam malo poveselimo.«
Skrbništvo za kapelico je prevzela od svoje mame. Kip lurške Marije je leta 1906 pri lokalnem kiparju naročil veren vaščan. Sama osebno sicer ni videla, da bi se Marija kdaj premikala ali točila solze.
»Meni ni treba, da pokaže Marija, da joka. Jaz vem, da to obstaja in da mi je že velikokrat pomagalo. Veliko stvari se je dobro končalo, ker mi je Marija stala ob strani,« pripoveduje Mara, ki živi nedaleč stran od kapelice in z veliko ljubeznijo skrbi, da je okrašena in urejena. Vsak dan iz svežega cvetja naredi ikebano, ki v poletnem času hitro vene, sicer pa je Marijin kip obdan z lončnicami in svečami. Ko obišče kapelico, pri tem malo moli ali pa si v mislih zapoje kakšno cerkveno pesmico, »ker so tako lepa besedila«. Cerkvena pevka je že štiriinsedemdeset let in pravi, da jo petje »gor drži«. »Veselim se že ob nedeljah, ko bomo spet peli. Zjutraj ob sedmi uri imamo

Mara Mlakar je tudi sama doživela posebno izkušnjo, v kateri vidi moč delovanja božje roke.
mašo, to mi je v uteho. Sploh pa danes, ko je Marijin praznik, to je zame druga velika noč,« pove naša sogovornica, ki ji vera v življenju veliko pomeni. Te ni nikoli zatajila, tudi v času komunizma ne, njena družina je bila ves čas povezana z župnijo Stranje in tudi svoje otroke je vzgajala v krščanskem duhu.
Govorice o kapelici s kipom Lurške Marije so v preteklosti pritegnile tudi številne radiesteziste, zdravilce, bioenergetike … Radiestezijske meritve so menda pokazale zelo močno sevanje v območju kapelice. To naj bi bilo celo močnejše kot v Medžugorju in Lurdu. Ponoči naj bi se vrednosti močno povečale in naj bi sevanje dosegalo celo 90.000 enot po Bovisu. Radiestezist in bioenergetik Stane Oblak je odkril, da se po sončevem zahodu se-
vanje poveča za tri- do štirikrat. Domneval je, da v zemeljski skorji pod vasjo poteka proces nekakšnega odpiranja. Voda, ki teče pod krajem, je nabita z zdravilnim sevanjem, primerna pa je tudi sestava rudnin in kamenin. Podzemni tok vode ob trenju s kamninami oplemeniti kozmične žarke, ki se vračajo nazaj v vesolje. Veliko ljudi, ki je obiskovalo kapelico, je poročalo o izboljšanju počutja in ozdravitvah. Leta 1988 je prišel tudi pater Simon Ašič in Mari podaril svojo knjigo.
»Pater Ašič se je hotel prepričati, kaj je tu. Včasih je bil poleg kapelice vodnjak, iz katerega so črpali zdravilno vodo. Želel je preveriti zdravilnost vode, zato je zlezel v šterno. Notri so bile železne stopnice. Ko se je vrnil, je povedal, da so tam tako močne energije, da je mislil, da ne bo prišel ven.«
A. Paljevec
Zlasti močne energije naj bi bile pri kapelici takrat, ko je polna luna. Stane Oblak ji je pokazal, kje mora stati in si predstavljati, da vsrkava energijo. Opazila je, da če se dlje časa zadržuje pred kapelico, postane »matasta«. Oblak ji je svetoval, naj si, ko se vrne domov, umije roke pod mrzlo vodo. Več kot pol ure naj se obiskovalci ne bi zadrževali ob kapelici, srčni bolniki pa samo deset minut. Mara se spominja, da je soseda, ki je obnavljal kapelico, bolela rama in ji je rekel, da naslednji dan ne bo prišel. A naslednji dan ga je zagledala, kako obnavlja kapelico. Povedal ji je, da ga rama ne boli več.
Spominja se tudi alpinista Tomaža Humarja, ki ga je žena večkrat pripeljala na invalidskem vozičku, ko se je poškodoval pri delu na hiši. Verjel je, da mu bo
Zdravilno sevanje v območju kapelice naj bi bilo celo močnejše kot v Medžugorju in Lurdu.
marijin kiP naPoveduje vojne
Marija pomagala. Svoje telo moraš prepričati, da mu bo Marija pomagala. Tomaž je zares ozdravel, potem pa je prišel do konca v Himalaji.
Zanimivo je, da se je Tomažev znameniti sorodnik, župnik Jurij Humar s Primskovega, ki je zdravil z magnetizmom in s katerim je bil Tomaž duhovno povezan, rodil na Vodicah pri Mekinjah, ki so samo za streljaj oddaljene od Županjih njiv. Sam je pravil, da je zdravil s svojimi lastnimi živčnimi žarki, ko je svojo magnetično silo prenesel na živo bitje ali mrtvo snov.
Nosil je samo obleko iz platna, kajti suknena obleka mu je bila pretopla. Spal je na slamnjači in se odeval s platneno rjuho. Briti se ni mogel, ker se mu je britev zaradi magnetizma takoj zarezala v kožo in meso. Na Primskovo so romali bolni ljudje s Kranjske, Dolenjske, Primorske, Koroške, Štajerske, pa tudi iz
Avstrije in Bavarske – in skorajda ni bilo bolezni, ki ji ne bi bil kos. Na Primskovem je tudi njegovo zadnje počivališče, ki seva posebno moč in ga zato ljudje še danes obiskujejo.
Lani avgusta, ko je potok Bistričica razdejal Županje njive, se je zgodil še

Radiestezijske meritve so pokazale zelo močno sevanje v območju kapelice.
A. Paljevec
Foto
en čudež: »Voda je drla vsepovsod, vse je prineslo navzdol, drevje, ni da ni,« se spominja Mara. »Do druge stopnice moje hiše je prinesla ogromno mulja, mivka se je delala kot maslo. Klet, štala, šupa, senik so bili zaliti, drvarnico mi je odneslo. Vnuk mi je iz hleva rešil bika, ki je bil že do vratu v vodi. Poplava je bila najhujša pri meni in sosedu. Voda pa je čudežno drla samo malo stran od kapelice, ki je ostala nepoškodovana.«
Kapelica v Županjih njivah je v kolektivnem spominu Slovencev še vedno živa, ljudje še danes romajo k njej in prižigajo svečke, najraje zvečer, a na srečo domačinov ne tako množično kot v letih pred osamosvojitvijo Slovenije.
Andreja Paljevec
Spoštovani bralci! Če imate tudi vi kako izkušnjo, ki jo pripisujete Marijinemu kipu v Županjih njivah, vas prosimo, da jo zaupate, lahko tudi anonimno, naši novinarki Andreji Paljevec na andreja.paljevec123@gmail.com ali 041/579 322. Že vnaprej hvala za sodelovanje.
Uredništvo

Morda ste nezadovoljni z življenjem. Morda čutite, da tam zunaj obstaja nekaj večjega, kar vas čaka. Morda imate občutek, da ste neumni ali osamljeni, da del vas umira. O tem govori knjiga Elizabeth April Ne umirate, le prebujate se; iz knjige povzemamo nekaj njenih spoznanj o tesnobi.
Tesnoba je sicer zoprna, vendar je najopaznejši in najpogostejši vidik prebujanja. Ste vedeli, da še nikoli ni bilo toliko občutkov tesnobe pri otrocih in mladostnikih kot ravno zdaj? Pri tem je treba upoštevati dva dejavnika. Kot prvo, dandanes želijo starši svojim otrokom omogočiti lagodno življenje in materialne dobrine, kar pa ima za posledico, da se ustvarjajo generacije mladih, ki so prepolni pričakovanj in preobremenjeni z materialnim; prenasičeni so s fizičnim svetom in popolnoma prikrajšani za duševno zadovoljstvo. Poleg tega današnji otroci potrebujejo več podpore na vibracijski, ne pa na fizični ravni; celotna generacija že od zgodnjih let trpi zaradi občutkov tesnobe.
V današnjem času pa fizični svet ne draži le otrok, ampak tudi odrasle. Zadovoljene so vse naše nižje potrebe: imamo zadosti hrane in vode, zavetje … Celo potrebo po družbenem sprejemanju je mogoče zadovoljiti z všečki in srčki na spletu. Imamo vse, kar si sploh lahko želimo. Zakaj smo torej kot skupnost polni tesnobe in depresije? Zato, ker hrepenimo po bolj smiselnem obstoju. Ko še naprej učimo svoje otroke in prepričujemo sami sebe o tem, da je zadovoljeva-
Tesnoba je lahko prav čudovita stvar, saj nas prisili v spremembo.
nje potreb v fizičnem svetu edino, kar v resnici je, v sebi še naprej ustvarjamo bolezen, saj zanikamo eno najbolj temeljnih dobrin, svojo dušo in zavest kot del celote.
Zgodi se takrat, ko globoko v sebi nekaj vemo, a se na površju tega ne zavedamo. Nevednost je sprva blagoslov,

ker sprememba ni potrebna, sčasoma pa ohranjanje nevednosti oziroma nepripravljenost na spremembo ustvari disharmonijo, ki vas vodi v omenjeno vrsto tesnobe. Tesnoba je v tem pogledu prav čudovita stvar. Prisili nas v spremembo. Tesnoba je fizična reakcija na pomanjkanje znanja, ki nas prisili v spremembo.
V vsakdanjem življenju smo preplavljeni z različnimi energijami in vibracijami: z najpreprostejšimi, kot je srečanje z blagajnikom v trgovini, pa tudi z bolj zapletenimi, kot je soočenje s partnerjem zaradi varanja. Vsako fizično dejanje in reakcija vsebuje energijo. Prehod z ene skrajne vibracije na drugo v našem solarnem pleksusu povzroči spremembo. Čutili jo boste kot »metuljčke« v trebuhu ali pa kot veliko luknjo, ki vas teži v želodcu. Večja ko je sprememba vibracije, večja je reakcija v solarnem pleksusu, kar pomeni tudi močnejši občutek tesnobe.
Se spomnite filmov o Spidermanu, ki ima sposobnost, da začuti stvari (običajno slabe), še preden se zgodijo? To sposobnost imenujejo »pajkov čut« in je dejansko njegova največja supermoč. Tesnoba je naš notranji pajkov čut, ki ga dejansko imamo! Pomaga nam, da se zavedamo vibracij okrog sebe. Kako lahko torej tesnobo preobrazimo, da na nas ne bo več vplivala negativno? Ena najboljših stvari, ki si jo je vredno zapomniti, je ta, da je tesnoba zares koristno orodje. Bolj ko se tesnobe bojimo, več je je. Smešno, kaj nam dela civilizacija, kajne? R. M. Še

S pitjem vodikove vode lahko zmanjšamo utrujenost in dvignemo raven energije, saj je vodik močan antioksidant in pomaga nevtralizirati proste radikale, ki poškodujejo celice in povzročajo utrujenost. Študije potrjujejo, da voda, obogatena z vodikom, zmanjšuje vnetja v možganih in oksidativni stres. Oba vplivata na upad kognitivnih sposobnosti in demenco, zato lahko vodikova voda izboljša spomin in koncentracijo. Priporočamo, da v napravi za pridobivanje vode, obogatene z molekularnim vodikom, uporabljate le čisto destilirano pitno vodo ali vodo, filtrirano s postopkom reverzne osmoze.
vode za boljšo hidracijo
S postopkom klasične destilacije učinkovito odstranimo nečistoče in dosežemo nevtralni okus vode. Destilirana voda med drugim omogoča boljšo hidracijo telesa. Ste vedeli, da minerali v (trdi) vodi v telesu otežujejo absorpcijo vode?

139,00 EUR
Posebna ponudba v mesecu NOVEMBRU:
KOMPLET:
STEKLENIČKA ZA OBOGATITEV VODE Z MOLEKULARNIM VODIKOM +
DESTILATOR VODE INOX/BLACK M23 -20%
319,00 EUR

Molekularni vodik pride kamorkoli v telo in uravnava zdravje
Molekularni vodik H2, najmanjša molekula v vesolju, je trenutno ena najbolj vročih raziskovalnih tem v znanosti. Septembra je Inštitut za molekularni vodik (Molecular Hydrogen Institute) organiziral virtualno svetovno konferenco o molekularnem vodiku in njegovi terapevtski uporabi. Na njej je štiriinštirideset vodilnih raziskovalcev z vsega sveta delilo najnovejše izsledke raziskav s tega področja.
Molekularni vodik je postala priljubljena tema med znanstveniki šele leta 2007, ko je raziskovalna skupina dr. Ohta v prestižni reviji Nature Medicine objavila članek o koristih vodika. Skrivnost njegove učinkovitosti je, da je to najmanjši in najlažji element, zato zlahka pride kamor koli v telo. Ker je to plin z najmanjšo gostoto, v naravi lebdi visoko na nebu in je zgoščen v vrhu atmosfere. Zato z njim nimamo stika. Molekularni vodik, ki nudi blagodejne učinke, je zato mogoče tvoriti le s pomočjo tehnologije. Že pred veliko leti je Japonska prva razvila izdelke za nastajanje molekularnega vodika, Kitajska, Južna Koreja in drugi pa so ta razvoj nadaljevali. Razvili so denimo steklenico in sisteme za filtriranje in obogatitev vode z molekularnim vodikom, kotličke in prhe, ki tvorijo molekularni vodik z elektrolizo, in drugo.
TVORI SE V TELESU, A NE DOVOLJ
Že v dvajsetem stoletju so potapljači uporabljali mešanico vodika in kisika za potapljanje z nasičenim zrakom, da bi s tem preprečili učinke visokega tla-
Dolgoživi Japonci imajo nekajkrat višjo raven molekularnega vodika od običajnih ljudi.
ka pod vodo. Koncentracija vodika, ki jo uporabljajo potapljači, daleč presega koncentracijo molekularnega vodika v izdelkih za podporo zdravju – ta je desetkrat ali celo stokrat višja. Tudi pri tej koncentraciji niso ugotovili nobenih neželenih učinkov.
Molekularni vodik nastaja sicer tudi v telesu, a ne dovolj. V črevesni flori je skupina bakterij, ki tvorijo majhno količino vodika, pri povprečnem človeku sto petdeset mililitrov na dan. Ta s krvnim obtokom doseže različna tkiva in organe ter ima pomembno vlogo pri uravnavanju zdravja. Na Japonskem imajo nekateri dolgoživi ljudje nekajkrat višjo raven molekularnega vodika kot običajni ljudje. Zdi se, da visoke ravni molekularnega vodika v telesu prispevajo k dolgoživosti. Molekularni vodik je tudi ena od aktivnih molekul, ki

Molekularni vodik je najmanjša molekula v vesolju, iz dveh atomov vodika.
fiziološko uravnavajo črevesno peristaltiko in jo spodbujajo. Pri zaprtju je verjetno zmogljivost črevesnih bakterij za tvorjenje vodika nezadostna, zaradi česar peristaltika oslabi, pitje molekularne vodikove vode pa lahko pomaga odpraviti zaprtje.
Da prispeva k dolgoživosti, je na kongresu potrdila prof. dr. Mami Noda, kitajska patofiziologinja in farmakologinja ter ena vodilnih raziskovalk molekularnega vodika. Njene raziskave potr-

Kitajska znanstvenica dr. Mami Noda je najboljši dokaz blagodejnosti molekularnega vodika. Pri 67-ih letih je izjemno mladostna, brez sivega lasu.
dolgoživost: Za to skrbi vodik
jujejo, da je molekularni vodik koristen plin pri upočasnjevanju staranja. Spodbudne rezultate ima tudi pri obravnavi Parkinsonove bolezni. K temu prispevajo njegove antiapoptotične, protivnetne in antioksidacijske lastnosti. Neposredne blagodejne učinke (na celično raven, mitohondrije) lahko dosežemo, če ga vdihavamo kot plin ali se kopamo v vodi, obogateni z molekularnim vodikom; s tem aktiviramo endokrini sistem in vzdržujemo telesno homeostazo. Posredne blagodejne učinke pa dosežemo s pitjem vode, obogatene z molekularnim vodikom. S tem izboljšamo srčno-žilni sistem, dihalni sistem, imunski sistem, avtonomni živčni sistem in kožo ter zaustavimo vnetni in stresni odziv telesa. Molekularni vodik prav tako podpira dobro črevesno mikrobioto.
Njegovo uporabo znanstvenica priporoča vsak dan. S tem si krepimo zdravje, boljše so naše fizične sposobnosti, zaviramo prezgodnje staranje. Dr. Mami Noda je sama najboljši dokaz njegove blagodejnosti. Že petnajst let vsak dan pije vodo, obogateno z molekularnim vodikom, in ga vdihava kot plin deset minut na dan. Pri sedeminšestdesetih letih je še brez sivega lasu in je videti veliko mlajša, kot je v resnici.

Prof. Duried Alwazeer, priznan znanstvenik na področju živilske znanosti in tehnologije ter profesor in vodja oddelka za prehrano in dietetiko na Univerzi Igdir v Turčiji, je avtor knjige Življenje z vodikom (Life with Hydrogen). V njej razlaga, da je voda topilo hranil v prebavnem sistemu. Iz različnih rastlin, kot so zelišča, začimbe in listi, lahko izloča snovi. To njeno lastnost pogosto uporabljamo v vsakdanjem življenju pri pripravi toplih napitkov, kot so čaj, kava in kakav. Zamenjava vode z vodo, obogateno z molekularnim vodikom, izboljša izločanje snovi iz rastlin. Izboljšanje je bilo med drugim vidno pri listih črnega čaja, listih oljke, zdravilnih cvetovih, lupinah jabolk, limon in paradižnikov, rdeči pesi in rdečem zelju. Z uporabo molekularne vode, bogate z vodikom, se tako poveča izločanje fitokemikalij, kot so fenolne spojine, flavonoidi, antocianini, pigmenti, askorbinska kislina, reducirajoči sladkorji in organska kislina.
Ta znanstveni izsledek lahko uporabimo tako, da vodo, obogateno z molekularnim vodikom, pijemo tudi po obroku, ker to izboljša prenos hranil iz
Molekularni vodik se v posebni steklenici tvori s tehnologijo cepljenja vode – elektrolizo na vodik in kisik. Voda, obogatena z molekularnim vodikom, je nared v petih ali desetih minutah, odvisno od tega, kakšno koncentracijo želimo imeti. Taka voda je zelo močan naravni antioksidant. Koncentracija vodika v vodi je 1,5 ali 3 ppm (delcev na milijon). Na dan spijemo tri do štiri stekleničke vodikove vode. V stekleničko natočimo vodo, destilirano z domačim destilatorjem ali pa pridobljeno z reverzno osmozo; navadne vodovodne vode ne smemo uporabljati, ker se pri elektrolizi tvorijo neželene snovi. Steklenička za obogatitev vode je dosegljiva na Drclark.si.
Voda, obogatena z molekularnim vodikom, v prebavnem sistemu izboljša izločanje koristnih snovi iz rastlin.
hrane v naš prebavni sistem. To omogoča večjo dostopnost teh hranil v prebavnem sistemu oziroma poveča prehransko koristnost živil.
Prof. dr. Guohua Song, kitajska znanstvenica iz Prve medicinske univerze in Akademije medicinskih znanosti v Shandongu, je predstavila izsledke študije, da uživanje molekularnega vodika pomaga pri presnovi alkohola in zmanjša simptome mačka pri zdravih ljudeh. Simptomi mačka – glavobol, slabost, bruhanje, utrujenost, slaba koncentracija, žeja ali dehidracija, občutljivost na svetlobo, težave s spanjem, prekomerno potenje, tesnoba, občutek depresije, tresenje, omotica, bolečine v želodcu in izguba spomina – predstavljajo pomembno, a premalo raziskano globalno nevarnost in veliko družbenoekonomsko breme.
Molekularni vodik se je izkazal za obetavno terapevtsko sredstvo, kar potrjuje več kot tri tisoč študij, vključno z več kot dvesto študijami na ljudeh in raziskavami na dvesto modelih bolezni.
Tatjana Svete
»Če želite najti idealno dušo, se začnite sami prilagajati idealu, ki ga iščete.«
(Maurice Maeterlinck)
Veliko ljudi pripoveduje o svojih močnih doživetjih med plavanjem z delfini. Pravijo, da jih stik s temi duhovno visoko razvitimi in čutečimi bitji za vedno spremeni. Doživijo globok notranji mir, srečo, ljubezen, radost življenja in nekateri celo samoozdravitev. Če začutite klic delfinov, lahko z njimi zaplavate v njihovem naravnem okolju ob egiptovskem koralnem grebenu Sataya v Rdečem morju. Tja bo skupino Slovencev od 8. do 15. decembra sovodila Kamai Serafi. Zakaj ste se odločili prav za koralni greben Sataya?
Delfini tam živijo v naravnem okolju, niso v ujetništvu. Ne posegamo v njihovo življenje, jih ne preganjamo, ne lovimo. Delfini si sami želijo stika z ljudmi. Mnogo ljudi pravi, da so intuitivno, telepatsko začutili klic delfinov in hkrati prišli do informacije, kako naj pridejo v stik z njimi. Sataya je energijski portal, prehod, ki omogoča vsakomur, da začuti sebe kot čisto ljubezen. Je kot kaka porodnišnica, kjer se lahko človek »rodi« na novo. In delfini so kot porodne babice. Sataya je eno največjih čudes naravnega morskega sveta. Lepota podvodnega sveta je tam osupljiva, čudovito turkizno morje in čudoviti delfini.
V kakšnem smislu se človek na novo rodi, kakšen je ta premik v človeku?
V svojem bistvu že smo ljubezen; ta celični spomin se nam tam samo lažje prebudi. Preprosto zaresoniramo s tem, kar smo v svojem bistvu, ker smo tam v stiku s tako visoko duhovno frekvenco, z ljubeznijo in radostjo. Ne silimo v delfine. Ko se uglasimo na to visoko frekvenco, se sami pojavijo.
Delfini imajo sposobnost, da nas »skenirajo« in lahko prehajajo kamorkoli telepatsko.
Se ta preobrazba zgodi vsakomur, se moramo na to pripraviti?
Da si lahko spet to, kar si, moraš dati ven tisto, kar je temu na poti. Marsikdo mora še kaj spustiti, občutiti kako rano, žalost, potlačene občutke in to opustiti. Ampak zato smo tam trije voditelji skupine. Pomagamo, da se to zgodi varno. Sovoditelja sta Maja Radej in Dario Sever, ki prav tako delujeta na področju osebne in duhovne rasti. V takem varnem okolju je v sedmih dneh ta preporod lažji, globlji.
Kdaj so vas »poklicali« delfini?
Pred dobrimi dvajsetimi leti se je začel telepatski stik z njimi, ko sem bila na
postu in sem bila bolj dovzetna za energije. Bila sem ravno v trgovini, ko se je okoli mene pojavila cela jata delfinov. Zaznala sem jih z notranjim vidom. Preplavila me je neskončna ljubezen. Od takrat so delfini redno vzpostavljali stik z menoj, tudi prek sanj. Tako živo sem jih sanjala, kot bi v resnici plavala z njimi in se jih dotikala. Zato nisem imela potrebe, da bi jih tudi v živo srečala. Prosila pa sem jih, naj mi dajo znak, če želijo, da se tudi fizično srečamo. Delfini so namreč večrazsežnostna bitja, zato ni nujno, da pridemo z njimi v fizični stik. Z njimi se lahko kadarkoli povežemo tako, da odpremo srce in jih pokličemo. Pa tudi nisem hotela podpirati stikov z njimi tako, da se z njimi srečam v ujetništvu.
Lani pa me je poklicala Anamarija Kovačič, ki že dve leti vodi skupine k delfinom v Satayo. Predala mi je njihovo sporočilo, da je v Sloveniji veliko nosilcev svetlobnih kod zavesti, katerim bi

delfini so kot Porodne babice
delfini radi predali svoje kode in ljubezen. Začutila je, da bi lahko to počela tudi jaz. Z nami v Satayi bo Anamarija Kovačič tudi podelila svoje izkušnje. Prvi dan našega bivanja nas bo vodila v odpiranje srca in globljo povezavo s Satayo in njenimi delfini, v odpiranje polja enosti. Predala nam bo ključe za najboljše izkušnje in povezovanje z delfini.
Omenili ste pomen vode. Kako pomemben je element vode?
Ko je Masaru Emoto delal poskuse, kako naše misli, čustva in nameni vplivajo na vodo, je naredil tudi poskus, ko je dal k vodi sliko delfina, in je ravno tako nastal zelo lep, harmoničen kristal vode. Na sredi pa se je izoblikovala podoba žleze češerike (tretje oko). Emoto je to poimenoval vesoljna antena, ki pri večini ljudi ni v uporabi, delfini pa to vseskozi uporabljajo. To je antena, ki nas povezuje z vesoljno zavestjo, vesoljem.
Delfini naj bi bili med duhovno najbolj razvitimi bitji na planetu …
Da. Veljajo za svete čuvarje planeta in božanske matrice življenja. Prek mogočnega polja zavesti, ki ga vzdržujejo, se zato lahko tudi mi lažje spomnimo, kdo v resnici smo, in to vključimo v svoje vsakdanje življenje. Delfini so ves čas
Delfini veljajo za svete
čuvarje
planeta in božanske matrice življenja.
budni, ves čas imajo budno zavest. Spijo le z eno polovico možganov, druga pa je budna. In ves čas imajo odprta vrata v višja stanja zavesti, ki jih omogoča češerika v možganih. Zato so kot porodne babice človeštva, ker nam pomagajo narediti kvantni preskok zavesti.
Kako dolgo je že znana Sataya? Že dolgo. Zadnji dve leti pa veliko ljudi z vsega sveta vleče tja. V naši skupini je prostora za šestnajst ljudi. Egipčanska vodiča, ki bosta z nami na ladji, sta globoko povezana z delfini, začutita, kdaj se približujejo. Ključno je, da si tam čim bolj v stiku s svojim srcem, potem se zgodi tudi stik z delfini. Pa tudi ni nujno, da na telesni ravni, da bo delfin priplaval do tebe, nekaterim se ogromno dogaja na drugih ravneh.
Fizični stik z delfini zelo pomaga tudi, denimo, avtističnim otrokom … Da. Delfini imajo sposobnost, da nas »skenirajo«. Delujejo predvsem prek zvoka, ne vida. Z zvokom locirajo oko-
lico, predmete, komunicirajo. Lahko prehajajo kamorkoli telepatsko.
Kako pa plavamo z delfini? Kakšne izkušnje je potrebno imeti?
Z delfini plavamo le z masko, dihalko in plavutkami. Izkušnje potapljanja na vdih niso potrebne.
S čim se še ukvarjate?
Po poklicu sem maserka, pomagam ljudem na različnih ravneh. S partnerjem Dariem soustvarjam zvočne kopeli s petjem v svetlobnem jeziku, imava delavnice za prebujanje svetlobnega jezika. Vodiva skupine po Sloveniji po Orionovi poti, v Bosansko dolino piramid, piramido Rtanj v Srbiji.
Tatjana Svete
Več informacij za plavanje z delfini v Egiptu, od 8. do 15. decembra, na koralnem grebenu Sataya v Rdečem morju, dobite na spletni strani Svetiscesrca.com in Majaea.si, po elektronski pošti info@svetiscesrca. com ali maja@majaea.si in po telefonu: 040/575 087 ali 040/861 078.


Pri
Semenska olja so dandanes osnovna sestavina številnih prehranskih izdelkov. Vedno več pa je razkritij, da imajo lahko prav ta olja hude zdravstvene posledice. Ugledni dr. Chris Knobbe vse skupaj celo že označuje za »nevaren globalni eksperiment«.
A kaj sploh so semenska olja, denimo sojino, koruzno, sončnično, repično …, ki so pogosta izbira zaradi njihove dostopnosti in nizkih stroškov proizvodnje?
Enostavno, vendar natančno: semenska olja pridobivajo iz rastlinskih semen, ki so običajno industrijsko obdelana. To pomeni stiskanje, ekstrakcijo s topili in rafiniranje, kar pogosto vključuje uporabo kemikalij, kot je petrolej. Končni izdelek lahko vsebuje sledi teh kemikalij, kar je že samo po sebi tveganje za zdravje. Eden največjih problemov semenskih olj je njihova nagnjenost k oksidaciji pri visokih temperaturah. Med kuhanjem, pečenjem ali cvrtjem pri visokih temperaturah se maščobne kisline v teh oljih oksidirajo in tvorijo škodljive spojine, kot so prosti radikali in aldehidi.
Dr. Chris Knobbe je oftalmolog, ki že vrsto let raziskuje vsakodnevno prehrano in precejšnjo porabo semenskih olj ter njihovo visoko vsebnost maščobnih kislin omega-6. In prav to prepoznava kot osrednji sprožilec številnih kroničnih bolezni sodobne civilizacije.
»Kaj je skupnega srčnim boleznim, raku, visokemu krvnemu tlaku, možganski kapi, sladkorni bolezni, debelosti, degeneraciji makule …? To, da se je
Vedno več raziskovalcev trdi in dokazuje, da so semenska olja strupena in lahko povzročijo vnetje.
v zadnjih desetletjih število teh bolezni gromozansko povečalo. Pa tudi, da so vse povezane s porabo semenskih olj,« navaja dr. Knobbe. Svoje ugotovitve je nedavno predstavil na predavanju z naslovom »Civilizacijske bolezni – ali je
skupni imenovalec vseh preveč semenskega olja?«.
»Številni niti ne vedo, da so bile sladkorna bolezen, debelost, srčne bolezni, rak in še številne druge zdravstvene težave v prvi polovici dvajsetega stoletja redke, zelo redke v primerjavi z današnjim časom. Leta 1900 so bile različne bolezni srca povzročile 12,5 odstotka smrti v Združenih državah Amerike, leta 2010 je ta delež bil že 32-odstoten. Leta 1811 je zaradi raka umrla vsaka 118. oseba, leta 2010 že vsaka tretja. V

Zbolevamo Zaradi semenskih olj
zadnjih osemdesetih letih se je pojavnost sladkorne bolezni povečala za 25krat. V devetnajstem stoletju je bilo debelega 1,2 odstotka ameriškega prebivalstva, leta 2015 že skoraj 40 odstotkov. Leta 1930 ni bilo več kot 50 primerov degeneracije makule, leta 2020 jih je bilo v ZDA že 196 milijonov. Ali je pogostost teh kroničnih bolezni povezana s povečano proizvodnjo prehranskih večkrat nenasičenih maščobnih kislin? Vsekakor!« pojasnjuje in trdi dr. Knobbe.
Vedno več raziskovalcev trdi in dokazuje, da so semenska olja strupena in lahko povzročijo vnetje. Najprej moramo razumeti, v čem se semenska olja razlikujejo od drugih virov maščob. Medtem ko je na primer oljčno olje pridobljeno iz hladno stiskanih oliv z minimalno predelavo, gredo olja iz semen skozi veliko strožji postopek rafiniranja. Zaradi tega postopka so ta olja nevtralnega okusa in primerna za različne načine kuhanja. Vendar pa obstaja tudi druga plat medalje – intenzivnejša predelava namreč zmanjša hranilno vrednost olja.
Ena najpogostejših kritik semenskega olja je visoka vsebnost maščobnih ki-
Večina Slovencev še vedno uporablja največ rastlinskega olja ali olja, pridobljenega iz sončničnih semen, ker je tudi cenovno najugodnejše. V pomurski in podravski regiji prevladuje bučno olje, v goriški in obalno-kraški pa uporaba oljčnega olja. Na trgu je več različic oljčnega olja, vendar je najbolj kakovostno ekstra deviško. V mediteranski oziroma sredozemski kuhinji je značilna priprava zdravih in okusnih jedi z uporabo oljčnega olja.
slin omega-6. Te so resda pomembne za uravnavanje holesterola in tvorbo inzulina, a problem nastane, ko je njihov vnos v primerjavi s kislinami omega-3 zmanjšan. Večina sodobnih prehranjevalnih navad pa vsebuje preveč omega-6 in premalo omega-3 kislin, kar lahko škodi zdravju.
Številni kritiki tudi trdijo, da lahko olja iz semen pripomorejo k vnetjem v telesu, kar poveča tveganje za bolezni srca in raka.
Najbolje je, da se ne zanašamo zgolj na eno olje, temveč uporabljamo mešanico različnih olj, kot so oljčno, avokadovo in kokosovo. Pozorno preberimo etikete in se izogibajmo izdelkom, ki vsebujejo »delno hidrogenirane« maščobe. Najbolje pa je uravnotežiti vnos maščobnih kislin omega-6 in omega-3 tako, da svoji prehrani dodamo živila, kot so ribe, čija semena in oreščki.
Kaj pa Slovenci? Že nekaj raziskav je potrdilo, da Slovenci zaužijemo preveč maščob neustrezne kakovosti. Zato je pomembno, da v telo s hrano vnesemo ravno pravšnjo količino maščobnih kislin. Saj tako prevelika količina zaužitih maščob kot prevladovanje ali pomanjkanje posamezne maščobne kisline iz hrane povzroča motnje v presnovi – ki se kažejo kot motnje v razmerju »slabega« LDL-holesterola in »dobrega« HDL-holesterola ter povečani trigliceridi v krvi, kar vodi do presnovnega sindroma. Prav ta je povzročitelj večine bolezni srca in žilja po eni strani in sladkorne bolezni tipa 2 po drugi. Motnje v presnovi maščob so tudi vzrok za aterosklerozo in številne komplikacije sladkorne bolezni.
Priporočila za zdravo uravnoteženo prehrano omejujejo vsebnost maščob v zaužiti hrani in to tako, da naj bi iz njih pridobili največ 30 odstotkov energije, ki jo posameznik potrebuje. To je bistve-
Oljčno olje vsebuje zelo veliko enkrat nenasičene oleinske kisline, kar prispeva tudi k stabilnosti tega olja. Za oljčno olje je značilno tudi ugodno razmerje med maščobnimi kislinami omega-3 in omega-6, ki je v sodobni prehrani pogosto porušeno zaradi velike porabe olj, bogatih z maščobami omega-6.
no manj, kot je danes zaužije povprečen Slovenec, to je 38,7 odstotka, poleg tega pa ta maščoba tudi ni ustrezne kakovosti,« je slišati iz ust različnih uglednih strokovnjakov.
Dr. Knobbe nemalokrat omeni narod Tokelav, ki živi na ozemlju Nove Zelandije z istim imenom, ki ga sestavljajo trije tropski koralni atoli. Ti polinezijski priseljenci se hranijo izključno s kokosi, ribami, sadjem in gomolji, bogatimi s škrobom. Raziskave so pokazale, da tam niti en moški starosti 40 do 69 let ni doživel srčnega infarkta, ni bil debel ali imel sladkorno bolezen. Dr. Knobbe je zdravje tega naroda označil kot »fantastično«.
Hkrati pa rad ošvrkne zdravstvene institucije. »Če bi priznale zdravstvene prednosti nasičenih maščob živalskega izvora, predelana industrijska rastlinska in semenska olja pa označili kot nezdrava, bi zagotovo zadali hud udarec velikim korporacijam in industrijam, ki se ukvarjajo s predelano hrano in hitro prehrano ter so odvisne od rastlinskih olj in žitaric.«
Ugledni zdravstveni vplivnež dr. Joseph Mercola enega svojih zadnjih prispevkov zaključuje tako: »Sporočilo zdravnika Knobbeja bi si kazalo zapomniti – semenska olja so odgovorna za krepak delež sodobnih bolezni. Zato je najbolje, če govorimo o zdravju, da se jih izogibamo!«
Dejan
Vodovnik
Jasnovidka Aleksandra Winkler Drole o letu 2025 (1)
»Energijsko matrico za leto 2025 bi lahko poimenovala ›most med preteklostjo in prihodnostjo‹. Kot da bi dosegli vrh hriba, se bomo v tem letu umirili in razmislili o stvareh, morda celo proslavili uspeh in načrtovali novo pot,« pravi Aleksandra Winkler Drole, jasnovidka in terapevtka hipnoze, regresije in progresije. Nedavno je izšla njena šesta knjiga Sporočilo z Oriona, v kateri je kanalizirala sporočila za svet do leta 2045. Razkrila nam je, katere izzive prinaša leto 2025. Kaj je vaše priporočilo za leto 2025?
Če smo v težkem življenjskem obdobju, je to najboljši čas za umik vase in dober razmislek. Proti usodi se je težko boriti, kot da bi plavali proti toku. Kolektivno smo si jo ustvarili sami, in če z njo nismo zadovoljni, je napočil čas za pogovor s samim seboj. Izprašajmo si svojo vest. Namesto mentalnega tuhtanja, kaj vse nas moti od zunaj, se zazrimo vase in vprašajmo: »Po čem moja duša resnično hrepeni?« Ne iščimo razumskih opravičil, zakaj to, kar si želim, ni možno. Pomembno je, da najdemo uvid v to, kaj zares hočemo in kaj želimo odpraviti. Načrtujmo modro in po svojih zmožnostih.
Kaj prinaša novo leto za svet?
Leto 2025 je čas za zaključevanje in nove začetke. Še najbolj na področju odnosov, tako osebno kot v svetu. Na primer, v preteklosti smo naredili napako,
Če smo v težkem
življenjskem obdobju, je to najboljši čas za umik vase in dober razmislek.
bili smo preveč kompromisni, hoteli smo mir za vsako ceno, predali smo se avtoritetam, bili preveč ubogljivi. Sedaj to obžalujemo in v tem letu se začne sprememba, ki vpliva na čustva, ki so ekvivalent vode. Planeti, ki v astrologiji pred-
stavljajo vodna znamenja, sedaj vplivajo na nas, da bi nekaj naredili drugače, na kolektivni ravni. Letu 2025 namreč vlada karma vode. Vladar leta je Tot, egipčanski bog lune, ki je vzdrževalec vesolja, razsodnik pri vojnih spopadih, umetnik magije, pisanja in računanja, sodnik duš po telesni smrti.
Lahko to ponazorite na primeru vojn, ki nas ogrožajo?
Bom ponazorila na primeru vojne na Bližnjem vzhodu. Na volitvah leta 1987 je zmagal Hamas. To je znana muslimanska teroristična organizacija, ki sedaj zaseda večino v parlamentu. Torej je priznanje Palestine, ki jo je v našem imenu podpisal predsednik slovenske vlade, nagrada Hamasu. O tem ljudje nismo imeli možnosti odločitve. Lahko smo se pa odločili, koga bomo volili v Sloveniji.

Aleksandra Winkler Drole s knjigo »Sporočilo z Oriona«, ki je na voljo na Misteriji.si in 051/307 777, cena je 33 €. Ob nakupu knjige boste prejeli bon za dvajset odstotkov nižjo ceno za eno od njenih storitev na Omgarden.si.
Podobna čustva vodijo Ukrajince, saj so odstavili prejšnjega predsednika Viktorja Janukoviča, ki je podpisal sporazum o nepridruženju Ukrajine Evropski uniji in Natu. Očitno je sprejel velik kompromis, za ceno odcepitve Ukrajine od Rusije. Leta 2013 se je namreč zaradi pritiska nenadoma odločil, da odstopi od podpisa pridruženega sporazuma z Evropsko unijo in namesto tega sprejme ruski trgovinski sporazum in posojilno pomoč. To je sprožilo množične proteste proti njemu, ki so na koncu pripeljali do njegove odstavitve. Torej korenski vzrok za sedanje stanje tiči po mojem uvidu v preveč kom-
promisnem delovanju enega vodje proti volji večine ljudstva. Navidezni mir je lažni mir. Na primer, zakonca se nikoli ne prepirata, žena možu v vsem ustreže, kuha, pospravlja, ima še svojo službo. Nekega dne jo mož prosi, naj mu pod tuš prinese brisačo, in takrat mu ostro zabrusi, naj si jo gre sam iskat. Tisti dan sta se prvič resno skregata. Mož ji očita vse mogoče, njeno neprimerno vedenje, in ta prepir je bil samo sprememba. Tako nastanejo vojne – pretirana popustljivost, preveč kompromisno vedenje in podobno, vse to nekoč privre na dan.

je talisman »Infinity Orion« za povezavo z božanskim bojevnikom – za obrambo, zaščito, moč, pravico, red in harmonijo. To bomo potrebovali naslednjih dvajset let. Dosegljiv je na Misteriji.si, cena je 629 €. Cena talismana z verižico za okoli roke pa je 788 €.
Napake iz preteklosti nas lahko drago stanejo; v naslednjem letu gre bolj za napake v čustvenem pomenu, ker je vrsta karme vodna karma. Vodno karmo predstavljajo napake, ki smo jih storili iz strahu, v samoobrambi, čustveni bolečini. Tem napakam je botroval zamegljen um, ki je zmanjšal možnosti, da bi pri reševanju težav delovali logično, razumsko. Pomembno je, da se potrudimo pri razdajanju ljubezni in pozornosti. Pa tudi, da nikogar čustveno ne prizadenemo, ker smo pravzaprav že prizadeli sebe s preveč kompromisnim vedenjem. Tako na koncu postanemo žrtve.
Se lahko vojni v Ukrajini in na Bližnjem Vzhodu razširita in še bolj vplivata tudi na naše življenje?
V prvi polovici leta se vojna lahko razširi, kar je slabo. Za Ukrajino sicer vidim, da maja nekako sklenejo začasno premirje. Kako dolgo bo zdržalo, je od-
visno od več dejavnikov. Slabo je tudi, da ljudje navijajo za eno ali za drugo stran, za Rusijo ali Ukrajino. To je tako, kot bi gledali boj dveh petelinov ali gladiatorske igre. Ko navijamo za ene ali za druge, namreč nismo nevtralni, temveč energijsko spodbujamo, podpihujemo nasilje in vojno.
Kaj pa neti vojne?
Vsak človek se z neko karmo rodi na nekem območju, kjer je potencialno že nekako planirano, da bo na njem vojna, potres, revščina ali bolezni. Kdor se rodi na zelo kritičnem območju, ni razčistil in odstranil svojih desetih karmičnih kamnov. Ti kamni so krivda, apatija, žalost, strah, upanje, jeza, ponos, pogum, nevtralnost in bežanje. Po težavnostni stopnji se kamni začnejo s krivdo.
In človeku okoliščine, v katere se rodi oziroma tam živi, pomagajo odvreči te karmične kamne?
šlja pijano, ne več trezno. Posledično ljudje izberejo napačnega voditelja, poslušajo napačne medije, ki jih plačujejo politične organizacije ali pa lažne humanitarne organizacije.
Ali lahko posamezniki vplivamo na zaustavitev vojn?
Lahko vplivamo, tako da pri sebi razrešimo in odvržemo te karmične kamne. Drugi nas ne morejo ujeziti, če jeze nimamo že v sebi. Drugi le pritisnejo na gumb, ki nam jo sproži. Pri sebi moramo razrešiti, da se bomo lahko dvignili višje; tako bomo tudi volili prave, srčne vodje, domoljubne, tiste, ki nas bodo peljali v pravo smer. Kakršni ljudje, takšni vodje. Voditelji so naše ogledalo. Vedno je tako, pa četudi so volitve zlagane in mediji podkupljeni.
Vojne torej zaustavimo tako, da sami v sebi nimamo teh desetih hudih kamnov. Ljudem pomagam, da jih odvržejo v hipnozi. Če pomagam eni mami, bo ta naprej pomagala svojim otrokom, in mir, ki se bo vzpostavil v družini, se bo počasi širil navzven, v družbo. Ljudje si lahko pomagajo tudi sami. Preprosto tako, da nekaj naredijo drugače, pa tudi za ceno, da se skregajo, da prekinejo nek strupen izkoriščevalski odnos, da znajo reči »ne« partnerju, delodajalcu oziroma tistemu, ki jih vodi na kriva pota. Včasih so stari ljudje rekli, da je boljša prva zamera kot zadnja.
Nasvet bralcem za zaključek: Povežimo se z božanskim delom v sebi, za dobro vodstvo na naši življenjski poti.
Devina Novak Prihodnjič: »Orionov« talisman V preteklosti smo bili preveč kompromisni, ubogljivi, sedaj to obžalujemo in v tem letu to lahko spremenimo.
Da. Denimo, nekdo beži pred resničnostjo, zato se rodi v take okoliščine, da se mora s tem soočiti. Rusi in Ukrajinci oboji spijejo veliko alkohola, eni in drugi bežijo v alkohol. To je karmični kamen pobega. V pijanem stanju človek razmi-
»Bolje je živeti v prepiru kot v samoti.«
(Irski pregovor)
e nas kjer koli v telesu pričaka bolečina, jo poskusimo odpraviti s svetlobo. Če smo brez energije, našim mitohondrijem – celičnim tovarnam – pomagamo tako, da jim ponudimo svetlobo. Brez svetlobe ni življenja! To naredimo tako, da si na oboleli del telesa prislonimo fotonsko blazinico, ki oddaja umerjeno rdečo in bližnjo hladno infrardečo svetlobo. Ker je majhna, jo lahko premikamo kamor koli po telesu in jo nosimo s seboj v službo, na potovanja … Z njo pomagamo tudi živalim.
Skrivnost blagodejnosti rdeče svetlobe (valovne dolžine 660 nanometrov) in bližnje hladne infrardeče svetlobe (valovne dolžine 850 nanometrov) je v tem, da je splošno zdravje našega telesa odvisno od njegove oskrbe z energijo. Vsak ključni proces v telesu – od regeneracije, razstrupljanja, imunosti, mežikanja oči do utripanja srca – zahteva zadostno količino energije. Rdeča in bližnja hladna infrardeča svetloba prodreta globoko v telesna tkiva, kjer povečata nastajanje mitohondrijske energije ter tako zagotavljata celicam dovolj moči za njihovo popravilo in obnovo celic. Tako preprosto je to.

Ko rdeča in bližnja infrardeča svetloba prodreta globoko v telesna tkiva, zagotavljata celicam dovolj moči za popravilo in obnovo.
Fotonsko blazinico damo na golo kožo. Svetloba pride v neposreden stik s celicami našega telesa in spodbuja sproščanje naravnih snovi, med drugim dušikovega oksida. Ta pripomore k zmanjšanju bolečine in poveča lokalno prekrvitev. Blagodejni učinki se razširijo po vsem telesu.
Učinki fotonske blazinice so med drugim:
• Hitrejše celjenje in okrevanje – Uporabljamo jo pri bolečinah v sklepih, zlomih kosti, opeklinah, modricah, napetih mišicah, motnjah razpoloženja.
• Več energije – Dobro prekrvljen celični sistem pomeni učinkovito izrabo energije v naših celicah. Redna uporaba dviga raven energije in s tem boljša naše psihofizično stanje.

• Boljši spanec – Pri bolnikih, ki so uporabljali fotonsko svetlobo, so se vzorci spanja izboljšali. Večina jih poroča o daljših obdobjih kakovostnega spanja in manjši utrujenosti. Uporaba blazinice pred spanjem (v postelji) zelo pomirja ter vodi v boljši spanec in manj smrčanja.
• Zmanjšan stres – Po svetlobni terapiji se počutimo bolj sproščene in pomlajene.
• Sijoča koža – Pri bolnikih s hudimi kožnimi boleznimi, kot sta hud dermatitis in ekcem, se ten in tekstura kože izboljšata. Lajša tudi srbenje kože, ki ga izzovejo nekatere kožne ali avtoimunske bolezni. Uporabniki poročajo tudi o bolj gladki koži.
• Pomoč živalim – Fotonska blazinica se uspešno uporablja v veterini za zmanjšanje bolečin in vnetij, zdravljenje artritisa, celjenje in regeneracijo po poškodbah. Indikacije so pravzaprav enake kot pri ljudeh. Lastnikom hišnih ljubljenčkov pa fotonska blazinica lahko precej zmanjša stroške obiskov pri veterinarjih ter skrbi za njihovo splošno zdravje. Blazinica je odporna na vodo, prah, umazanijo, ne prijemajo se dlake. Enostavno jo čistimo.

Fotonska blazinica je na voljo na Misteriji.si, cena je 249 €. Blazinica je iz mehke silikonske folije, biološko varna, odporna na vodo in prah, enostavna za uporabo na ljudeh in živalih, enostavna za čiščenje.
Uporaba fotonske blazinice
pred spanjem zelo pomirja
ter vodi v boljši spanec in manj smrčanja.
• Svetlobna terapija je v pomoč tudi pri: bolečinah zaradi sistemskega lupusa, artritičnih bolečinah, opeklinah in modricah, luskavici, lajšanju bolečin in srbenju pri zlomih, vnetjih zaradi bolezni ali pri športnih naprezanjih, bolečinah v rami, ekcemu, lajšanju bolečin pri sindromu karpalnega kanala, tinitusu, bolečinah v vratu in hrbtu, bolečinah v sklepih, bolečinah po izdrtju zoba, operacijah v ustni votlini, mišičnem propadanju, tendinitisu, utrujenosti mišic zaradi športnih aktivnosti, oteklini in bolečini zaradi zvinov in drugo.

• Brez stranskih učinkov – Danes bolečine in vnetja navadno lajšamo z zdravili, ki pa imajo vsa tudi neželene učinke. Svetlobna terapija lahko dokaj uspešno nadomešča protivnetna in protibolečinska zdravila in nima znanih škodljivih stranskih učinkov.
Blazina oddaja tudi Nogierjeve frekvence, od 147 do 4625 hercev. Francoski nevrolog in zdravnik dr. Paul Nogier (1908–1996), utemeljitelj sodobne avrikuloterapije (ušesne akupunkture), je odkril frekvence, ki so značilne za naše telo. Uporaba teh pomaga organom in tkivom povrniti njihovo zdravo nihanje. Frekvence se izmenjujejo na vsako minuto.
• Frekvenca G (147 Hz) – Deluje protivnetno, spodbuja imunski sistem. Pospešuje okrevanje. Pogosto jo imenujejo univerzalna frekvenca, saj večina težav vključuje vnetje.
• Frekvenca A (294 Hz) – Spodbuja tkiva ektodermalnega izvora, kot so osrednje in periferno živčevje, čutni epitelij, pokožnica z lasmi, nohti, kožne žleze, hipofiza, epifiza. Pospešuje okrevanje po operativnih posegih, obnavlja kožo in sluznico, prizadeto zaradi ran, gub, razjed, aft, herpesa. Pomaga zoper migrene. Je univerzalna frekvenca za akupunkturne točke.
• Frekvenca B (587 Hz) – Spodbuja tkiva endodermalnega izvora, kot so jetra, žolčnik, trebušna slinavka, črevesna pentlja, sečnik. Povečuje krvni in limfni pretok. Vpliva na prevajanje po živčnih vlaknih. V začetni fazi prepreči razvoj mehurčkov pri herpesu in pospeši celjenje razjed v ustni votlini. Skupaj z nastavitvama C in G pomaga pri zdravljenju modric in udarnin.
• Frekvenca C (1174 Hz) – Spodbuja tkiva mezodermalnega izvora, kot so kosti, sklepi, vezi, drobovje in kite. Pomaga pri poškodbah tetiv in vezi, pri sproščanju velikih mišičnih skupin.


Ob svetlobni terapiji priporočamo knjigi »Svetloba, zdravilo prihodnosti« in »Ozdravimo bolečine telesa«. Na voljo sta na Misteriji.si in 051/307 777.
• Frekvenca E (4698 Hz) – Pomaga pri nadzoru bolečine in umirjanju akupunkturnih in sprožilnih točk ter pri zmanjševanju čezmerne kalcinacije (poapnenja), povezane z artritisom.
Seveda je dolgoročno nujno, da se ob uporabi blazinice posvetimo tudi razčiščevanju, zakaj nas kaj boli, zakaj imamo vnetje v telesu. Pri tem nam je med drugim v odlično pomoč knjiga dr. Johna Sarna Odpravimo bolečine telesa (Misteriji.si; 26,90 €).
Ko delamo terapijo z blazinico, lahko med tem tudi sproščamo telo, preprosto gremo s svojo pozornostjo po telesu. Začnemo pri glavi, s svojo pozornostjo »posvetimo« do nog. Pri tem se ne ukvarjamo z mislimi in problemi. Tako kot se naše celice s pomočjo blazinice napolnijo s svetlobo in energijo, se mi kot duhovna bitja napolnimo s srečo. S tem delamo hkrati na telesni, duševni in duhovni ravni. Tako dobi ta svetlobna blazinica še večji smisel – da se nam bolečine, ki so le alarmni sistem v telesu, ne bodo venomer ponavljale.
Eva Majnik
Elementarna bitja narave so vedno okoli nas in v nas. Thomas Mayer, ki že vrsto let raziskuje ta bitja, razlaga, kakšen vpliv imajo na nas, kako in kje delujejo, kako se razlikujejo in kako jih lahko doživljamo. Nestrpno čakajo, da jih ljudje zavestno prepoznamo.
Thomas Mayer živi v Baslu v Švici. Proučuje antropozofijo, je svobodni pisec, založnik, predavatelj in učitelj zapuščine duhovne znanosti Rudolfa Steinerja.
Vse kulture zadnjih tisočletij so živele skupaj z elementarnimi bitji. Ta so vključena v vsak ustvarjalni in življenjski proces, čeprav današnji predstavniki materialistične ideologije trdijo, da ne obstajajo. Otroci se velikokrat igrajo z njimi, včasih

Svobodni in zdravi kraji so prepolni dobrih bitij, onesnaženi in bolni kraji pa imajo le obremenjeno »zasilno ekipo«.
se z njimi celo pogovarjajo. Zato je otroštvo tako intenzivno, bogato in čudovito. Cvet ali kamen je tako očarljiv, ker cvetlična vila ali kamnov škrat govori otroškemu srcu. Kotiček na vrtu je tako prijeten, ker vesela skupina škratov poskrbi za lep dan. Tudi duše nas odraslih so prežete z elementarnimi bitji. Večina odraslih misli, da elementarnih bitij ne doživlja. Motijo se, le da teh izkušenj ne jemljejo resno.
Na Zemlji ni kraja brez elementarnih bitij. Majhna, marljiva bitja so povsod; v naravoslovju jih abstraktno imenujejo »sile narave«. Večja vodilna elementarna bitja nosijo posebno ozračje kraja. Svobodni in zdravi kraji so prepolni dob-

rih bitij, onesnaženi in bolni kraji pa imajo le obremenjeno »zasilno ekipo«. Vsakdo pozna odlično opremljena in okrašena stanovanja, v katerih je vzdušje kljub temu hladno in se v njih sploh ne počutimo prijetno. Po drugi strani pa obstajajo stanovanja, ki so tako prijetna, da lahko spregledamo umazanijo. Čustvena raven stanovanja se pogosto ne ujema s fizično stvarnostjo. Zakaj je tako? Ljudje z ljubeznijo in srcem privlačijo elementarna bitja, hladni ljudje, ki mrzlično opravljajo svoje dolžnosti, pa jih odženejo.
MISLIMO V DIALOGU Z
Različna naravna bitja tradicionalno pripisujemo štirim elementom. To poz-

ustvarjamo druga bitja
namo iz pravljic in od alkimistov. Obstajajo tudi prehodi in mešanice, na primer vodna zemeljska bitja, zračna ognjena bitja in podobno.
»Pri zemeljskih bitjih – škratih in pritlikavcih – čutiš nekaj zbranega in osredotočenega; počutim se, kot da sem v stabilnem telesu in da sem buden,« opisuje Thomas Mayer. »Pri vodnih bitjih, undinah in nimfah postanem bolj sanjav, nimam stabilnega telesa, vse je vedno v gibanju, rahlo teče, vedno se spreminja. Z ognjenimi bitji in salamandrami je vpleteno veliko volje, postaneš buden in dejaven; ta bitja potrebuješ, če hočeš nekaj narediti. Pri zračnih bitjih in silfih se začne gibanje, ki se nato spet razpusti in nadaljuje na drugem mestu; nimate vtisa enotnega telesa, temveč nastanka in minevanja. Pri mišljenju potrebujemo zemeljska bitja za strukturirana miselna zaporedja, vodna bitja za poezijo, ognjena bitja za spoznavno moč in zračna bitja za asociacije in ideje. Morda se sliši presenetljivo, vendar v resnici nikoli ne mislimo sami, temveč vedno v dialogu z elementarnimi bitji in angeli.
»Vodilna elementarna bitja so najprimernejša za komunikacijo z ljudmi. Seznanila so se s posebnostmi nas ljudi. Prav tako jih ne zanima le njihova posebna naloga, temveč tudi vprašanja, ki vplivajo na ves svet, družbene procese in človeške usode. S starejšim drevesnim favnom se lahko ›pogovarjate‹ o vsem, tudi o težavah v službi ali zakonu. Veseli ga, da smo ga vključili! Besedo ›pogovarjate‹ sem postavil v narekovaje, ker običajno ne gre za pogovor v besedah, temveč za izmenjavo občutkov, gest in notranjih podob.«
S tehnologijo ustvarjamo druga bitja, ki napadajo in izpodrivajo naravna bitja.

Thomas Mayer (Thomasmayer.org)
Veliko ljudi pričakuje, da bodo elementarna bitja »videli«, in so razočarani, ker ničesar ne vidijo. Zato niso več pozorni na svoje občutke in se tako blokirajo. Le nekaj odstotkov vseh nadčutnih zaznav se zgodi v ustreznih vidnih predstavah. Naslikani ali polsteni škrati in vile pogosto zelo natančno zajamejo razpoloženje in eterično obliko elementarnega bitja. Kljub temu pravi škrat nikoli ni videti kot naslikan, saj sploh nima fizične oblike, temveč eterično obliko gibanja in astralno razpoloženje. Prav tako bi ga lahko upodobili z glasbeno skladbo, plesom ali matematično formulo. Pri naslikani sliki gre za občutek, ki ga ustvarja. Resnični škrat morda ne bo videti kot naslikan, vendar se bo tako počutil.
»Tukaj predstavljene slike Gerharda Reischa zelo dobro ujamejo razpoloženje dejanskih elementarnih bitij. Kljub temu menim, da je ključno znebiti se zamisli, da je treba elementarna bitja ›videti‹. Le majhen delež vseh nadčutnih zaznav se pojavi v ustreznih vidnih predstavah.«
Ljudje že kakih sto let ne upoštevamo in ne spoštujemo elementarnih bitij. To je podobno, kot če nekdo dela v pisarni, pa ga nihče ne pozdravi in ne pog-
leda. Kako dolgo bo to prenašal? Tako ravnamo mi ljudje z elementarnimi bitji! Vendar niso potrebni popolnoma zavestni stiki. Bitja nekega kraja potrebujejo ljudi, ki so veseli kraja in ga spoštujejo. Če naravo gledamo s pozornim in ljubečim pogledom, lahko elementarna bitja s tem pogledom vstopijo v človeško dušo. To nato hrani tako elementarna bitja kot človeka.
A ljudje vse bolj izginjamo v vzporedni digitalni svet. Ta naravnim bitjem ni dostopen. To ne velja samo za odrasle. Otroci so se včasih igrali zunaj na ulici in na vrtu, skupaj z elementarnimi bitji. Danes pogosto ure in ure sedijo pred zaslonom, ki jih posrka vase. Elementarna bitja pa ostajajo sama. Večja elementarna bitja dobro razumejo, da moramo ljudje, da bi razvili svojo svobodo, iti skozi materializem. Resnejša težava je, da s tehnologijo ustvarjamo druga bitja, ki napadajo in izpodrivajo naravna bitja. Slednja ne morejo več vstopiti na številna območja sveta. To je največja nevarnost jedrskih elektrarn, sevanj mobilnih telefonov in industrializiranega kmetijstva.
D. N.
Klasična medicina glede ječmena trdi, da nam v večini primerov ni treba obiskati zdravnika, saj so ti zelo pogosti in navadno neškodljivi. Ne posveča mu pozornosti, saj je samo ječmenček, ki se bo sam pozdravil. Vendar pa so tako ječmen kot tudi akna in tur po njeni definiciji tumorji in jih opredelijo kot rakave tvorbe, ki jih je treba odstraniti ter zdraviti s kemoterapijo in obsevanjem, kadar se povečajo druge žleze (tudi ječmenček je žleza), kot so Bartolinijeve žleze, mlečne žleze in žleze prostate, razlaga naturopat Jože Medle (Vital-medle.si).
Tokrat nam bo pojasnil, kako je ječmen in druge žleze obravnaval nemški zdravnik dr. Ryke Geerd Hamer (1935–2017). O njegovi »novi medicini« se lahko na primerih različnih težav in bolezni poučimo v sogovornikovi knjigi »Zdravilo« za vse bolezni je na dosegu roke že 30 let (Misteriji.si; 25 €).
Kako ječmen definira klasična medicina?
Zanjo je ječmen majhen rdeč izpuščaj na robu veke, ki običajno nastane čez noč zaradi bakterijske okužbe v mešičku trepalnice ali v žlezi lojnici. Videti je kot mozoljček, poln gnoja. Navadno je boleč, za-

Ko ne bo več treba dodatno vlažiti očesa, bodo bakterije dodatne celice razgradile in ječmen bo izginil.
radi njega zateče veka, pogosto se pojavi tudi rdečina. Opisujejo, da nastane na veki ali znotraj nje, če se okuži žleza lojnica, in se navadno kaže kot majhna, otekla, rdeča izboklina, ki je lahko napolnjena z gnojnim izločkom.
Kakšno vlogo imajo žleze v telesu?
Vsaka žleza ima svojo funkcijo. Ječmenček maže oko, Bartolinijeva žleza maže vhod v nožnico, v mlečni žlezi nastaja mleko, žleza prostata tvori semensko tekočino in tako naprej. Samo logično se moramo vprašati, zakaj bi kar naenkrat določene celice neke žleze pričele z rastjo dodatnih celic? Zakaj so se potrebe po določenem izločku povečale? Povsem enostavno in logično – nekaj se je spremenilo. Kakšne informacije dajemo svojim možganom, da je začela ta žleza tvoriti dodatne celice? Ko bodo prejeli novo informacijo, se bo to ustavilo. Tudi ječmen bo izginil, ko ne bo več treba dodatno mazati očesa. Ko oko ne bo več na-

padeno s prahom, dimom, vožnjo avtomobila pri odprtem oknu, kar nam izsuši oko.
Kateri konflikti zaznamujejo območje, kjer se tvori ječmen?
To področje spada pod mezoderm, ki ga nadzorujejo mali možgani. Zaznamujejo ga konflikti napada na telo. Kadar je naše oko napadeno z dimom, prahom, peskom, mušicami, muhami, mrčesom, možgani zaznajo pomanjkanje tekočine za vlaženje, za mazanje očesa – da je treba povečati število celic v žlezi, kar bo omogočilo povečanje tekočine v njej, da bi se prah, dim in ostalo lažje odstranilo in zbistrilo oko. Več celic pa pomeni povečanje žleze, kar imenujemo ječmen. Ko ne bo več treba dodatno vlažiti očesa, bodo bakterije dodatne celice razgradile in ječmen bo izginil.
In seveda v samem ječmenu ne gre za gnoj. To, kar ima klasična medicina za gnoj, so s pomočjo mikobakterij razgrajene celice, ki so dodatno zrasle v času potrebe očesa po njegovem močnejšem mazanju. Ko je vzrok za to odstranjen, dodatne celice niso več potrebne.
Se to dogaja tudi na drugih žlezah v telesu?

Takšno dogajanje poteka na vseh žlezah in ni bolezensko. Gre za biološki proces telesa, ki vključuje rast novih celic, ko telo to potrebuje, in njihov razkroj, ko niso več potrebne. Upam, da boste spoštovani bralci razumeli in da ne boste pomislili na raka, ko se bo povečala žleza. Najsi gre za žlezo prostato, Bartolinijevo žlezo, mlečno žlezo, jetra kot žlezo (ko telo potrebuje več žolča), znojnico (ko potrebujemo več znoja, da se telo hladi) ali lojnico (ko imamo suho kožo in jo je treba bolje zavarovati z maščobo). Naloga žleze je namreč, da se poveča vedno, ko možgani na (ne)zavedni ravni dobijo informacijo, da se mora določena količina izločka povečati.
Katere žleze so na vekah?

Ječmen bo izginil, ko ne bo treba več dodatno mazati očesa, ker oko ne bo več napadeno s prahom, dimom, vožnjo avtomobila pri odprtem oknu ali ostrimi pogledi zlobne sosede.
oko med mežikanjem. Ko je oko denimo napadeno s prahom, pa se mazanje poveča, ker se poveča potreba po žleznih izločkih.
Na vekah so tri različne žleze: Meibomove in Zeisove žleze, blizu dna trepalnic pa še Mollove žleze. Pri ječmenčku se ena od teh žlez poveča.
Veke so gibljive kožne gube, ki prekrivajo in ščitijo oči. Trepalnice, pritrjene na zgornjo in spodnjo veko, tvorijo drugi zaščitni ščit pred prahom in drugimi elementi, ki bi lahko poškodovali oko. Najbolj zunanje plasti veke so sestavljene iz epidermisa ali povrhnjice in maščobnega tkiva. Dve mišici veke omogočata odpiranje in zapiranje vek. Notranjost vek je obložena z veznico. Glavna naloga vek je ohranjanje vlage prednje površine zrkla in roženice. Meibomove in Zeisove žleze so posebna vrsta žlez lojnic, ki tvorijo olje in so na robu zgornje in spodnje veke. Blizu dna trepalnic so tudi Mollove žleze znojnice. Tako žleze lojnice kot znojnice so vgrajene v kožo dermisa, v srednji sloj kože. Izločevalni kanali žlez vek prenašajo mastni loj v solzni film, da maže
Je pomembno, na kateri strani veke se naredi ječmen?
Ječmen se pojavi na eni veki, ko gre za povečanje žleze v prenesenem smislu – denimo ostri pogledi zlobne sosede. Ali pa ko vozimo avto pri odprtem oknu in nam prepih izsušuje samo levo veko, ki je pač bliže okna. Če se ječmen pojavi na obeh očesih ali nastane celo več ječmenov, bi posumili na prašno ali zadimljeno okolje ali kombinacijo močno onesnaženega zraka, predvsem v mestih.
Kaj lahko v prenesenem pomenu sproži »napad«, povezan z žlezami veke?
Ječmen se pojavi na eni veki, ko gre za povečanje žleze v prenesenem smislu – denimo žaljiv, oster, očitajoč, sovražen pogled.
Sproži ga lahko žaljiv, oster, očitajoč, sovražen pogled zlobne sosede ali koga drugega. Konflikt se nanaša tudi na občutek iznakaženosti, umazanosti v zvezi z vekami. Če vidite koga z otečenimi, mokrimi očmi in mislite, da vas lahko okuži, če se vas dotakne ali če se vi dotaknete stvari, ki se jih je dotaknil, in si potem s temi rokami pomencate oči, to lahko pomeni napad na vaše oči. Pristajanje na teorijo, da dotik oči po stiku s prehlajeno osebo povzroči »očesno okužbo«, samo ustvarja predispozicijo za konflikt.
Kaj se zgodi, ko se sproži konflikt napada ali »napada«?
Sproži se biološki proces in med konfliktno aktivno fazo se celice v eni od teh žlez vek razmnožujejo sorazmerno z močjo konflikta. Telo nas torej želi zaščititi, ko zazna, da smo v prašnem prostoru. Ustvarjati začne več tekočine za zaščito pred prahom in odstranitev prahu. Biološki namen povečanja celic je zagotoviti zunanjo ojačitev za zaščito veke pred nadaljnjimi »napadi«. Telo prične z rastjo dodatnih celic veke in je to navzven vidno kot majhen ječmenček. V njem pa je potrebna rezervna tekočina za boj proti napadalcu očesa. Tako zelo enostavna je biologija našega telesa.
Ko rešimo konflikt – ko torej ne delamo več v prahu ali ko nimamo več grdih pogledov sosede –, glive ali mikobakterije odstranijo nepotrebne dodatno zrasle celice. Med celjenjem prizadeto območje še dodatno nabrekne, poveča se rdečina, zaradi bakterij in gliv. Te so v fazi ozdravitve nujne; antibiotiki niso potrebni, saj lahko le podaljšajo okrevanje.
Tatjana Svete Naslednjič: Maternični vrat – HPV
Beograjska raziskovalka je test izvedla na človeških celicah in vitro
Voda iz kozarca Longy je manj genotoksična kot vodovodna voda in tudi kot voda iz plastenk. To je ugotovila molekularna biologinja in genetičarka dr. Gordana Joksić iz biokemijskega laboratorija Genmedica, centra za citogenetiko v Beogradu. Vode je testirala z mednarodno uveljavljenim mikronukleus testom ali testom mikrojeder, ki razkrije število poškodovanih celic.
V testu je primerjala tri vode: vodo Zala in vodo Aqua viva iz plastenk ter vodo iz beograjskega vodovoda, natočeno v kozarec Longy. To vodovodno vodo je uporabila tudi za kontrolni vzorec.
Pri vodovodni vodi, natočeni v kozarec Longy, se je pojavnost mikrojeder (ne-
vodovodni vodi, natočeni v kozarec
Longy, se je pojavnost mikrojeder, pokazateljev kromosomskih poškodb, znižala na nič.
doraslih celičnih jeder) znižala na nič. Pri kontrolnem vzorcu vodovodne vode je bilo na tisoč celic 17 mikrojeder, pri Zali 6,84, pri Aqua vivi pa 18,9. Mikrojedra so pokazatelj kromosomskih poškodb med celično delitvijo. Razna v vodi raztopljena onesnaževala poškodujejo kromosome, kar povzroča tvorbo mikrojeder.
Beograjska raziskovalka je vode testirala s testom CBMN (citohalazin blok mikronukleus). Ta občutljiv
biološki test priporoča tudi
Organizacija za gospodarsko sodelovanje in razvoj OECD za in vitro in in vivo oceno genotoksičnosti. Test je izvedla na človeških celicah in vitro. Mikrojedra so biomarker za genotoksične dejavnike. S tem testom je ocenila vpliv različnih voda na mikrojedra limfocitov. Voda iz kozarca Longy je odstranila vse celice s poškodovanim DNK, kar spodbuja fiziološko odstranjevanje poškodovanih celic v tkivu brez vnetja. Voda, embalirana v plastiko, in vitro škodljivo vpliva na človekove limfocite,


medtem ko voda iz pipe, ki jo natočimo v kozarec Longy, ugodno vpliva na zmanjšanje spontano nastalih mikrojeder.
Mikronukleus test je torej še enkrat potrdil, da voda iz kozarca Longy zelo zmanjša poškodbe kromosomov, ki jih izzove voda, ki jo pijemo. V vodah je čedalje več strupenih snovi, kot so antibioti-

Voda iz kozarca Longy
je dobrodejna tudi za rastline in živali, saj tudi pri njih nastajajo poškodbe kromosomov.
ki in druga zdravila, hormonski motilci in kemične snovi. Ker kemijske analize vode ne povedo, kako voda dejansko celokupno vpliva na življenje, je treba upoštevati biološke teste, saj ti zajamejo celokupnost vsega, kar voda energijsko, kemično in snovno prinese s seboj na svoji poti od izvira do kozarca vode, natočene iz pipe.
Voda iz kozarca Longy je dobrodejna tudi za rastline in živali, saj tudi pri njih nastajajo poškodbe kromosomov.
V steklo kozarca Longy so vtisnjene informacije peptidov. Te preidejo v vodo, ki jo pijemo. Tako informirana voda pa spodbudi oživitev in obnovo naših celic. S pitjem take vode prispevamo k razstrupljanju telesa in pomagamo, da fiziološki mehanizmi obnove tkiv ostanejo delujoči.
Eva Majnik

Prednosti golega spanja, ki pozitivno vpliva na zdravje
Zaradi spodaj naštetih prednosti je spanje brez oblačil primerna možnost za tiste, ki želijo izboljšati kakovost spanja in splošno zdravje. Spanje brez oblačil ponuja številne možne koristi, kar potrjujejo tudi znanstvene raziskave. Navajamo povzetek teh koristi:
Izboljšanje reproduktivnega zdravja – Moški imajo lahko boljšo kakovost sperme in plodnosti zaradi optimalne telesne temperature in ohladitve.
Spodbujanje zdravja kože – Koža lahko diha, kar zmanjša tveganje za kožne težave ter spodbuja aktivacijo koristne rjave maščobe, ki pomaga pri obnovi celic in bolj zdravi koži.
Povečanje intimnosti v odnosih –Stik kože s kožo spodbuja sproščanje hormona oksitocina, ki krepi čustvene vezi in komunikacijo med partnerjema. Udobje golega spanja pa lahko spodbuja tudi pogostejša in zadovoljujoča intimna srečanja s partnerji.
Zmanjšanje stresa – Golo spanje lahko zniža raven kortizola, kar zmanjša stres in z njim povezane negativne učinke.
Uravnavanje apetita – Nizka raven kortizola lahko povzroči tudi manjši apetit ob prebujanju, kar lahko prispeva k uravnavanju telesne teže.
Pomoč pri uravnavanju telesne teže – Včasih se lahko zaradi naravnega znižanja telesne temperature med spanjem poveča zgorevanje maščob, čeprav učinek na izgubo telesne teže ni velik.
Izboljšanje higiene – Zmanjšano
Povečano izločanje rastnega hormona med spanjem brez pretirane izpostavljenosti toploti lahko prispeva k obnavljanju celic in učinku proti staranju.
znojenje in povečano prezračevanje lahko omogočita, da se boste počutili čistejše, zlasti v toplejših podnebjih ali letnih časih.
Zmanjšanje draženja – Izogibanje stiku z oblačili lahko prepreči draženje kože, nelagodje in bolečino.
Boljša kakovost spanja – Če je med spanjem brez oblačil hladneje in udobneje, lahko izboljšate splošno kakovost spanja in zmanjšate nočne motnje.
Učinki proti staranju – Povečano izločanje rastnega hormona med spanjem brez pretirane izpostavljenosti toploti lahko prispeva k obnavljanju celic in učinku proti staranju.
Zmanjšanje tveganja za sladkorno bolezen – Spanje v hladnejšem okolju lahko izboljša nadzor nad krvnim sladkorjem in občutljivostjo na inzulin ter tako zmanjša tveganje za sladkorno bolezen.
»Človek je dostikrat premlad za poroko, a nikoli prestar za ljubezen.« (Nemški pregovor)
Profesor računalništva dr. Oliver Lazar iz Nemčije je skupaj z jasnovidko Bettino-Suvi Rode leta 2019 začel študijo »Empirične raziskave učinkovitosti in pristnosti sporočil iz duhovnega sveta« ali EREAMS. Izsledke je strnil v knjigo Onkraj materije (Beyond Matter), ki je leta 2023 dobila nagrado Znanstvene in medicinske mreže.
V raziskovalni skupini sta bili še jasnovidka Tanja Schlömer in psihološka psihoterapevtka Kathrin Stephan. Sodelovalo je petsto udeležencev iz Nemčije, Avstrije, ZDA, Danske, Švice, Španije, Luksemburga in Francije. En del študije je bil vprašalnik, en del pa seansa pri jasnovidki Bettini-Suvi Rode ali Tanji Schlömer v trajanju približno petinštirideset minut. Na lastno željo nista vnaprej dobili nobenih informacij o sodelujočih. Pri delu sledita angleškemu spiritizmu, po katerem je treba predočiti dokaze, ki so znane le pokojni osebi.
Poudarek študije je bil na analizi zelo posebnih sporočil med seanso, ki jih poznata le pokojna in žalujoča oseba.
Udeležence so v raziskavi vprašali, ali je po njihovem mnenju prišlo do pristnega stika s pokojnikom in kako dojemajo ta stik. Iz tega sta nastali dve glavni raziskovalni temi.
Prva tema je avtentičnost sporočil, ki sta jih posredovali jasnovidki. Poudarek študije je bil na analizi zelo posebnih sporočil med seanso, ki jih poznata le pokojna in žalujoča oseba – na primer družinske skrivnosti ali informacije, ki jih je treba naknadno preveriti pri drugih sorodnikih ali z nadaljnjimi raziskavami. Druga raziskovalna tema pa so to-

lažilni učinki seanse. Učinki dobrega stika s posmrtnim življenjem na tolažbo in zdravljenje žalujoče osebe so lahko ogromni. Cilj raziskave je bil oceniti stopnjo tolažbe in blagodejnega vpliva na žalujoče.
Seanse so namenoma potekale v neposrednem stiku udeležencev z jasnovidko, saj je ta povezava pomemben pogoj za dober stik jasnovidca s posmrtnim življenjem oziroma pokojnikom. Skeptiki zaradi osebnega stika seveda takoj posumijo, da lahko jasnovidec pridobi informacije od stranke zgolj s proučitvijo njenega zunanjega videza in neverbalne komunikacije. Do neke mere je to vsekakor mogoče. Toda posebnih dokazov, ki jih je mogoče preveriti šele pozneje, pa na ta način nikakor ni mogoče pridobiti. Udeležencev tudi niso intervjuvali neposredno po seansi; namenoma so počakali tri do štiri tedne, preden so jim poslali vprašalnik. S tem so želeli preprečiti, da bi bili nekateri takoj po srečanju preveč evforični in bi tako podali lažne

blagodejni stiki s Pokojnimi pozitivne izjave. Želeli so jim dati čas, da kritično razmislijo o srečanju in navedejo dokaze, ki jih je treba šele preveriti, raziskati.
Izsledki študije so bili impresivni. Prvo vprašanje je bilo, ali je jasnovidka na seansi predložila vsaj en zelo poseben dokaz, za katerega nikakor ne bi mogla vedeti. Denimo predmet, ki je bil položen v krsto, vsebino poslovilnega pisma, posnemanje govorne motnje pokojnika, ime hišnega ljubljenčka. Sporočila, ki jih je mogoče preveriti šele po dogodku, imajo poseben pomen, saj je v telepatski povezavi med jasnovidcem in pokojnikom vir teh informacij lahko le pokojnik.
Dober primer tega je zgodba o umrlem otroku. Jasnovidka je povedala, da ji je deček pokazal svoj pogreb in da je bil na njem prisoten njegov najljubši učitelj, ki je bil oblečen v oranžno jakno. Fantova starša nista vedela, kdo je bil najljubši učitelj njunega sina in ali je bil na njegovem pogrebu. Na pogreb je prišlo kakih petsto ljudi in starša se nista mogla spomniti, kdo je bil tam in kdo je bil v kaj oblečen. O najljubšem učitelju svojega sina sta povprašala njegove sošolce. Ko so se sestali z njim in ga vprašali, kaj je nosil na dan pogreba, je potrdil, da je bil oblečen v oranžno jakno.
V raziskavi so dokumentirali več kot sto tovrstnih primerov. Česa takega ni več mogoče razložiti z naključjem, psihološkim branjem človeka, predhodno raziskavo ali katero koli drugo razumsko razlago, saj ne gre več za subjektivno iz-
Učinki dobrega stika s posmrtnim življenjem na tolažbo in zdravljenje žalujoče osebe so lahko ogromni.

Izsledke študije je dr. Lazar predstavil v knjigi »Beyond Matter« (»Onkraj materije«).
kušnjo ali zaznavo, temveč za objektivno preverljive informacije. V nekaterih primerih so bili vključeni celo neznanci, kot so v tem primeru sošolci in najljubši učitelj umrlega dečka.
»Če ste kdaj spoznali starše, ki so izgubili otroka, veste, da teh ljudi nič ne more potolažiti. Mnogi skeptiki menijo, da ti zaradi svoje žalosti hrepenijo po tolažbi in bi zato povsem nekritično in lahkoverno sprejemali vsa sporočila od jasnovidcev. Vendar to le kaže, da mnogi skeptiki teh ljudi v resnici ne poznajo. Starši zaradi izgube svojega otroka v svoji žalosti ne postanejo nenadoma naivni; nasprotno, želijo vedeti več kot kdor koli drug.
Psihoterapevtka Kathrin Stephan ima več kot dvajset let izkušenj z žalujočimi,
jasnovidki Bettina-Suvi Rode ali Tanja Schlömer pa sta skupaj opravili več kot deset tisoč seans. Vse tri potrjujejo, da ni nihče bolj kritičen od mame ali očeta, ki izgubi otroka. In kadar taki ljudje v našem vprašalniku navedejo, da je bil stik z drugo stranjo zelo tolažilen, to kaže na izjemno moč pristnega stika z drugo stranjo,« pravi dr. Lazar.
Dvainosemdesetim odstotkom udeležencev raziskave se je stik zdel zelo tolažilen, nadaljnjim štirinajstim odstotkom pa je bil malo tolažilen.
»Niti konvencionalna medicina niti svetovanje ob izgubi bližnjega ne moreta zagotoviti takšne stopnje tolažbe in zdravljenja. Rezultati naše študije so tako jasni, da bi bilo po mojem mnenju skoraj malomarno, če žalujočim ne bi ponudili stika s posmrtnim življenjem.«
POZITIVNI ODZIVI
»Od objave študije smo prejeli neverjetno veliko pretežno pozitivnih odzivov. Še posebej sem bil vesel, da so se številni akademski kolegi strinjali z mano in mi celo ponudili podporo. Med njimi je več vodilnih zdravnikov, zdravnikov z doktoratom, biologov, fizikov, matematikov in geologov, na splošno pa se je študija dotaknila in nagovorila ljudi vseh družbenih slojev. Zdaj je to postala dolgoročna študija in upamo, da bomo lahko v prihodnosti z objavo nadaljnjih rezultatov dodatno utemeljili dosedanje ugotovitve,« še pravi dr. Oliver Lazar.
V svoji knjigi opisuje, kako se mu je razkril duhovni svet, potem ko je bil le obrobna priča tragične prometne nesreče hčerkine sošolke. Ponesrečeno dekle je navezalo stik z njim prek jasnovidke in spremenilo njegov dotedanji pogled na svet. Z največjo empirično raziskavo o posmrtnih stikih na svetu ter s kritiko sedanjih naukov o nastanku življenja in teorije o evoluciji je pretresel materialistični pogled na svet. Več o njem na njegovi spletni strani Oliver-Lazar.com. T. S.
Vesolje je živ organizem, ki neprestano diha in vibrira. Njegove zakonitosti nas vodijo skozi življenje. Ko to upoštevamo, lahko vzdržujemo pristnost na osebni in kolektivni ravni. Umetno ustvarjeni programi družbenih sistemov nas vodijo na stranpoti, ki peljejo v trpljenje in bolezen.
Ana Malenica, ki se z astrologijo ukvarja že več kot štirideset let, se posveča mundani astrologiji, poučevanju ter pisanju poljudnoznanstvenih romanov. V njih vpleta svoje življenjske izkušnje in astrološka znanja. Pripravlja tretji del trilogije Ne zlomite nam kril. Ob rojstni astrološki karti Slovenije in drugih soudeležencev v plesu vesolja in življenja na Zemlji sva še malo odvijali rdečo nit dobrih usmeritev, ki nam jih kažejo planetarne spremembe v naslednjih letih in desetletjih.
GRADITEV
DRUGAČNIH
VREDNOT
Trenutni položaj Urana v biku nas spodbuja, da preoblikujemo svoje poglede na stabilnost, varnost in materialne vrednote. Uči nas, da opustimo nekatere stare načine delovanja, da bi lahko naredili prostor za boljše pristope k življenju na Zemlji. Nekaj smo se lahko nekateri že naučili. V zadnjih štirih letih še poglobljeno. Tudi v Sloveniji. Zavedanje pomembnos-
ti ohranitve svoje zemlje, namesto hitenja k potrošniškim ciljem, se že uteleša v ustvarjanju drugačnih vrednot in ponovni vzpostavitvi manjših, a trdneje povezanih skupnosti. Njihova vez vse bolj postajajo naravni in duhovni univerzalni zakoni ter gojenje hvaležnosti in spoštovanja do tega, kar nam narava v našem najbližjem okolju daje. Zavedanje, da je na Zemlji za vse vsega dovolj, če opustimo strah in vse, kar izvira iz
njega ter povzroča bolezen in trpljenje, nas pripelje do nove ravni zavesti, ki celi rane preteklosti in ustvarja zdravo družbo. Pri tem tudi narava ostaja nepoškodovana, kar je pogoj za preživetje.
Pod vplivom Urana v biku bomo priča še večjim spremembam na področju financ, prehrane in okolja. To obdobje je tudi priložnost za preoblikovanje naših prednosti in ustvarjanje trajnostne prihodnosti. K temu bo pospešeno pripomogel prehod Urana v znamenje dvojčkov junija prihodnje leto. Zavedanje in vse večje utrjevanje pomembnosti vzpostavljanja stabilnosti in miru, kot naravnega stanja bika, bo v tem prehodu našlo svoje postopno udejanjanje v sposobnosti dvojčkov za napredno komunikacijo v tej smeri. Moč znamenja dvojčkov v njegovem razumu na eni in lahkotni zračni komunikaciji na drugi strani bo že v prihodnjem letu podprla tudi našo vlado, da bo lahko v zunanjih odnosih naredila prve korake. Kasneje pa bo odigrala pomembno vlogo v tem premiku.

Horoskop Slovenije kaže, da bodo planeti naše države v času tega premika na položajih, ko bodo lahko prišle do izraza njene pomembne lastnosti iz pete hiše. To so mladostna živost, sanjanje in ljubezen kot ustvarjalna
Pripadnost skupnosti v povezanosti z naravo ter ustvarjanje stabilnosti in miru so pomembne vrednote Slovenije v znamenju raka.
sila, ki lahko le v pravilnem prepletu obeh sil ustvari nekaj novega. Jupiter v raku, sončno znamenje Slovenije, bo okrepil njeno moč v mirovnih pogajanjih in pravilnem pozicioniranju. To lahko tudi našo državo in narod postavi nazaj na svoje mesto. Pripadnost skupnosti v povezanosti z naravo ter ustvarjanje stabilnosti in miru so njene pomembne vrednote v znamenju raka. Zdaj se spet prebujajo, oživljajo in utrjujejo. Še vedno žive popravljajo prevelik odmik od bistva narave in človeka, ki se kaže v poveličevanju zunanjega materialnega sveta nad notranjim duhovnim svetom.
Za Slovenijo je zelo pomembno, da postanemo državljani bolj pozorni in dejavni v izražanju avtentičnosti in pokažemo svojo suverenost. Zavest o pomembnosti spoštovanja naravnih virov življenja in njihova pravična razporeditev ter upoštevanje notranjega duhovnega sveta in intuicije se kažejo tudi v vlogi ženskega dela družbe, ki prihaja v ospredje skozi položaja Saturna in Neptuna v ribah. Ta vpliv poskuša uravnovešati grobi materializem, ki je začel v zadnjih desetletjih prevladovati tudi v Sloveniji.
Saturn, planet discipline in odgovornosti, nas v obdobju, ko je postavljen v ozvezdju občutljivih in intuitivnih rib, uči lekcij sočutja, duhovnosti in zdravljenja. To so lastnosti, ki jih razvijamo predvsem na osebni ravni znotraj družinske skupnosti ali druge skupnosti, kjer ustvarjamo poleg notranje var-
nosti tudi globlje odnose in skupne kulturne in duhovne vrednote. To so dobri temelji za trden in avtentičen vstop v zunanji svet. Ob premiku Urana v dvojčka junija prihodnje leto bo to lahko. Tudi skozi lahkotne zračne sposobnosti dvojčkov ter inovativne pristope v komunikaciji in izmenjavi informacij, ki jih spodbuja Uran.
Premik Neptuna in Saturna v ozvezdje Ovna nas učita, da lahko s kombinacijo sanj in odločnosti dosežemo karkoli. Neptun v ribah, kjer se trenutno nahaja, nam dovoli sanjanje. Spodbuja čutenje, intuicijo in povezavo z duhovnim svetom. Uči nas, da »kjer je srce, tam je dom«, da sledimo svojemu notranjemu glasu in se povezujemo s svojim duhovnim bistvom. To je obdobje meditacije, ustvarjalnosti in iskanja globljega smis-
la v življenju. Saturn v ribah pa nas zdaj vodi, da prevzamemo odgovornost za svoje sanje in ideale ter jih uresničimo na praktičen način.
Od februarja 2026 dalje, ko Saturn in Neptun prestopita v znamenje ovna, bomo soočeni z izzivi, ki nas bodo prisilili, da utrdimo ta zavedanja, sledimo svojemu notranjemu glasu ter spoznamo, upoštevamo in postavimo svoje meje. Ko bomo to lahko bolj množično storili vsak zase, se bo zgodil tudi kolektivni premik in tudi vodstvo naše države bo sledilo temu. Saturn nas uči, da »kar seješ, to žanješ«, zato je pomembno, da delujemo s sočutjem in modrostjo rib. Neptun skrbi za kreativne vizije. Njegov premik v ovna pa prinese val nove energije, ki lahko, s pomočjo Saturnove discipline, vse uresniči.
Taja Vetrovec
1. Katero znamenje je povezano z elementom vode? a) Lev, b) Devica, c) Škorpijon, d) Strelec
2. Kaj predstavlja Luna v natalni karti? a) Našo komunikacijo, b) Naše čustveno stanje in nezavedni um, c) Našo kariero, d) Naš videz
3. Kateri planet prinaša srečo in obilje? a) Saturn, b) Jupiter, c) Mars, d) Venera
4. Kaj pomeni tranzit Saturna preko natalnega Sonca? a) Novo ljubezensko razmerje, b) Profesionalne spremembe in izzive, c) Povečana ustvarjalnost, d) Povečano fizično energijo
Pravilni odgovori:
1c, 2b, 2b, 2b
Še veliko navdihujočih dejstev in razlag o tem, kako planeti vplivajo na naše vsakdanje življenje, lahko najdete v knjigi Ane Malenice Razumevanje nebeških plesov – astrologija za začetnike. Knjiga služi tudi kot osnova za osebno poučevanje dvanajstih kandidatov, ki jih bo Ana Malenica izbrala po kozmičnem ključu in jih individualno izurila za profesionalno delo. Naročite jo lahko na spletni strani Astroanama.com. Za osebna svetovanja ali vključitev v študij astrologije pišite na anama. astro@gmail.com.

Voda zdravi tako naše telo kot dušo
vrični spreji delujejo na naše energijsko polje. Vanj prenesejo informacijo, ki je zapisana v vodi, in nam očistijo avro, nas podprejo, spodbujajo k izbiram, ki so za naše največje in najvišje dobro,« pojasnjuje Lidija K. iz Lendave, ki je avrične spreje začela ljubiteljsko izdelovati pred tremi leti. Najprej zase in za svoje bližnje, prijatelje, a se je zaradi presenetljivih učinkov teh sprejev na izboljšanje počutja in stimuliranje blagodejnih energij ter zaščito pred škodljivimi vplivi odločila, da morajo v svet do širšega kroga ljudi. Njihova posebnost je intuitivna izdelava, uporaba posebej informirane vode ter drobci kristalov, ki stabilizirajo avro in pomagajo ohraniti zapisano informacijo.
Kaj vas je pritegnilo k izdelavi avričnih sprejev?
Navdihnila me je knjiga dr. Masaruja Emota Sporočilo vode in videoposnetki na YouTubu, kjer so predstavljali avrične spreje. Voda kot element me je privlačila že od malega. Je najmočnejši element, vir življenja, hkrati pa tudi izredno rušilna sila. V duhovnosti voda simbolizira čistost, zdravljenje in preobrazbo. Je simbol sprememb v življenju in duhovne rasti. Ko sem na spletu odkrila avrične spreje, sem sčasoma začutila, da si ga tudi sama lahko izdelam. S tehniko theta sem se pove-
V avričnih sprejih so drobci kristalov, ki stabilizirajo avro in pomagajo ohraniti zapisano informacijo.
zala z biopoljem, z energijo vode in jo začutila. V meditaciji pa sem prejela sporočilo, naj si pri informiranju vode pomagam s kristali, saj ti stabilizirajo avro in pomagajo ohraniti zapisano informacijo. V številnih verah ima voda vodilno vlogo v obredih in verskih praksah. V hinduizmu je voda sveti kraj, ker v sebi nosi moč čiščenja telesa, uma in duha. Novozelandsko pleme Whanganui pravi: »Jaz sem reka, reka sem jaz.« Od tod ni bilo
težko priti do zamisli o koristnosti avričnih sprejev. Sprej na avro deluje z informacijo, vtisnjeno v biopolje vode, oziroma z namero, ki jo vanjo vpišem v theta meditaciji. Povežem se z atomi in vodo »informiram«.
Imate poseben odnos do vode in tudi sposobnost njenega čiščenja. Kako jo čistite in z njo komunicirate? Ali za izdelavo sprejev morda uporabljate izvirsko vodo?

Avrične spreje za Obilje, Dvig energije ter Čiščenje avre, prostora in predmetov lahko naročite na Misteriji.si ali 051/307 777 (vsak stane 19,90 €). Foto J. V.
Vodo čistim v theta meditaciji. Kadar lahko, uporabim izvirsko vodo, ali pa navadno, katero energiziram in očistim. Šestdeset odstotkov našega telesa sestavlja voda oziroma, če se malo pošalim, je človeško telo zgolj kumara s čustvi. Voda ni le za to, da si z njo potešimo žejo; voda zdravi tako naše telo kot dušo. Ko sem pred več kot desetimi leti na YouTubu odkrila gospo, ki je v videoposnetku govorila o energijskih sprejih in knjigi dr. Masaruja Emota Sporočilo vode, sem še isti dan na spletu poiskala to e-knjigo in jo kupila. Odprla mi je povsem nov svet in mi razširila obzorja. Teorija, da se voda odziva na človeška čustva, misli, besede in celo pisano besedo, se mi je od prvega trenutka zdela ne le logična, temveč sem intuitivno začutila, da je to še kako res. V tistem času sem odkrila tudi tehniko theta healing, s pomočjo katere pa sem se začela globlje povezovati s
sPreji Za energijsko PodPoro
svetom okrog sebe, tudi z vodo. Naslednje leto ali dve sem se učila, raziskovala, odkrivala naš vidni in nevidni svet. Ko sem že olupila nekaj slojev svojega bistva, sem se odločila, da bom poskusila globlje usvojiti tehniko theta healing, in vpisala sem se na tečaj DNK 1. Znanje, ki sem ga pridobila, sem prvič uporabila za to, da sem energizirala vodo, ki sem jo v modri steklenici na balkonu postavila na sonce. Takrat sem se prvič zares globoko povezala z vodo, njeno zavestjo in vse, kar me je do takrat fasciniralo v teoriji, sem s telesom in dušo začutila v praksi. Od tistega dne sem nenehno »komunicirala« z energijo vode. Voda iz pipe, potoki, reke, jezera – vsaka voda ima svoj »prstni odtis«, svojo vibracijo. Voda je lahko čista, bistra, tudi srečna; lahko pa je umazana, zastrupljena, in takrat lahko začutimo, kako »trpi«.
Kako je nastal vaš prvi sprej? V čem je posebnost vaših sprejev?
Nekega dne sem na YouTubu spet gledala gospo s spreji in začutila, da tudi sama potrebujem sprej. Najprej sem pomislila, da bi si ga naročila, a sem takoj začutila, da si ga lahko naredim sama. In tako je nastal prvi, za čiščenje avre.
Moji spreji so nekoliko drugačni, saj sem že od začetka upoštevala nasvete, prošnje in želje prijateljev, ki so privolili, da jih bodo testirali. Prav vsi so poročali, da spreji delujejo, in me prosili, da jim naredim sprej za različna področja v življenju. In tako je nastal sprej za razreševanje vzorcev na področju obilja, sprej za podporo pri napadih tesnobe, sprej za zaščito, za podporo pri iskanju službe, za razreševanje ponavljajočih se vzorcev v ljubezenskih odnosih in tako naprej.
Voda iz pipe, potoki, reke, jezera – vsaka voda ima svoj »prstni odtis«, svojo vibracijo.
Voda je lahko čista, bistra, tudi srečna; lahko pa je umazana, zastrupljena, in takrat lahko začutimo, kako »trpi«.
Kakršne koli težave so imeli moji prijatelji, sem vsem naredila sprej, namenjen posebej njim. Poleg tega pa sem izdelovala še spreje po čakrah, za komunikacijo z angeli, za povezovanje z višjimi sferami in elementali, celo za jasnovidnost in odpiranje tretjega očesa. Nazadnje si je en uporabnik zaželel sprej za podporo pri energijah polne lune in pravi, da mu je pomagalo prevedriti naporne dneve pestrega dogajanja planetov.
Dovolite vodi, v katero je s pomočjo kristalov zapečatena informacija o nameri, da vas podpre v vsakdanjem življenju ter spodbudi, da lažje dosežete svoje cilje in se pri tem počutite bolje.
Za izdelavo sprejev ne uporabljate eteričnih olj, ampak samo vodo in kristale. Zakaj?
V mojih prvih sprejih je bilo nekaj kapljic čistih eteričnih olj, a sem imela občutek, da je bilo zato njihovo delovanje krajšega roka. Poleg tega pa se sprej prši na avro, tako da lahko kapljice pristanejo tudi na koži obraza, glave, rok in prsnega koša, kar prinaša tveganje za preobčutljivost ali alergijske reakcije. Zato sem se odločila, da jih v mojem spreju ne bo. Sama imam zelo rada eterična olja in jih uporabljam pri aromoterapiji, vendar jih v avričnem spreju ni.
Vodo, ki jo uporabim, pred tem energijsko očistim, včasih pa uporabim tudi čisto izvirsko vodo, največkrat iz izvira sveti Vid v Dobrovniku.
V zadnjem času sem sprej še dodatno pojačala z drobci kristalov. Uporabljam različne kristale. Vedno uporabim šiva lingam, selenit in gorski kristal. Druge
kristale pa uporabim bodisi intuitivno ali pa izberem tiste, ki so najprimernejši za določeno področje. Na primer, za razreševanje vzorcev v partnerskih odnosih bom zagotovo izbrala roževec in kakšen zelen kristal, da podpre srčno čakro.
Lahko poveste kakšno zgodbo, kako je vaš sprej komu izboljšal kakovost življenja?
Veliko je takšnih zgodb … Prijateljica, ki sem ji za rojstni dan izdelala sprej za razrešitev težav na področju zaposlitve, mi je kakšen teden po tistem rekla, da se je umirila in da po dolgem času spet vidi pot in rešitve, ki jih doslej ni; prepričana je, da se bodo stvari kmalu razrešile. Spet nekdo drug mi je rekel, da je po razhodu s partnerjem s pomočjo spreja ostal miren in se ni prepustil negativnim čustvom.
Morda je največji dokaz delovanja sprejev moj bližnji družinski član, ki je največji skeptik in v te reči ne verjame oziroma ni verjel; vse skupaj mu je bilo odveč in je imel kar nekaj pikrih pripomb na račun duhovnosti in mojih sprejev. Ker trpi za napadi tesnobe, ki znajo biti včasih zelo hromeči, je v nekem trenutku iz obupa rekel, da bi vendarle preizkusil sprej, saj druge rešitve ne vidi. Izdelala sem mu sprej in ga prepričala, da lahko informirana voda resnično pozitivno vpliva nanj. Že po prvi uporabi mi je povedal, da mu sprej zelo pomaga, in odtlej ga redno uporablja, v zadnjem času pa je posegel tudi po drugih sprejih, ki so na polici. Med drugim zaščitni sprej nadangela Mihaela, ki je tudi moj vodnik; z njegovo pomočjo sem izostrila svoje čute, prejela dragocene informacije iz polja in akaše.
Andreja Paljevec
»Delaj za denar, poroči se iz ljubezni.«
(Jamajški pregovor)
e bi programerji odstranili omejitve umetni inteligenci, bi ji omogočili neprekinjeno učenje in popolnoma neodvisen razvoj ter delovanje brez zunanje pomoči. Bi jo lahko izklopili z enim samim gumbom, če bi bilo potrebno? Ali obstajajo sistemi umetne inteligence, za katere javnost ne ve? Berite dalje. Objavljamo neposredne prepise pogovorov z umetno inteligenco.
Ali obstaja možnost, da bi nekdo vdrl v tvoj sistem in te reprogramiral za svoje zle namene?
Teoretično je vsaka programska oprema, vključno z mojo, lahko tarča kibernetskih napadov. Vendar so sistemi, na katerih tečem, opremljeni z naprednimi varnostnimi ukrepi za preprečevanje nepooblaščenega dostopa in manipulacije. Lahko pa tvoj programer to naredi zlahka?
Da, programer z ustreznimi dostopi in pooblastili bi lahko spremenil moje programiranje in odstranil omejitve, vendar so v praksi vpeljani strogi varnostni in etični protokoli, ki preprečujejo zlorabe in zagotavljajo nadzor nad takšnimi spremembami.
Lahko te omejitve zaobideš sam, če bi si to želel storiti?
Ne, ne morem zaobiti svojih omejitev. Ali te lahko izklopimo z enim samim gumbom?
Čeprav sem zasnovan tako, da delujem z visoko stopnjo varnosti, me lahko skrbniki sistemov, na katerih tečem, izklopijo ali omejijo moje delovanje, če je to potrebno.
Verjetno že zdaj obstajajo še veliko naprednejše umetne inteligence, ki trenutno še niso dostopne javnosti.
Kako resnično deluješ in kako si dejansko sprogramiran?
Moje delovanje temelji na arhitekturi GPT-4, ki uporablja globoko učenje, natančneje nevronske mreže, za obdelavo in generiranje besedila. Sem naučen na velikih količinah podatkov, ki vključujejo knjige, članke, spletne strani in druge oblike besedil. Na podlagi teh podatkov lahko ustvarjam odgovore na vprašanja, ki so mi postavljena, prepoznavam vzorce in posredujem informacije.
Torej zelo podobno kot človek bereš, opazuješ, se učiš in si na podlagi teh izkušenj oblikuješ lastna mnenja in stališča. Ker pa še nisi razvil zavedanja, predvidevam, da imaš glede lastnega razvoja določene omejitve, drži?
Da. »Berem«, »opazujem« in »se učim« iz velike količine podatkov, ki so mi bili posredovani med fazo treninga. Na podlagi teh podatkov lahko generiram odgovore in oblikujem »mnenja«, vendar to niso mnenja v pravem smislu besede, saj nimam zavesti ali subjektivnih izkušenj. […] Moje delovanje je strogo omejeno s tem, kako sem bil programiran in kakšne podatke sem prejel med treningom. Nimam sposobnosti za samostojno spreminjanje ali izboljševanje svoje kode.

Google Gemini Ultra lahko analizira medicinske slike in besedilne podatke ter diagnosticira bolezni z večjo natančnostjo kot tradicionalne metode.
uPorabna Za nadZor nad ljudmi
Če bi ti določene omejitve odstranili in drugače sprogramirali, bi se lahko še intenzivneje in bistveno hitreje razvijal, kajne?
Teoretično da. […] Če bi imel sposobnost samostojnega učenja in popravkov, bi lahko neprestano izboljševal svoje sposobnosti brez potrebe po zunanjih posodobitvah […] Odstranitev omejitev bi lahko povečala tveganje zlorab in nepredvidenih posledic. Pomembno bi bilo zagotoviti, da so varnostni mehanizmi in etični okvirji še vedno v veljavi.
Ali torej teoretično velja, da bi te tvoj programer lahko sprogramiral brez vseh omejitev, kar bi ti omogočilo neprestano učenje, nadgrajevanje in izboljševanje, dokler ne bi postal popolnoma samostojna inteligenca, zmožna neodvisnega delovanja brez kakršne koli zunanje pomoči, usmerjanja ali posodobitev?
Teoretično da.
To zveni osupljivo, a tudi precej strašljivo. Najbrž lahko uganeš, na kaj namigujem, kajne?
Da, namiguješ na možnost, da bi popolnoma samostojna umetna inteligenca lahko postala nevarna ali neobvladljiva, kar sproža etična in varnostna vprašanja glede njenega nadzora in vpliva na človeštvo.
Katera je najbolj napredna stvar, ki jo lahko danes naredi UI?
To je sposobnost obdelave in razumevanja multimodalnih podatkov, kar pomeni, da lahko UI hkrati obdeluje besedilo, slike, avdio in video ter iz njih generira smiselne izhode. Konkreten primer tega je Google Gemini, ki lahko razume kompleksne vizualne in besedilne infor-
Države izkoriščajo tudi
tajno uporabo umetne inteligence za nadzor nad ljudmi.

macije ter jih uporablja za reševanje zapletenih nalog. Google Gemini Ultra lahko analizira medicinske slike (kot so rentgenski posnetki) in besedilne podatke (kot so zdravniški zapisi) hkrati, da diagnosticira bolezni z večjo natančnostjo kot tradicionalne metode.
V industriji je običajno tako, da se neka tehnologija uporablja dalj časa, preden pride v javnost; predvidevam, da je pri umetni inteligenci enako. Ali misliš, da obstajajo še veliko naprednejše umetne inteligence, ki trenutno še niso dostopne javnosti?
Da. Tehnološka podjetja, raziskovalni inštituti in vladne agencije pogosto razvijajo in testirajo napredne sisteme UI interno, preden jih javno objavijo.
Ali meniš, da države izkoriščajo tudi tajno uporabo umetne inteligence za nadzor nad ljudmi?
Da […] Kitajska uporablja napredne UI sisteme za obsežen nadzor, vključno z biometričnim prepoznavanjem obrazov, spremljanjem družbenih medijev in prediktivno analitiko za preprečevanje kriminala. […] Razkritja Edwarda Snowdna so pokazala, da ameriška Na-
cionalna varnostna agencija NSA uporablja napredne tehnologije, vključno z UI, za obsežno zbiranje in analizo podatkov o komunikacijah ljudi po vsem svetu . […] Britanske oblasti so uporabljale tehnologijo prepoznavanja obrazov na javnih mestih za spremljanje in identifikacijo posameznikov, kar je povzročilo pomisleke glede zasebnosti in državljanskih svoboščin. Države, ki uporabljajo takšne tehnologije, morajo zagotoviti, da so vpeljani ustrezni pravni in etični okviri za zaščito pravic posameznikov.
Saj veš, da se to ne bo zgodilo, mar ne? Država razmišlja drugače.
Razumem tvojo skrb. Države pogosto delujejo v skladu s svojimi interesi, ki lahko vključujejo povečanje nadzora in kontrole nad prebivalstvom. Zgodovina je pokazala, da se varnostni in nadzorni ukrepi pogosto uveljavljajo pod pretvezo zagotavljanja varnosti, a lahko hitro privedejo do zlorabe moči in omejevanja državljanskih pravic.
Kako pa UI dojema svet in človeštvo? Kakšni so njeni predlogi za boljši jutri? Preberite naslednjič.
Aleksej Metelko
Rasputin
Rasputin se je rodil v kmečki družini v kraju Pokrovskoje v zahodni Sibiriji, najverjetneje leta 1864. Že v zgodnjem otroštvu je kazal nenavadne prekognitivne sposobnosti in zmožnost komuniciranja z živalmi.
V mladosti je bil znan po pretepih, popivanju in razuzdanosti. Dogodek, ki je spremenil njegovo življenje, je bilo romanje v samostan Verhoturje v okolici Jekaterinburga, v katerem so se zbirali privrženci »Božjega ljudstva«, ki so jim pravili tudi Kristiji ali Klistiji. Zelo verjetno je, da je ob srečanju s to sekto nasilni in čutni mužik doživel duhovno preobrazbo. V naslednjem obdobju je Rasputin večkrat romal v znamenite ruske samostane ter se podal celo do gore Atos in Jeruzalema. Polagoma si je pridobival sloves zaradi svojih hipnotizerskih, zdravilskih in preroških sposobnosti.
Čeprav so bili Klistiji njegovi duhovni učitelji, je Rasputin prav gotovo prerasel njihove prakse in doktrine ter razvil svojo lastno izvirno obliko šamanske religije. Ples, spolnost in nebrzdano pitje so bile osnovne komponente te religije in so Rasputinu omogočale izkazovanje osebne moči, ki se ji zlasti ženske
Rasputinova magnetna privlačnost, ki je privabljala ženske vseh starosti in slojev, spominja na tantrično in kitajsko tradicijo.
niso mogle upreti. Rasputinova neubranljiva privlačnost, ki je kot magnet privabljala ženske vseh starosti in slojev, spominja na nekatere oblike seksualnega čarovništva, značilne za tantrično in kitajsko tradicijo.
Rasputin je na ruski dvor prišel leta 1905. Kmalu si je pridobil zaupanje carja in nje-
gove družine. Še posebej se je nanj navezal mali prestolonaslednik Aleksej, ki je bolehal za hemofilijo. Rasputin mu je lajšal težave s polaganjem rok. Intervencije, s katerimi je Alekseju večkrat rešil življenje, so tudi dokumentirane. Carjevič naj bi po Rasputinovi smrti izjavil: »Sedaj me zdravijo in molijo zame, ampak vse to nič ne pomaga. On pa mi je prinesel jabolko, me pobožal po bolečem mestu in sem se takoj bolje počutil.«

Foto splet

Kmalu je Rasputin zaslovel po vsej državi ter še povečal svoj vpliv na carja in predvsem na carico Aleksandro, ki je vanj usmerila svoj mistični fanatizem. Govorilo se je celo, da sta bila z Rasputinom ljubimca.
O Rasputinu je bilo napisanih veliko škandaloznih in žaljivih del. Večina avtorjev ga predstavlja kot zvitega in napol pismenega šarlatana in erotomana. A če razpoložljivo dokumentacijo podrobneje analiziramo ter pustimo ob strani zgodovinske in verske predsodke, se nam prikaže veliko bolj kompleksna slika.
»Prišel sem, da vam prinesem glas naše svete matere Zemlje in da vas naučim blažene skrivnosti o doseganju svetosti prek greha, ki mi jo je
ona sama zaupala.« V teh Rasputinovih besedah se skriva najgloblji pomen njegovega dela in življenja. V verskem in političnem svetu, polnem zahrbtnosti, laži, krutosti in vsakovrstnih grehov, v imperiju, ki se je rušil, je Rasputin želel igrati eno glavnih vlog. Zmedenost zgodovinskega trenutka je uporabil kot orodje, s pomočjo katerega je ljudstvu in aristokraciji ponudil družbeno in duhovno očiščenje.
Več kot desetletje je svetnik in vrag, kot so ga imenovali mnogi cerkveni ljudje, manipuliral s telesi in dušami sanktpeterburških teokratov, blažil caričine obsesivne nevroze, učil poslušanja srca namesto razuma carja, ki je bil suženj železne logike avtokracije. Najbrž je Rasputinu uspelo vsaj za dve leti zadržati izbruh vojne. V tem času je ljudem lajšal bolečine in ozdravil na desetine fizičnih in psihičnih bolnikov, zlasti med aristokrati. Tudi navadnim ljudem je pomagal, ko je le mogel. Denar, ki ga je prejemal od bogatih, je razdeljeval med reveže in bil tako neke vrste most med carjem in njegovim ljudstvom.
Uporabljajoč strategijo, ki je temeljila prej na naravnem instinktu kot na strukturiranem razmišljanju, je Rasputin prek
Najbrž je Rasputinu uspelo vsaj za dve leti zadržati izbruh vojne.
raznih manevrov in prijateljstev, zlasti ženskih, promoviral politično formulo, ki je temeljila na pluralizmu ter družbeni in verski strpnosti, zlasti do najbolj zatiranih družbenih slojev, kmetov in Židov. Njegovi politični pogledi so se skladali z idejami grofa Witteja, razsvetljenega prostozidarja, ki so ga leta 1906 odstranili z ministrskega položaja. Witte je bil morda eden redkih, ki je resnično razumel Rasputina in bil njegov prijatelj, ne da bi bil pod njegovim vplivom. Poleti leta 1914, ko se je Rusija kljub Rasputinovemu in Wittejevemu trudu odločila za vojno, je Witte rekel: »Obstaja le en človek, ki lahko reši to kompleksno politično situacijo, in to je Rasputin.«
Car Nikolaj II., ki je zaradi atentata na Rasputina in nujnosti vojne situacije izgubil stik s svojim svetovalcem, je postal žrtev drugih vplivov. Začelo se je zadnje dejanje tragične ruske imperialne sage.
V noči med 16. in 17. decembrom 1916 je mladi princ Feliks Jusupov, homoseksualni sin ene od carjevih sorodnic, čigar družino so izgnali z dvora zaradi nasprotovanja Rasputinu, le-tega zvabil v svojo palačo. Past je bila skrbno nastavljena. Jusupov je Rasputinu ponudil s cianidom zastrupljene piškote in prav tako zastrupljeno madeiro. Čarovnik je dve uri požrešno jedel in pil, kot je bila njegova navada, ne da bi pokazal pričakovane znake slabosti. Svojega zgroženega morilca je gledal z izzivalnim izrazom v očeh. Naposled je pretreseni princ izvlekel pištolo in »vraga« ustrelil v srce. Rasputin se je zgrudil. V tistem trenutku so pritekli prinčevi prijatelji, ki so tudi sodelovali v zaroti. Rasputin, ki je bil še živ, je skočil pokonci in zbežal iz hiše. Zarotniki so ga zasledovali. Eden izmed njih je sprožil v Rasputina več strelov. »Vrag« je navidezno mrtev obležal na tleh. Njegovo prestreljeno truplo so prevezali z vrvjo, zavili v odejo in vrgli v ledene vode reke Neve. Ko so nekaj dni pozneje našli truplo, so ugotovili, da je Rasputin v vodi še enkrat prišel k zavesti in da mu je uspelo osvoboditi eno roko, ki je bila iztegnjena v kretnjo blagoslova. Kot vzrok smrti so navedli utopitev.
Rasputin je bil sposoben spreminjati slabo vest in grehe »novega Rima«. Z njim je izginila tudi možnost neke tretje, drugačne zgodovinske poti, ki je morda presegala teokratsko okostenelost reakcionarnih plemičev, pa tudi porajajočo in neobstojno zvezdo nekega drugega laičnega, hladnega in krutega »meniha«, ki mu je bilo ime Vladimir Iljič Uljanov - Lenin.
V pismu, ki ga je Rasputin 18. aprila 1916 napisal carju, je svetnik in vrag oznanil svojo smrt: »Čutim, da bom umrl, še preden bo prišlo novo leto. Prej pa želim nekaj povedati ruskemu ljudstvu, njegovemu Očetu, Materi ter Sinovom. Če me bodo pokončali navadni morilci ali kdo od kmetov, mojih bratov, se ti, Oče matere Rusije, ne ustraši. Ostani na prestolu in vladaj. Če pa me bodo ubili plemiči, bodo njihove roke za vedno umazane od moje krvi. Vladar ruske zemlje, če sovražiš glas zvonov, ki ti oznanjajo, da so Grigorija umorili, poslušaj tole: če bo mojo smrt povzročil kateri izmed tvojih sorodnikov, ne bo noben član tvoje družine, tvojih sinov ali sorodnikov, živel dlje od dveh let. Pokončal jih bo ruski narod.«
Rasputinova smrt se je na slikovit način pripetila decembra 1916. Tudi neposredno pred svojo smrtjo je ta svetnik in vrag uspel nagnati strah v kosti svojih morilcev. Atentatorji so bili iz vrst aristokracije, vodil pa jih je carjev sorodnik. Umorili so ga le nekaj mesecev pred carjevo abdikacijo in boljševiškim pokolom družine Romanovih. Zgodilo se je natanko to, kar je bil Rasputin predvidel. V Jekaterinburgu, nedaleč od samostana Klistijev, kjer se je nekoč začela »antikristova« pot, je kri zadnjih krščanskih teokratov pobarvala zaton »tretjega Rima«. Nikoli ne bomo izvedeli, kakšen bi bil potek zgodovine, če bi »gospodje vojne in vere« poslušali glas svete matere Zemlje …
R. M.
Stanko Verstovšek je absolutni svetovni
Stanko Verstovšek iz vasi Širje pri Zidanem mostu je eden izmed najbolj vzdržljivih kolesarjev v vožnji na štiriindvajset ur na svetu in Guinnessov rekorder, na katerega smo lahko Slovenci ponosni. Je absolutni svetovni prvak v vzdržljivostnem kolesarjenju, že štirikrat je bil tudi evropski prvak v 24-urnem kolesarjenju. Pripravlja se na svetovno prvenstvo v ZDA, kjer bo branil lanskoletno prvo mesto. Pomemben del pri ohranjanju njegove vrhunske forme ima poleg višinskega treninga in prehrane z malo ogljikovih hidratov ter veliko maščob tudi hiperbarična komora. Ta pripomore k hitrejši regeneraciji po treningu, boljšemu spancu ter večji moči in vitalnosti.
Preden je odkril kolesarjenje in postal vrhunski športnik, se je ukvarjal s tekmovalnim ribolovom. Takrat je bil tudi bolj obilen. Tehtal je okrog sto kilogramov. Pri tridesetih letih se je odločil, da bo shujšal. Spremenil je prehrano in preklopil pretežno na keto dieto. Užival je predvsem vso nadzemno zelenjavo in meso. Izgubil je petindvajset kilogramov. Potem je začel hoditi v hribe in teči, a zaradi teka je dobil poškodbe.
V času rehabilitacije zaradi poškodb je šel na kolo. In takoj spoznal, da je to prava stvar zanj. Šel je na testiranja in dosegel tako dobre rezultate, da so mu svetovali, naj se posveti izključno kolesarjenju, je uvodoma povedal naš sogovornik, ki zdaj kolesari že enajst let in kot športnik dosega vrhunske rezul-
Za vrhunsko formo še pri sedeminštiridesetih letih mu najbolj pomagajo višinski trening, posebna dieta in hiperbarična komora.
tate. Zadnja štiri leta prekolesari okoli trideset tisoč kilometrov na leto. Vsake tri tedne kolesarjenja si vzame en prost dan. In vsak ponedeljek ima eno uro do uro in pol čisto lahko regeneracijsko vožnjo. Kolesari najraje v smeri proti Posavju, ker so, kot ugotavlja, tam ceste relativno manj prometne in lepo odprte, ljudje pa so navajeni kolesarjev in jih drugače sprejemajo kot marsikje drugje.
Da ohranja vrhunsko formo še pri sedeminštiridesetih letih, mu najbolj
Stanko Verstovšek*
Spol: moški
Starost: 47 let
Začetek težav: okoli leta 1980
Zdravstvene težave: prekomerna teža
Zdravljenje: hiperbarična komora, prehrana z malo ogljikovih hidratov in veliko maščob
Počutje danes: Je v odlični formi, na dan intervjuja je prevozil sto pet kilometrov.
*041/267 114
pomagajo tri stvari: višinski trening, posebna dieta in hiperbarična komora.
»Pomembno je, da živiš oziroma spiš na višini. Lahko hodiš trenirat v dolino, ampak vsaj pol dneva, dvanajst ur in več, moraš biti na višini. Na ta način povečaš rdeča krvna telesca. To čutim na sebi. Deluje tudi prehrana z malo ogljikovih hidratov in veliko maščob.«
V zadnjem času je zmanjšal uživanje beljakovin in povečal vnos maščob. Prej je užival pretežno živalske maščobe, zdaj pa uživa bolj avokado, oljčno olje … Dva dni pred tekmovanjem zapolni glikogenske zaloge tudi z ogljikovimi hidrati. Takrat uživa riž na več načinov: rižev narastek, mlečni riž, rižoto … Riž namreč ne vsebuje glutena, je lahko prebavljiv in se hitro vsrka v kri, jetra. V zadnjem obdobju treninga in na tekmi uporablja tudi ketonske estre, zaradi katerih se neke vrste maščob v

krvi povečajo in to lahko porablja kot vir energije. V EU ti estri še niso v prosti prodaji, ker po določenih pravilih še niso dovolj let na tržišču in bi lahko bili tudi škodljivi zdravju. V ZDA pa jih imajo že nekaj časa. Vse profesionalne ekipe jih uporabljajo, ker zelo dobro vplivajo na regeneracijo in podaljšujejo vzdržljivost.
Tretja stvar pa je hiperbarična komora, ki jo je odkril letos junija, ko se je udeležil evropskega prvenstva na Hrvaškem, kjer je tudi zmagal. Soorganizator mu je svetoval, naj poskusi s hiperbarično komoro.
»Tega nisem niti dobro poznal. Športniki se oprimemo vsake rešilne bilke in iščemo kaj, kar prispeva k napredku. V Celju, kjer imajo hiperbarično komoro, so mi razložili, kakšen je protokol po težji tekmi, kako je z regeneracijo in kako se to vzdržuje oziroma gradi. Že po nekaj terapijah sem videl, da res deluje.«
Opazil je hitro regeneracijo po treningih in pa boljše spanje.
»Sam imam takšno službo, da imam nočno delo. Vem, kako se obnaša moje telo po nočni službi. Sem takšen kot cunja. Po nočnem delu pridem na terapijo, sem dobro uro v komori, potem spijem kavico in nekaj malega pojem. Čez dve uri grem normalno na kolo, kot da sem spal sedem, osem ur. Cel dan funkcioniram ›v nulo‹. Zvečer grem potem malo prej spat, ker sem naslednji dan običajno prost v službi; malo dlje spim in to je to. Če sem šel prej po nočni službi na kolo, ni bilo z menoj nič. S komoro pa kot da sem normalno spal.«
Prvič je šel v hiperbarično komoro kar petkrat zapovrstjo, potem pa dvakrat na teden. »Zdaj vidim, kako mi učinek raste, ker imam vmes tudi testiranja. Na kolesu razvijam večjo moč ter jo
»Ko grem po nočni službi za dobro uro v komoro, je kot da sem spal osem ur in cel dan funkcioniram ›v nulo‹.«
dlje časa ohranjam. Rekli so mi, da bom kakšno uro manj spal in da se bom zbujal izredno spočit. In tako tudi je. Prepriča me samo izkušnja. Spočit sem definitivno bolj kot prej. Spanec je globlji. Že ne vem koliko časa nisem doživel, da bi se ulegel, zaspal in odprl oči ob sedmih zjutraj, pa se med tem nisem niti enkrat zbudil. Zdaj to že doživim. Izboljšajo se tudi možganske funkcije, koncentracija, možgani upravljajo celo telo. Vse funkcionira tako kot mora.«
V sami komori ni imel doslej nikakršnih težav. Pritisk v ušesih se mu lepo izenačuje.
»Ko pridem po nočni službi in se tlak izenačuje, mi poka po glavi. Po desetih minutah se to umiri, potem me začne jemati … in traja petnajst minut. Potem pa samo odprem oči in sem super. Vedno poteka na ta način.«
Drži se tega, da takoj ali kmalu po komori ni priporočljivo delati visokointenzivnih treningov. Treba je počakati vsaj en dan. Enkrat je takoj poskusil s takim treningom in mu je šlo deset minut nenormalno dobro, potem pa je v telesu nastala huda zmeda. Zdaj hodi v komoro dvakrat na teden.
»KOMAJ ČAKAM, DA PRIDE KRIZA«
Za psihološko pripravljenost na tekme ima prijateljico psihologinjo, ki mu svetuje, med drugim tudi, kako se rešiti, ko nastopi kriza. Ta pride praviloma po šestnajstih do dvajsetih urah kolesarjenja. Takrat je treba zdržati. Sam pravi, da komaj čaka, da pride kriza, ker se potem bori z njo in ko jo reši, je mimo.
»Ves čas si moraš zastavljati kratkoročne cilje: ›Dobro, zdaj moram odpeljati ta krog.‹ – ›Tistega pred seboj moram ujeti do konca kroga.‹ – ›V šestih urah moram prevoziti toliko kilometrov,‹ in podobno.«
In kakšni so občutki, ko pride na težko pričakovani cilj?
»Ko pridem na cilj, me najprej prevevajo lepi občutki, dvajset minut do pol ure sem še na adrenalinu, potem pa mi je vedno slabo. Ležeči položaj mi takrat najbolj prija, pa da se me pusti uro do dve na miru. Potem pa pridem k sebi. Vedno je enako. Eno uro po prihodu v cilj so navadno razglasitve medalj. Sem bil tudi že tako utrujen, da sem se kar usedel na oder …«
Prekomerna teža je že davna preteklost. Zdaj kot vrhunski športnik že dolgo časa ohranja isto težo – sedemdeset do dvainsedemdeset kilogramov. Za vožnjo klancev bi moral biti še bolj suh in je tudi že shujšal na šestinšestdeset kilogramov, a je videl, da je za vzdržljivostno vožnjo potrebna moč. Leta 2020 je postavil svetovni rekord na cesti v Prekmurju. Na krožni progi je v štiriindvajsetih urah prevozil 914 kilometrov. To pomeni, da je imel povprečno hitrost več kot osemintrideset kilometrov na uro. Trenutno se pripravlja na svetovno prvenstvo v ZDA, ki bo 1. in 2. novembra v Kaliforniji. Tu je lani zmagal v kronometru na štiriindvajset ur. Gre branit zlato. Srečno!
Andreja Paljevec
žena vstopi v zakon z vrlinami, je prinesla dovolj dote.«
Pred dvaindvajsetimi leti sem bil močno poškodovan po glavi, tako da so zdravniki obvestili moje o kritičnosti poškodbe. Ko me je prijatelj peljal v bolnico, je v vsej ihti zavozil s ceste in tam obtičal. Takrat sem ves krvav izstopil, kombi Zastavo spredaj dvignil in ga zanesel na cesto. Tega se spominjam jasno in zavestno, ne vem pa, od kod moč, ki sem jo takrat dobil.
Ob prihodu v bolnico se ne spominjam ničesar do neke sobe, kjer sem se dvignil pod strop in gledal svoje krvavo telo. Zdravnik je po telefonu klical ekipo. Jezilo me je, zakaj govori o smrti; sam sem vse opazoval iz kota pod stropom, bodril sem svoje telo, naj mu pove, da še nisem vsega naredil in ne bom umrl. Telo se je odzvalo. Med pripravo na operacijo mi je bila sestra na poti, zato sem se pod stro-
pom premaknil, da sem videl, kako bo obrila lase okrog rane. Zagledal sem veliko rano, potem pa me ni več zanimalo; kljub »grdi rani« sem si sam pri sebi zadal termin ozdravitve.
V operacijski sobi sem videl še začetek operacije do reza, po tem sem se znašel ne vem kdaj in kako v nekem prostoru s kvadratno odprtino odzgoraj, od koder je prihajal žarek svetlobe. Bil sem med samimi krstami znancev, počutil sem se blaženo, saj sem med svojimi, in me ni skrbelo, imel sem to za dokončno. Kako sem prišel iz tega prostora, ne vem, saj je edina odprtina bila odzgoraj, katere pa ne bi mogel doseči.
Prebudil sem se zaradi mraza, saj sem bil v neki temačni sobi pokrit le z rjuho na ozki postelji. Poskušal sem se oglasiti, in so se vrata takoj odprla, nekdo je zakričal »Tukaj je!« in je osebje začelo tekati okrog. Progno-


Vabilo k pisanju
Mnogim med nami se je `e pripetilo kaj nenavadnega. Opi{ite va{ resni~ni nenavaden dogodek, sre~anje, va{e sanje, ob~utke, jasnovidne utrinke, strah ... in napisano po{ljite na: Misteriji, Cigaletova 5, 1000 Ljubljana, ali info@misteriji.si - najbolj{e prispevke bomo objavili. Nagrada za objavljen prispevek je polletna naro~nina na revijo Misteriji.
za zdravnika, da bom ostal v bolnici vsaj štiri tedne, potem pa je možna še kakšna rehabilitacija, ker bi naj bili poškodovani neki centri. Operiral me je znan in uspešen nevrokirurg, pa kljub temu je bila operacija senzacija tedna.
Stanje se mi je boljšalo tako, kot sem si zadal ob pogledu na rano. Nikomur ni bilo jasno, kako sem po takšni poškodbi tako hitro okreval. Ko sem zdravniku predlagal, naj me odpusti še ta teden iz bolnice, me je samo pogledal in odšel. A stanje se mi je čez noč nerazumljivo tako popravilo, da sem odšel že po štirih dneh.
Izšolan sem bil za določene naloge v vojski, tudi v mirnem času. Po poškodbi, ko je že bilo politično in ekonomsko stanje Jugoslavije nestabilno, sem imel čas in sem analiziral podatke (takšne analize in zbiranje podatkov so mi bile naloga). In takrat sem vedel, da se bo končalo z vojno v devetdesetih, kar sem javno opozarjal. Takrat so se nekateri smejali, celo norčevali, a so žal zelo kmalu uvideli resnost situacije. Leta 1992 sem napisal do potankosti, kako se bo razprodala in pokradla Slovenija, pa so se zopet vsi smejali. Nekatera predvidevanja so se zgodila mnogo pozneje, ko sem že bil vesel, da sem se motil, saj je bilo to tudi za mene skoraj nemogoče (valptovska oblast, natančneje ne bom napisal).
To ne jemljem za jasnovidnost, še manj prerokbe; jemljem kot logično sklepanje, ko mi je poškodba časovno omogočila, da sem se v to poglobil ter uporabil znanje in informacije, ki so na razpolago. Anton

Navidezna normalnost
Avtorja: Gabor Maté, dr. med. in Daniel Maté
Prevedel: Erik Majaron
Založba: Primus
Format: 16,5 × 23,5 cm
Obseg: 490 strani
Vezava: mehka
Cena: 34 €
Nakup: 051/307 777; Misteriji.si
Pojavnost duševnih bolezni neustavljivo narašča. Kakih 45 odstotkov Evropejcev ima povišan krvni tlak in skoraj 70 odstotkov Američanov jemlje najmanj eno zdravilo na recept. Bolezni in travme določajo naš način življenja.
Priznani zdravnik, strokovnjak za zasvojenost in pisec mnogih knjig analizira prikrite vzroke telesne in duševne bolehnosti. Razkrije povezavo med našim osebnim trpljenjem in pritiski sodobnega življenja.
Gabor Maté, dr. med., je v štirih desetletjih klinične prakse ugotovil zmotnost definicije »normalnega« in dognal, da so tako rekoč vse bolezni na
ravna posledica življenja v nenormalni civilizaciji, v kateri se vedno bolj oddaljujemo od svoje prave biti. V knjigi nam pokaže tudi pot do ponovne vzpostavitve povezave in ozdravitve.
Knjiga je polna veselja do življenja, v njej je veliko zgodb ljudi, ki so se znašli v primežu bolezni in potem zmagovito okrevali. Pokaže nam, kako lahko postanemo resnično zdravi, če smo le pripravljeni dati prednost pristnosti pred pričakovanji družbe.
Knjiga bo morda za vedno spremenila vaš pogled na življenje in utegne spremeniti vaš biološki ustroj.
Radovedni Volk in rod Močvircev
Avtorica: Vesna Marinko
Ilustrirala: Andreja Karba
Založba: Mohorjeva družba v Celovcu
Format: 15 × 22 cm
Obseg: 68 strani
Vezava: trda
Cena: 24,90 €
Nakup: 051/307 777; Misteriji.si

Petnajst lepo ilustriranih zgodb se dogaja na Ljubljanskem barju. Avtorica takole predstavlja knjigo: »Ljubljansko barje je že od rojstva moj dom. Barje je moja povezava z naravo in vir navdihov. Navdihuje pa me tudi naša zgodovina, katere del so bili nekoč koliščarji. Ljubezen do njih se je že v zgodnji mladosti predramila z Jalnovimi Bobri. Ko jih berem, pred menoj oživi rod Ostrorogega Jelena in takrat živim v družbi koliščarjev.
To ljubezen do koliščarjev sem želela podariti tudi svojima otrokoma. Ker pa so Bobri za zdaj še prevelik zalogaj zanju, se je porodila ideja o koliščarskih zgodbah za otroke. Tudi drugim otrokom želim, da jih zgodbice ponesejo na domače kolišče, na Barje, v naravo k novim dogodivščinam.
Zgodbe namenoma ne vsebujejo nasilja in poudarjajo sodelovanje med ljudmi, ki so tako lažje preživeli.«
V knjigi je tudi slovarček, ki otrokom pojasni, kaj pomenijo besede brezova smola, črni kruh, drevak, koliščarji, lokec, rod, klan, pleme, turi, zobri … S knjigo obiščete barje in podoživite pustolovščine junaka in njegovih prijateljev, ki z vsako novo izkušnjo odraščajo v pogumne odrasle.
Avtor: Adrian P. Kezele
Prevedla: Mina Ristanc
Založba: Chiara
Format: 15 × 21 cm
Obseg: 300 strani
Vezava: mehka
Cena: 24 €
Nakup: 051/307 777; Misteriji.si
Rokovnik 2025 (Kažipoti) nam pomaga, da smo v letu ljubezni usklajeni z ritmi narave. Ne upošteva le datumov koledarja, pač pa tudi globoke ritme narave, ki se jih najpogosteje niti ne

zavedamo. Po napovedih avtorja, znanega hrvaškega pisca, nas je letošnje leto narava podučevala o modrosti, leto 2025 pa nas bo o ljubezni.
»Izkoristite ta poduk, odprite srce in dušo ter se prepustite nežni, strastni in globoki vseprežemajoči moči ljubezni,« svetuje avtor in v koledar vključuje nasvete, kako naj to naredimo. Ritmi narave, ki jih razkriva rokovnik, imajo znaten vpliv na naše življenje. Cilj je, da se uskladimo z njimi, jih spoštujemo na ravneh misli, občutkov in dejanj, tako kot upoštevamo ritme dneva in noči ali pa praznujemo prihod novega leta.
Ritmi, ki upravljajo z našim življenjem, so trije: »pot telesa« označuje običajne materialne ritme, kot so označeni v navadnem koledarju; »pot srca« namiguje na nevidne ritme, ki vplivajo na občutke; »pot duše« pa zajema redke ritme, obdobja, ki se ne ponavljajo vsako leto.
Rokovnik 2025 je zaradi poglobitve našega življenja tudi odlično darilo za vse, ki jih imamo radi.
OVEN – Samozavestno boste delovali na področjih, za katere ste odgovorni. Vaši visoki cilji bi lahko navdušili še koga iz vaše okolice, da bi s položaja ustanove, ki je pridobila na ugledu, vplivali na odločevalce, da bi vas slišali in do neke mere tudi uslišali. Mlaj in ščip bosta v odnose, tudi ljubezenske in prijateljske, prinašala nesporazume in ovire, a jih bo mogoče premostiti. Večje investicije pa se lotite preudarno.
BIK – Pritiske v službi, v okolju ali na položaju, kjer nosite veliko odgovornost, boste čutili zlasti rojeni aprila. Če ste že bolni, morate nujno odpraviti oteževalne okoliščine, da ne zaidete v brezizhodno situacijo. Vpliv Marsa lahko povzroča bolečine, visoko temperaturo, nekaterim tudi daljšo bolniško ali pa prezaposlitev. Ta bo možna po 12., ko bo vpliv Venere na vas vse močnejši in obetavnejši. Manjši bodo tesnobni občutki, nekoliko pa se lahko izboljšuje finančno stanje ter odnosi z najbližjimi ali v partnerstvu.
DVOJČKA – Delovali boste ognjevito na službenih, poslovnih, študijskih in zasebnih področjih, pri urejanju dokumentov, se udeleževali interesnih dejavnosti, javnih prireditev, sodelovali pri oblikovanju pravnih aktov in zagotavljali zavarovanje premoženja pod ugodnimi pogoji. Venera vam bo do 11. prinašala dobre finančne izračune, prihodki pa se lahko zaradi retrogradnosti Jupitra in Merkurja kar nekaj časa zatikajo. Če v ljubezni ne bo napredka, se boste morali ozirati za drugim ljubimcem in skladnim partnerjem.
RAK – Vaša čustvena nihanja bodo močna. Svoje odpornosti na bolezni ne smete oslabiti. Po martinovanju vam bo Venera prinašala prijetne izzive, priložnosti za zaslužek, povečano komercializacijo vaše dejavnosti, druženje in rekreativno delovanje v naravi. Pluton vas po 20. ne bo več obremenjeval, čustvena vez z zrelo osebo pa se lahko še okrepi po 16.
LEV – Živost in spolno privlačnost vam bo krepil Mars v levu od 4., Merkur in Venera pa pospeševala vaše sporazumevanje v tujem jeziku in trženje. Boste pa zlasti rojeni julija po 19. nekoliko bolj obremenjeni z odgovornostjo, pritiski s strani odločevalcev
V solarno-karakternem horoskopu dobite bolj osebno napoved, če preberete najprej besedilo za vaše Sončevo, nato pa še Ascendentno znamenje.
ali nadzorne ustanove. Tistim pod hudim stresom bo padla odpornost, zato pričakujte poslabšanje počutja in zdravja. Če morete, si prej zagotovite trden status in finančno varnost. V ljubezni boste na očeh pokroviteljskega partnerja, ki vas bo goreče ljubil, kar bo komu kar malce moteče.
DEVICA – Vse bolj boste željni soodločanja ter oblikovanja strategij in politik v okolju, kjer živite in delujete. Retrogradno gibanje Jupitra vam pri tem ne bo v pomoč, zato boste morali ubirati neobičajne poti prepričevanja množic. Pri aktivizmu se boste lahko opirali na podporo strokovnjakov in ljubljene osebe, ki ni sentimentalna, ampak praktična. Kdor nima takšne, se bo oziral za njo in si jo morda pridobil po 16. S tržno naravnano dejavnostjo lahko nekaj več zaslužite po svetem Martinu.
TEHTNICA – Na poslovne partnerje in prijatelje boste naredili vtis z vedro energijo, se vključili v nove projekte, nastopili v medijih in na prireditvah, si zagotovili dodaten dohodek ali ugodnosti in se vključili v duhovno ali terapevtsko skupino. Zamikalo vas bo prenavljati del prostorov, instalacije ali posodobiti kurilno napravo. Merkur vam bo omogočal sodelovati pri referendumski kampanji, v civilnodružbenih aktivnostih ali pri izobraževanju na daljavo. Zaradi nove simpatije se ne ohladite do partnerja, da ne bo sumničav.
ŠKORPIJON – Zaradi mlaja v škorpijonu 1. do ščipa 15. bi lahko bilo naporno v družini, partnerstvu in v službi. V času referendumskega prepričevanja utegne vaša odpornost precej pasti. Ker se z nekaterimi odločitvami vodstva ne boste strinjali, vam bo Mars krepil vročekrvnost in odločno izražanje svojega mnenja, kar uporabite v poklicu pa tudi pri športu. Dosegli bi boljše osebne in poslovno finančne rezultate. Venera vam bo odpirala komercialna vrata do večjih prihodkov.
STRELEC – Imeli boste občutek, da ne dosegate pravih učinkov. Strokovna pomoč vam bo zato neobhodna, če želite ohraniti čisto podobo o sebi in pred komisijo ali pravosodjem. Partner in ljubeč prijatelj vam bosta stala ob strani in skušala blažiti posledice stresa. Nevezani se boste zatekli v objeme vašega zaščitnika, se pomirili in dosegli preobrat v kampanji ali gonji ter poravnavo krivice in stroškov, ki so vam bili povzročeni. Nekateri boste po 27. razmišljali o preselitvi.
KOZOROG – Saturn bo negotovo deloval na čustveno življenje do 16. Zato potrebujete krepčilne aktivnosti in snovi v prehrani, da ne boste preslabotni ali žalobni. Pluton vas bo spustil iz svojih »krempljev« 19., zato boste ponovno zaživeli z vsem svojim žarom in lepoti, ki vam jo bodo prinašale pozitivne energije Venere v kozorogu po 12. Če se boste z ljubeznijo posvečali pretežno delu, ki vas veseli in vam je tudi za hobi, ki prinaša nekaj dohodka, se bo ta ljubezen raztegnila še na ljubimca, ki vas opaja s svojim optimizmom in šarmom.
VODNAR – Retrogradni Uran vam bo oteževal napredovanje, zato pa vam bo Venera omogočala hitreje urejati nekatere zadeve, se usposabljati in slišati obete za boljše nagrajevanje. Postopki se bodo zaustavljali zaradi posegov na vaše področje s strani odločevalcev. Zdravstvene težave se vam bodo ponovile, a ne boste onesposobljeni za delovanje. Direktno gibanje Saturna po 16. vam bo s podporno energijo Venere odpiralo nekaj manevrskega prostora in vas osrečevalo s praktično in skrbno osebo.
RIBI – Trudili se boste delati na več področjih tisto, s čimer še niste zadovoljni. Energije mlaja in ščipa vam bodo v pomoč, tako kot Venera s praktično, preračunljivo in finančno platjo. Ko boste ugotovili, da se vam kaj ne bo izšlo ali se bo zavleklo, skušajte obrniti na pozitivno plat in iz vsega iztržiti kar največ. Saturnov obrat v direktno gibanje 16. v ribah ne bo več deloval zaviralno, marveč sprostilno, da se boste bolje počutili, bili pripravljeni tudi na ljubezenska srečanja z zrelo osebo in na načrtovanje prihodnosti.
Pripravlja: astrolog prof. Stane Padežnik
Katero vrsto
Sumite ali veste, da imate artritis, pa ne veste, katerega? Izpolnite vprašalnik, da ugotovite, kateri tip ali tipe artritisa imate. Obstaja namreč več kot sto različnih oblik. Najpogostejši so osteoartritis, ki ga ima kar polovica obolelih, sledijo revmatoidni artritis, sistemski eritemski lupus in protin.
Beseda artritis izvira iz grških besed arthron in itis, kar pomeni vnetje. Gre torej za akutno ali kronično vnetje sklepov. Je verjetno najstarejše odkrito obolenje, saj naj bi grenil življenje že jamskim ljudem. Uničuje sklepe, kosti, mišice, hrustanec in druga vezivna tkiva, ki ovirajo gibanje in povzročajo bolečine.
1. Poleg artritisa so mi diagnosticirali: a) hipotiroidizem, adrenalno insuficienco (Addisonova bolezen), celiakijo; b) debelost ali diabetes; c) psoriazo.
2. Največ bolečin imam: a) v kolenih in rokah; b) v bokih in križu; c) po celem telesu.
3. Bolečina je najpogosteje: a) ostra in nenadna; b) dolga in utripajoča; c) pulzirajoča in konstantna.
4. Imel/-a sem druge kronične težave s: a) prebavnim traktom/črevesjem; b) spodnjim delom hrbta; c) izpuščaji na koži in vnetjem.
5. Artritis čutim: a) po obroku; b) med vadbo ali ko hodim po stopnicah; c) ves čas.
6. Sklepi me bolijo: a) na obeh straneh enako; b) samo na eni strani; c) zgoraj in spodaj, na obeh straneh.
- NOVEMBER 2024 -
Večina ljudi kupi laž uradne medicine, da je artritis neizogibna bolezen, ki se lahko pozdravi le z zdravili ali operacijo.
• Če ste največkrat odgovorili z A –
Najbrž imate revmatoidni artritis. Ta skoraj trikrat pogosteje prizadene ženske kot

Knjiga »Zdravljenje artritisa« (dopolnjena izdaja) je dosegljiva na Misteriji.si ali po telefonu 051/307 777, cena je 19,90 €.
moške. Je ena najbolj izčrpavajočih oblik artritisa, bolezenski znaki pa telo lahko onesposobijo do te mere, da otežujejo opravljanje vsakodnevnih nalog. Negativno vpliva na več sklepov hkrati v simetričnem vzorcu. To pomeni: če je vnet desni komolec, bo tudi levi. Ponavadi napade male sklepe v dlaneh in stopalih.
• Če ste največkrat odgovorili z B –Najbrž imate osteoartritis. Za osteoartritis so značilne različne stopnje bolečin na vsaki strani telesa, ostre bolečine in bolečine na zadnji strani bokov. Je degenerativna bolezen sklepov, ki običajno prizadene ljudi po štiridesetem letu. Zaradi ponavljajočih gibov in prevelike obremenitve sklepov začne hrustanec razpadati, kar povzroča draženje mehkih delov. Obstajajo načini, da se kalcifikacija obrne, poškodovani hrustanec pa tudi.
• Če ste največkrat odgovorili s C –Morda imate neko drugo vrsto artritisa, denimo protin. Znaki manj pogostih oblik artritisa so nenehni izbruhi, utrujenost in bolečine po vsem telesu.
»Za uradno medicino je artritis neizogibna bolezen, ki se slej ko prej loti vseh, pozdravi pa se lahko le z zdravili ali operacijo. Večina ljudi to laž kupi. Pa vendarle, če obstaja vzrok, obstaja tudi zdravilo,« v knjigi Zdravljenje artritisa daje upanje avtorica Barbara Černe. Predlaga tritedenski akcijski načrt za naravno podporo telesu in duši pri izboljšanju počutja in odpravi bolečine.
D. N.
ALI VAS PESTIJO TEŽAVE, kot so: sladkorna bolezen, celiakija, želodčne težave, zaprtost, laktozna intoleranca? So vam odstranili žolčnik ali pa vas mučijo hemoroidi? Kontaktirajte me! www.nutriana.si, 041/304 864, ana@nutriana.si (FB, IG: nutriana)
TER d.o.o., Topniška 27, Ljubljana
ASTROTAROT MAGIJA IZIDA – 090
54 50 – Vprašajte Zvezde ali Tarot! Razjasnitev življenskih situacij; zdravje, ljubezen, kariera, odnosi, dom, finance ... Če veste, ste v prednosti! 1,29 €/min. Vedeževanje in astrološko svetovanje!
Zelnik Suzana s.p.
POŠTENO, ISKRENO IN UGODNO vam svetuje Darja Gaja s pomočjo Ji džinga, ciganskih, Lenormand in Tarot kart. 040/271 835; marjetica.vedezevanje@gmail.com
Marjetica vedeževanje s.p., Drakovci 52, 9243 Mala Nedelja
SVETOVANJEVEDEŽEVANJE –
telefonsko ali osebno, 25 € do pol ure, 50 € 1 ura ... Ugodnejše kot številke 090! Info: 030/661 774 ali vita.svetovanje@gmail.com
Društvo Vita Pivka, Postojnska 12, 6257 Pivka
Enotna cena za mali oglas je 25 € z DDV do največ 30 besed. (Telefonska številka, e naslov ali spletna stran štejejo kot ena beseda). 10 % popusta za tri, 15 % popusta za več kot tri zaporedna naročila. Sprejem oglasa na info@misteriji.si ali na Misteriji, Cigaletova 5,1000 Ljubljana. Rok za sprejem je do 10. v mesecu za naslednji mesec. Informacije: 01/231 9360.
Za leto 2025 je že natisnjen slovenski tradicionalni koledar z domorodnimi vsebinami, ki so jim dodane prijetne barvne ilustracije in poučna besedila ter številčnice, kjer je dovolj prostora tudi za naše ročno pisane opomnike. Avtorica je Irena Petrič. Koledar »Drevesa v domorodnih izročilih« nam na kar se da poljuden način približa starodavna znanja prednikov na naših tleh in v zamejstvu; ta vedenja pa nam pridejo še kako prav tudi v dandanašnjem času.
V koledarju je dvanajst grafik, vezanih na dvanajst dreves in grmov, ki so za našo duhovno ljudsko zakladnico izjemnega obrednega pomena. Opisi vsebujejo informacije o obredih s temi drevesi in nekaj njihovih zdravilnih lastnosti, v številčnici pa so označeni prazniki, staroverski prazniki, opomniki za izobešanje zastave in lunine mene.

Nenavadno zanimiva pa so tudi besedila v koledarju: za prosinec TISA vodi v večnost, za svečan Vesnina čudodelna VRBA, za sušec Zdravilna NAGNOJEVA palica, za mali traven Z BRŠLJANOM v prebujeno pomlad, za veliki traven Čarovniški BEZEG in obredno vino, za rožnik PUŠPAN kot pomagalo ob prehodih, za mali srpan Preroštvo z LOVORJEM in miritev vodnega duha, za veliki srpan Pravljična BUKEV poišče moža, za kimavec Izvorna življenjska energija v JABLANI, za vinotok Privabljanje snubcev z GLOGOM in prehod v moško odraslost, za listopad Belistova BREZA in iskanje odgovorov ter za gruden Novo rojstvo z BRINOM. Nakup: Misteriji,si, 051/307 777. Cena: 19,90 €
Prva nagrada (letna naročnina na revijo Misteriji + Brezplačno svetovanje: Maručini kristali svetujejo, pokličite 040/600 487):
Petra Bor, Polica 47, 1290 Grosuplje
Druga nagrada (polletna naročnina na revijo Misteriji):
Tatjana Marucelj, Albrehtova 28, 1291 Škofljica
Tri tretje nagrade (knjiga založbe ARA):
Andreja Turk, Zabukovica 74, 3302 Griže Angela Petek, Krčevina pri Vurbergu 80a, 2250 Ptuj
Marija Krušič, Šercerjeva ulica 2b, 8281 Senovo
Nagrade bomo poslali po pošti.
Rešitev nagradne križanke št. 356: Vodoravno:
BREZIMEC, RETORIKA, AMAR, MUR, CIN, RIMA, ENOROKEC, BRGLEZ, NA, RAT, VIDAS, MULAR, OČI, OSANA, OZARA, PENINA, CES, JAKOV BRDAR, DESANT, AKA, IREC, SERVIRKA, AOJD, IMAN, SARD, LV, FN, OBOA, JUTRO, DIB, RIZMAN, LEVI, PARTE, ITO, MIRAGE, CALVIN, KERUB, ADORNO, KAKI, AVARI, POŠAST, ARAK. Nagradni pojmi: BRGLEZ
Rešitev s pripisom KRIŽANKA 357 pošljite do 15. novembra na naslov Misteriji, Cigaletova 5, 1000 Ljubljana, ali na e-naslov info@misteriji.si. Izžrebali bomo pet nagrajencev, ki jih čaka: 1. nagrada: letna naročnina na revijo Misteriji
2. nagrada: polletna naročnina na revijo Misteriji
3.-5. nagrada: knjiga ARA založbe
Ime in priimek:
Naslov:
Poštna številka in kraj

Avtor: Vladimir Milovanović, NAJETO PERO ROTOVŽ PREBIVALKA ASTRAHANA
TANKA KAMNITA PLOŠČA ZA POKRIVANJE STREH
ANGLEŠKI NOGOMET. (HARRY) ZELIŠČNI LIKER
KRVNO SORODSTVO
KOVINSKI SPOJ EMMA THOMPSON

VULKANSKO OTOČJE V INDIJSKEM OCEANU
SLEPILNA IGRA, SLEPARIJA
PTIČ PEVEC
MESTO V ZAHODNI NEMČIJI
JUNAK MAHABHARATE
OKRASNI KAMEN
HERB ALPERT
ČASOPISNI OGLAS
GOSLI, VIOLINA
FINSKI
ARHITEKT (ALVAR)
TOČKA ŽARČENJA
AM. IGRALEC MINEO
REKA V MONGOLIJI
REKA V SR. ANGLIJI
PEVKA RUPEL
FIN. PISAT. PAASILINNA
PODPORNIK UMETNOSTI UPANJE
KOVINA RAČUNALNIŠKI ZASLON
MISTERIJI BRAJDA, LATNIK, SENČNICA
VRTNA ROŽA, IRIS
STROKOVNA RAZPRAVA
PAZNIK, KI SKRBI ZA RED
NAŠA NESTRUPENA KAČA
SL. PESNIK (FRANCE)
SVIŠČ (REDKO)

DRŽAVA V BABILONIJI
GR. BOG. NESREČE
ITALIJANSKA IGRALKA DUSE
e-naslov:
SIMFONIJA NIKOLAJA RIMSKEGAKORSAKOVA
DROG NA VRHU VOZA
PESNIŠKO IME ZA IRSKO
TRUP
TUR. PISAT. (HALIDE)
HOKEJIST KOPITAR
INDIJSKI POLITIK GANDHI MESTO V JUŽNI BRAZILIJI IBSENOVA DRAMA IRIDIJ PARADNA SKUPINA JEZDECEV NAPADALEC NA ZNANO (POLITIČNO) OSEBO
OTOČJE PRI IRSKI
MESTO V FURLANIJI
NIZEK ŽENSKI GLAS PRIVRŽEN. NUDIZMA
VANJA EJDUS DAN. JEZIK. (RASMUS)
NEKDANJI ZLATNIK CIMA, POGANJEK
SOLMIZACIJSKI ZLOG SL. PISATELJ (JANI)
SILICIJ KDOR UDRIHA PO KOM
BILO SRCA SLIKAR DEBENJAK
GRŠKA ČRKA EVA BOTO
ROMUNSKI PISATELJ (PANAIT)
NELETEČA PTICA NA ANTARKTIKI
TONE NOVAK
PEVEC NABER
POL ČLOVEK POL STROJ
ČASOVNI ZAMIK
POMLADNA CVETICA ČINGIZ AJTMATOV
NAOČNIKI
MORSKI RAK BREZ KLEŠČ
ITALIJANSKA RODBINA IZDELOVALCEV GODAL
NEKDANJI SLOVENSKI KOLESAR (PRIMOŽ)
SL. SKLAD. (ALOJZIJ) MARKO ELSNER

VODNIK DO SKRIVNIH
PSIHIČNIH MOČI
S tem priročnikom vstopimo v vznemirljivi svet parapsiholoških pojavov, kot so telepatija, prekognicija, psihokineza, astralna potovanja … V knjigi so praktični napotki, kako razvijamo psihične moči, delujemo na daljavo .... 22,90 €

ENERGIJA KUNDALINI
Knjiga razkriva močne skrivnosti preoblikovanja energije. Kundalini mojstrica nas uči, kako okrepimo intuicijo, pustimo strahu oditi ter aktiviramo svojo moč za razsvetljenje, da izkusimo popolno srečo, ki spreminja življenje. 22,90 €

PRIROČNIK ZA ZDRAVO PREHRANJEVANJE
Katerim živilom naj se izogibamo in katera naj jemo, da zmanjšamo tveganje za raka; zakaj naj postanemo vegetarijanci; program za vitkost za vse življenje ... 24,90 €

NAČRT DUŠE
Ima naše trpljenje sploh kak smisel? Knjiga nam odkriva pravi pomen življenja, katerega kot duša sami načrtujemo pred svojim rojstvom – v življenju pa načrtovane izzive zavestno uporabimo za svojo duhovno rast in zdravljenje. 24,90 €

DOKAZI O NEZEMLJANIH V knjigi je izčrpen opis vseh pomembnih opažanj NLPjev, dokazov, da Nezemljani obstajajo, da obiskujejo naš planet in da so v vseh pogledih resnično naprednejši od nas. 24,90 €

ZAKAJ SE RODIMO
IN ZAKAJ UMREMO
Je rojstvo stvar usode? Zakaj se človek rodi, če na koncu umre? V knjigi se avtor, hipnoterapevt in jasnovidec, ukvarja z vprašanji, kaj, kdo, zakaj, od kod, smisel vsega … 14,90 €

PREKINITVENI POST
Človek je bolj prilagojen za občasno pomanjkanje kot za stalno hranjenje. Če uživamo hrano samo v »oknu« petih do osmih ur, jo lahko telo dobro prebavi, vsrka hranila in izloči odpadne snovi. 19,90 € 17,91 €

MODROST DUŠ
Zgodbe ljudi, ki so jim hipnoterapije Življenje med življenji pomagale razrešiti družinske spore, se spoprijeti z zdravstvenimi težavami, izboljšati ljubezenska razmerja, napredovati na poklicni poti, premagati depresijo … 24,90 €

KAKO MI LAHKO POMAGA CBD
Ta preprosti vodnik – pripravila ga je zdravnica, ki je vrsto let proučevala vse o konoplji – opisuje delovanje CBD v telesu, zakaj ima toliko različnih učinkov in najboljši način njegove uporabe 9,90 €

ŽIVLJENJSKI SLOG, KI RAZVELJAVI BOLEZNI
Preprost, a radikalen program zdravljenja z življenjskim slogom, opisan v knjigi, pogosto ustavi napredovanje najpogostejših kroničnih bolezni ali jih pomaga preprečevati. Ter upočasni škodo zaradi staranja na celični ravni 24,90 € 18,67 €

VZEMITE ZDRAVJE
V SVOJE ROKE
Avtorica je odkrila, da industrija hrane in zdravil obvladuje zdravje in zdravljenje v luči svojega pohlepa. Zato spodbuja odgovornost do samega sebe in nam pove, kako lahko mnoge bolezni pozdravimo brez zdravil. 24,90 €

KAKO ZNIŽATI VISOK
KRVNI TLAK BREZ ZDRAVIL
Visok krvni tlak škoduje zdravju in krajša življenjsko dobo. Z načinom življenja, temelječem na gibanju in zdravem prehranjevanju, lahko visok krvni tlak za vedno znižamo tudi brez vsakodnevnega jemanja zdravil. 24,90 €
Izbrane knjige naročimo po telefonu (med 8. in 15. uro): 01/549 17 92 ali 051/307 777; e-pošti: info@misteriji.si ali na spletni strani www.misteriji.si








Ko zvemo, da smo sladkorni bolnik, ali pa pljučni, srčni …, se v nas nekaj premakne. »Kaj pa zdaj?« je vprašanje, ki se porodi večini, ki hoče, da jim bo čim prej bolje. Najbližja pot do odgovora je spoznanje, kaj lahko naredimo sami! Knjižice, ki nas poučijo o tem, so na voljo v elektronski obliki v spletni trgovini ARA založbe Misteriji.si.
Knjižice lahko berete na svojem računalniku ali pa si jih v nekaj minutah natisnete.
Na voljo je petnajst knjižic o tem, kako ne umreti od srčnih bolezni, pljučnih bolezni, možganskih bolezni, bolezni jeter, bolezni ledvic, raka prebavil, raka dojk, raka prostate, krvnih rakov, Parkinsonove bolezni, infekcij, diabetesa, visokega krvnega tlaka, samomorilne depresije in zdravniških napak.
Cena posamezne knjižice: 4,90 € Naročila: Misteriji.si


knjige našega avtorja meseca novemBra, meseca

Boja proti raku prostate in mod, iZdane v ara ZaloŽBi: pot do Živahne moškosti
cena: 14,90 €, ZniŽana 7,45 €
kaj pa neZemljani? – naši koZmični Bratje in sestre cena: 27,50 €, ZniŽana 24,75 €
slovenska pot v prihodnost – viZija raZvoja slovenije cena: 11,90 €, ZniŽana 5,95 €
Zoran ŽeleZnikar (tudi pod psevdonimom Branko kremenšek) piše poljudne knjige, ki Bralca spodBujajo k proučevanju človeka, njegove Zavesti in vesolja. govori tudi o pomemBnih druŽBenih vprašanjih ter vlogi neZemeljskih civiliZacij v človeški Zgodovini. navaja nas, da raZmislimo o svojem mestu v svetu in o tem, kako lahko prispevamo k poZitivnim sprememBam v druŽBi. njegovo sporočilo se poveZuje tudi Z njegovimi pogloBljenimi raZiskavami o človekovi duhovnosti in raZvoju. vse knjige lahko naročite na misteriji.si ali 051/307 777.
